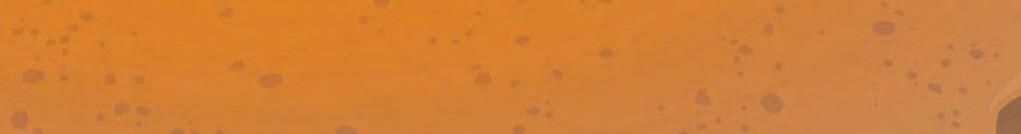

While the next state election is still two years away,the latest Resolve poll has revealed Traralgon local

By KIANA BROOKS-AMOR*
ASSISTANT Minister for Trade and aFuture Made in Australia, Senator Tim Ayres was in Morwelllastweek.
Mr Ay res met wi th lo ca l manufacturers, holdingroundtable discussions about currentand future growth plans.
The New So uth Wal es- base d Senator saidhewas pleasedwith the projects Gippsland industries can contribute to the Future Made in Australia initiative.
“The biggest opportunity in front of theGippsland community is the opportunity that’s posed by offshore wind projects,” he said.
“I wanttomakesure thatwhere there’s wind projects and transmissionprojects,that (iswhere)we’re getting the maximum local content over the coming years.”
The Future Made in Australia is a federal government plan investing $22.7 billion intoenergy, metal, tech nolog y, and manufact uring innovations and investmen ts in









Australia. Mr Ayres said that the plan will secure Australia’s supply chain and “seize” economic opportunities across the country.
While in Morwell, Mr Ayres spoke with local engineering industries, energy investors, localgovernment, tradeunions, and other bodies about how to take advantage of Gippsland’s “great industrial capability” and local innovations.
He said investing in wind energy projectsand other innovationswill not only improve industrial capabilities,but will also bring more jobs to the Latrobe Valley and other areas of Gippsland.
“We’re absolutelycommittedto… makingsurewesqueeze every last job out of it (the plan),” he said.
Federal Member for Gippsland, Darr en Ches ter howe ver wa s criticalofthe plan, saying it burdens inflation
“Ironically, the Future Made in Australia policy is looking more like Australian taxpayers copping the bill to build up big foreign companies,
with a$1billiondeal with aUS company,PsiQuantum, at the centre of the plan,” he said.
“Future Made in Australiaisa demonstratio no fL abor’s wrong priorities in acost-of-living crisis.”
Mr Chester is amember of the House of Representatives Select Committee investigating nuclear energy potential.
“Australians are more open-minded aboutthis debate than the LaborGreens, whoare focussed on running ascare campaign,” he said.
Both the Committee and Future Made in Australia are interested in submarines for Australia.
Mr Chester said: “(The Committee is) hearing evidence from around the country aboutthe potential to develop acivilian nuclear capacity on top of the AUKUS submarines agreement”.
Mr Ayres said: “We (the Future Made in Australia)are for local manufacturing. We’re for local naval ship building. We’re for building ourfuture submarine fleet here in Australia.”
The Future Made in Australia
pla ns upp or ts the New Ene rg y Apprenticeships Program, which increa ses eligibil ity for $10, 000 incentive payments.
Mr Ayres said that fee-free TAFE courses aim to keep costs down for apprentices.
Last September, the state government said it had offered more than 80 free TAFE courses.
Mr Ayre sb el ieved busines ses should employ several apprentices.
“One of the things that I’m interested in, (in) the context of aFuture Made in Australia, (is) how we could further support more accountability amongst companies about their effort in terms of apprenticeships,” he said.
Southerly Ten’s Regio nal Engagement Senior Manager, Paul Johnson, said that the federal plan is “exciting” for Star of the South. Star of the South is alocal offshore wind project set for completion by 2030.
*Kiana Brooks-Amor is auniversity studentcompleting placementwith the Express.









By BLAKE METCALF-HOLT AND TOMHAYES
APERSON was struckbyaV/Linetrain in Morwell at the railway line parallelto Mid Valley Shopping Centre last Thursday (November 14).
Police arrived on the scene around 10.30am and found abody near the halted train. Passengers remained aboard until it was deemed safe to exit, requiring ladder usage. At least one person in awheelchair was also on board the service.
SES services arrived after 12pm, with the Coroner arriving soon after.
V/Line officials were also seen at the area of the incident.
The V/Line service had last stopped at Traralgon Railway Station and was to arrive into Morwell Railway Station at 10.35am.
Replacement buses and taxi services were called to the area for passengers to utilise.
Once the incidentwas cleared up, trains resumed along the line from around 2pm.
THREE people died in acrash involving an amateur-built light aircraft in Tinamba West on Saturday (November 16).
It was reported that emergency services were called to reports of the crash in apaddocknearHeyfield-Upper Maffra Road at about 5.45pm.
It was reported to the police that the plane had circled the area before the incident.
In the fatal crash was a20-year-old pilot from Tongala, and two passengersaged 16 (Tongala) and 15-years-old (Tinamba West), the ABC reported. They were the only three people on board.
The Australian TransportSafetyBureau (ATSB)has commenced atransport safety investigation into the incident.
The ATSB is deploying to the site ateam of transport safetyinvestigators from its Canberraoffice,specialising in aircraft operations and maintenance.
Investigators will conduct ar ange of evidence-gathering activities on site, including wreckage examination and recoveryof any relevant aircraft components for further examination.
Investigators willalsoseek to speak to any witnessestocollect relevantinformation, includingflight trackingdata, pilotand aircraft maintenance records, and weather information.
The ATSB urges anyone who may have witnessed the event, or has photos or video footage of the aircraft at any point of the flight to fill out awitness form at: atsb.gov. au/witness
The ATSB is to publish apreliminary report to include allinformationcollectedinthe evidence-gathering phase, in aboutsix to eight weeks.

Incident: This carwas foundcrashed intothe front of the Morwell Australia Post Business CentreonBridleRoad on Saturday, November 9. Photograph supplied
By TOMHAYES
LATROBE has been discovered to be the second worst local government area (LGA) for crime per population across Victoria’s 79 LGAs, astudy from criminal lawyers Astor Legal has found.
Research spanning from July2023toJune 2024 found Latrobe to have the second-worst incident rate per 100,000 people with 11,579, despite having the 18th mostincidents across the statewith 9098.
The only LGA with ahigher crime rate per 100,000 people is Melbourne, which is substantially higher with 15,115 incidents per 100,000.
In surrounding regions, East Gippsland had the 13th worst crime rate, followed by Wellington (20th), Baw Baw (35th), BassCoast (39th), and South Gippsland (42nd).
Astor Legal found that theft was easily the most common crime, making up 38 per cent of Victoria’s crimes. Making up the brunt of other incidents were breach of orders (12 per cent), assault/or related (11), burglary or breaking and entering (nine), and property damage (nine).The remaining 20 per cent of crimes included drug use/possession, weapons/ explosive offences, sexual offences, deception, and other crimes.
However, in Latrobe that trend didn’t translate, withthe state’s secondmostcommon crime,breach of orders,the mostcommon. Specifically in Latrobe, the most commoncrime was family violence order breaches, with 1025.
Family violence order breaches was also the most common crime across East Gippsland (582 incidents), Baw Baw (472), Wellington (456), and Bass Coast (282), as well as 14 other LGAs.
Making up the topfive most popular incidents in Latrobe includes, criminal damage (783incidents), bail breaches (717), stealing from amotor vehicle (671), and other theft (602).
Of the 27,042 family violence order breaches across the state, Latrobe rankshighestwith 1305 per 100,000people.
The regionalsoranks worst for the state’s16,864 bail breaches with 913 per 100,000 people,and the state’s 13,800 family violence/common assault incidents with 589 per 100,000 people.
Contributing to some of the region’s most commoncrimes, breaches of orders is up 17.6 per cent across the state since 2019, while in the same period, assault is up 8.3 per cent.
ABOOK has been released about the High Country deathsofRussell Hill and Carol Clay
Since1917, five otherpeople have also disappeared, three of them never found, the reasons for their disappearances still unknown.
The manager of Victoria’smost secure prison; amillionaire racingcar driver, an experienced bushwalkerand then, Russell Hilland Carol Clay, clandestine lovers whosesecretcamping weekend becamenational headlines.
For nearly two yearsitseemed they would join the otherswho had disappeared, but then -the arrest of amost unlikely suspect, experienced Jetstar pilot Greg Lynn.
True crime author Robin Bowles has visited the scenesofthe crime, spokenwith witnesses and locals notpreviously contacted, conducted frank interviews with police and attended every day of an action-filled six-week murder trial in the Supreme Court
Using her forensic research skills, Robin Bowles has written Last Man Standing,a thrilling exposé of murder and mystery in the Wonnangatta Valley,
aplace holdingsecrets forover100 years.
Ms Bowles will be appearing at the Bairnsdale Library this Saturday (November 23), from 6.30pm, discussingher book and case.
For more information, phone the Bairnsdale Library on 5152 4225
The following day she will be hosting an afternoon tea at the DargoHotel from 2.30pm. For more information, phone the hotel on 5140 1231.
Footnote: ExpressEditor, Liam Durkin is currently reading this book. Having coveredand followed the case closely from the start, Iam hopingitwill provide some closure to the story.
Iwas at the very first pressconference outside Sale PoliceStationwhennewsoftwo missing camperscame to hand in March 2020. Even then,the feeling amongjournalists wasthat 'something doesn't adduphere'. Little were we to know what was to unfold over the next fouryears.Coincidently, that was the last press conferenceIattendedbefore the state was plunged intolockdown.


By TOMHAYES
FERAL cats in Moe have raised community concerns after domesticating themselves at avacant property on Evelyn Street.
The Express was told by aMoe resident that they had witnessed 12 to 13 feral cats occupying the currently vacant house. The resident contacted Latrobe City Council and the RSPCA.
“Latrobe City Council is working with neighbours of avacant property in Moe to supportthe safe retrieval of anumberofunownedcats, whichwere being fed by the previous owner,” aLatrobe City Council spokesperson said.
Multiple neighbours, either next door or across the road, have agreed to set up traps.
Neighbours have heard the cats within the roof of the vacant houseand are reportedly continually breeding. None of the catsare knowntobedesexed or wormed/immunised.
The RSPCA told the Express they have been alerted to the issue and are investigating.
“Wecan confirmRSPCA Victoria’s Inspectorate hasreceived acruelty report regarding this matter, however as it’s under investigation, we’re unable to provideany further details,” an RSPCA spokesperson said.
The Moe resident who alerted the Express wants this incident to class as awarningtoall pet owners, especially those of cats, to desex your animals if they are to roam freely, as well as worming them and immunising them.
Council’s Cat Curfew applies from 9pm to 6am seven days aw eek, mean ing all cat s must be secure on their owner’s property, or indoors during these hours.
So far, four cats have been trapped and handed to council.
Stray: Neighbourshavebeen feeding the cats in the driveway so theyaren’tlefttostarve.
Photograph: TomHayes
Bound: Abook detailing ‘Missing Campers Case’has penned. supplied



























































































































































FEDERAL Memberfor Gippsland, Darren Chester has announced the 2025 #lovegippsland calendar competition winners.
"After much deliberation and scouring through hundreds of high-calibre entries,the three winners of my 2025calendarcompetition have been chosen, and their images areexceptional," Mr Chester said.
"The winning images include an electrical storm passing over the Port of Sale, captured by Grant McKillop, acrested tern flying over Lake Tyers beach, photographed by Sue Allison, and avery cute,curious echidnapeeping out from atree stump taken by Jessica Owen.
Mr Chester said there was about 300 photo entries for the 2025 #lovegippsland calendar.
"This year's theme 'Love Where We Live', highlights the incredible beauty and diversity of our region with the 13 images chosen to feature in the calendar showcasing many beautiful places throughout the region,magnificentscenery, native wildlife and iconic Gippsland structures,"Mr Chester said.
Freecopies of the 2025#lovegippslandcalendar are available from Mr Chester's electorate offices in Sale and Traralgon.
"We will also be distributingthe calendars throughoutGippslandtogeneral stores, golf clubs,


bowls clubs,opshops, and anywherewecan think of," Mr Chester said.
Businesses and community organisations can request abox of calendars through Mr Chester’s office by calling 1300 131 785, or emailing darren. chester.mp@aph.gov.au
By TOMHAYES
THE Hazelwood Road and Jeeralang North Road intersection located in Hazelwood North, between Churchill and Traralgon is receiving an upgrade.
The intersection has ahigh crash history, with threecrashes; tworesulting in serious injury, and oneresulting in death between 2016 and 2021. Speed was acontributing factor to those crashes, as Transport Victoria conducts aspeed review of the intersection, and will advise of any changes.
The $2.7 millionprojectisfunded by thestate and federal governments under the Road Safety Program.
To reduce vehicle speedand improve safety, raised safety platforms are set to be installed on the leftslip lane on HazelwoodRdonthe approach to the intersection from Jeeralang North Rd. Raisedsafetyplatforms are similar to speed humps,but are longer, lower, and smoother,



preventing drivers from braking and accelerating hard as they approach the exit.
They are designed to slow drivers down as they passcertain sections of the road, or entering intersections in this instance.
In total, the upgrade includes: Two raised safety platforms; Concrete centre median and left turn lane separator onto Jeeralang North Rd; Improved sightlines for vehicles turning onto Hazelwood Rd; Improved alignment of left turn slip lanes; Improved road surface and line marking, and; Upgraded lighting.
Pre-construction works are being finalised with works expected to begin in early 2025.
For more inform ation about thi sp rojec t, call 13 37 78, or em ail gippslandprojects@transport.vic.gov.au





























































































BY DANCAFFREY
NINE years ago, the ACT decided to go 100 per cent renewable electricity and signed contracts with several wind farms in South Australia and some in Victoria and NSW.
Together with input from local solar farms, Canberrans were able to claim that their electricity was fossil-fuel-free by 2021.
Before then, they had the most expensive electricity in Australia.
They now enjoy rates that are comparable with the other states.
What is even more noteworthy is that the price of the earlyPower PurchaseAgreements (PPAs) went from around nine cents akWh back in 201617, to 4.5 cents/kWh for aPPA signed this year.
The cost of wind generationhas basically halved in the last eight years.
Coalgeneration needs well above 10 cents/ kWh to be profitable, which is twice the price of wind power.
The happything for Canberrans is thatany new PPA with awind farm will mean even cheaper electricity going forward.Yet the federal Coalition as reported in The Age (30/9/24 and againon 29/10/24)isspruiking asource of generation that costs at least 18 cents/kWh.
Nuclear electricity is thus almost fourtimes higher than for the wind power that generates Canberra’s electricity supply.
If Australia is to rely on such an expensive energy source as Peter Dutton would like, then would that not put our economy at adisadvantage

Comparable: Renewableenergyhas proven to be amoneysaver in Canberra. Photo: File
and scare investors away and drive industry off-shore?
As well, because it would be taxpayer-funded and not be exposed to the volatility of financing that private investment has to endure, would this not deterinvestment in large scale solar and wind farms and put at risk the $50 billion of investment in the off-shore wind industry in Gippsland?
It would be good for us constituents in LNP electorates like ours to ask our MHRs why they are willingtocommitour nation to economic suicide by wanting nuclear power and what would they prefer -nuclear or offshore wind?
We can’t have both. Ask them also, what is therealreasonthey want to go nuclear, especially bearing in mind thatprobably everyparliamentarian in office now will have retired (or died) by the time the first nuclear power plant gets built.
Dan Caffrey is President of Latrobe Valley Sustainability Group.
Letters,Opinion -Page16
LATROBE CityCouncil endorsed the 2023/24 Annual Report at acouncil meeting in October, reflecting on the achievements over the past financial year.
The Annual Report provides atransparent overview of council operationsfor the Latrobe City community and stakeholders.
Throughout the yea r, co unci ls uc ce ssf ul ly completed important projectssuchasStage 2 of the Moe Revitalisation Project, Kernot Hall Redevelopment and work commenced to provide more car parks at the Seymour Street multilevel car park in Traralgon.
Latrobe CityCouncil ChiefExecutive,Steven Piasentesaidcouncil is proudtocontinually provide avast range of community initiatives across many services.
“It is with great pride Ipresent the AnnualReport for 2023/2024 on behalf of Latrobe City Council. The past year hasbeen marked by significant growth and achievements,settingthe stagefor continued service to our community and creating positive change in Latrobe City,” he said.
"The Annual Report also includes our independently auditedfinancial statements that clearly identifies that council remainsfinancially sustainable, with astrong balance sheetand amodest level of borrowings.
“Together we have worked to accommodate the growth of our city through many projects, initiatives and engagement opportunities -both led by council and by the community.
“As we reflect on the year that’s been, we’re also full of enthusiasm for the challenges and new growth that lay ahead. We stand committed and strong for our community to continue shaping our shared future,while remaining accountable for decision making.”
TheAnnualReport canbeviewed on council’s website.
ELSEWHERE, the financial and performance outcomes from the 2023/24 State Budget are the focus of public hearings this week.
The Public Accounts and Estimates Committee hearing started Monday (November 18), and will run until Friday, November 22.
The secretariesofvarious governmentdepartments, the chief executive of CourtServices Victoria and representatives from parliament are scheduled to appear at the hearings held throughout the week.
Stategovernment spending reached $97.3billion last financial year.
The full schedule of public hearings is available on the Committee’s website.


































ABUFFER to separate freeway traffic from a service laneisamong the keyactions identified in adraft Trafalgar Structure Plan.
Once final ised, the plan -w hi ch pr edic ts Trafalgar’s population will increase by 46 per cent in the next 20 years -willhelp guide Baw Baw
Shire Council priority projects, advocacy, budgeting and planning scheme amendments.
Consultation opened last week, allowing residents six weeks to read the long-term document and have their say on findings and actions recommended.
Feedback closes on Sunday, December 8.
Creat ion of hig hwa ye ntra nc eg at ewa ys, enhanced entrances to the town centre, widening of key roads and improved intersections are priorities identified.
Cons trai nts facing Trafalg ar inclu ded the highway and railway corridor dividing the town, flood risk, large unoccupied sites within the town and limited school expansion options.
The draft plan, inspired by findings from Tract Consultants and witha $100,000 budget,identified six key directions:
Reinforcing Trafalgar’s country town character;
Providing sustainable residential growth and housing choice;
Supporting resilient local and sub-regional economy;
Improving access and connectivity;
Enhancing open spaces and natural environment, and;
Creating apeople-focused heart.
The heartrelatestorecognising the importance of the towncentre,trainstation precinctand Princes Highway as places where the community comes together as well as their critical role in strengthening tourism and visitation.
Atrain station forecourt with shelters and bus parking, aseparator between west bound traffic and service lane and ashared pedestrian/vehicle space in Contingent Street is detailed, including an artist impression.
The section, “Re-imagine the Princes Hwy”, said the major road presents a“significantmovement barrierbetween the towncentre,the train station and areas to the north of the township”.
“The lack of separation between the highway and businesses on the south side impacts of amenity andthe pedestrian experience,” the report stated.
Aseparated slip lane is proposed on the south side of thefreeway to simplify vehicle movements and improve pedestrian safety.
While the slip lane willaccessContingent Sreet, it is proposed freeway traffic would be restricted from turning onto Contingent St. Traffic would be redirected to Anzac Road and McCrorey Sreet to access the town centre.
The draft plan details Trafalgar’s population and growth predictions.
Latest figures in 2021 showedthe town had a population of 3839 with amedian age of 41 years, 1637 houses and $373.2 million economic output.
Trafalgar’s 1065 jobs were led by theeducation, health and construction sectors.
However,inthe next 20 years -by2043-itis forecast Trafalgarwill gain 1774 residents, 1000 houses, 18 hectares of industrial land, 900 to 1200 square metres of non-retail employment floor space, and 2200 to 3900 square metres of retail floor space.
Former Baw Baw Shire East Ward councillor and long-time Trafalgar resident, Darren Wallace described it as a“solid plan with some key recommendations” but was keen to hearcommunity thoughts.
Mr Wallace (who was asitting councillor until losing at the most recent election) said retaining the town’scountry feel was vital, and major issues ahead included drainageand flooding, land buffers around the abattoir and landfill sites, and ad-hoc commercial development as previously seen in Yarragon.
“The Trafalgar commercial district won’t thrive until the highway is separated from it, much like Yarragon,” he declared.
“It’s apity it wasn’t done 30 years ago... it’s not to say it can’t be done.”
Disagreeing with one aspectofthe draft plan,Mr Wallace called for widening and sealing of Sunny Creek Connection Roadtoopen heavyvehicle access to the abattoir, as well as re-opening of the railway level crossing at Sunny Creek Road to give freeway traffic access to the industrial area and recreation reserve.
Looking ahead 20 to 30 years, he envisioned elevating the railway station and lines to open the township, much like had recently been unveiled in Pakenham.
“If we had askyrail from the west boundary to the east boundary of Trafalgar, imagine the improved connectivity,” Mr Wallace said.
“Nothing is impossible if you advocate long and hard enough.”
Community information sessions wereheld at the TrafalgarFarmersMarketonSaturday, November 2, and Trafalgar Community CentrelastThursday (November 14) and Friday (November 15).
To view the draft plan or pro vide feedba ck onl ine ,v isi t: ba wba wcon
MORE than 200 Traralgon blood donors are still needed to give blood in the next fortnight to boost blood stocks for patients in need.
Australian Red Cross Lifeblood’sTraralgon Donor Centre is one of Victoria’s most poorly booked centres this November.
Lifebloodspokesperson EmilyGranland said with demand for blood and blood products at its highest in adecade, it was crucial appointments at the donorcentrewere 100 per centbooked everyweek
“Every week in Australia we need 33,000 people to donate bloodand plasma to ensure we’reable to fill hospital ordersand keep our fridges well stocked for thosepatients that rely on lifegiving donations,” Ms Granland said.
“If you are feeling healthy and well, Iencourage you to step up and fill those appointments, if you can, because the need for blood does not stop.
“Weknow the peopleofTraralgon are incredibly generous, but right now appointments are too low, and we need them to make donations aregular habit and keep our donation chairs full.


“If you’ve given blood before, be alocal legend and spreadthe word with your friends, family, and neighbours abouthow they can help to make a difference. We love to see our regular donors come back and are always excited to welcome first-timers as well!”
Blood donation takes around an hour, while plasma donation takes about an hour-and-a-half. Each donation can save up to three lives.
Cancer treatment, emergency surgery, road traumaand bleeding during childbirth are some of the most common uses for donated blood in Australia.
The Traralgon Donor Centre is located at 20 Seymour Street.
Opening hours are 11.30amto7pm Monday and Tuesday; 7am to 7pmWednesday; 9amto6pm Thursday and 7am to 2.30pm Friday and Saturday.
If you would like to know more about donating blood visit: lifeblood.com.au
To book adonation, call 13 14 95, or book online at: lifeblood.com.au or on the DonateBlood app.





Helping hand: Locals arebeing asked to give blood, afteritwas revealed the Traralgon centre had one of thelowest number of bookings in the statethismonth. Photograph supplied



By TOMHAYES
ACHURCHILL local has raised concerns after he was told that rooming houses were being developed on the quiet street he lives on.
After his curiosity piqued, 75-year-oldPeter Mortimer went to takeacloser look at the development, currently under construction, noticing an abundance of piping being laid as far back as six months ago.
Upon asking alocal plumber, who also lives in close proximity, Mr Mortimer was told that that amount of plumbing and the slope in the flooring was common for share house-type dwellings.
When coming across the surveyor of the development, Mr Mortimer’s suspicions were confirmed when he was told that the dwellingswere rooming houses.
Not once had any residents of Emerald Court received any formal notice of this dwelling being developedaccording to Mr Mortimer,whichhe believes they should’ve been for adevelopment of this capacity.
Also, throughoutthe development, Mr Mortimer has not once seen anyone appraise the area for this type of development, which he believed should be necessary.
Speaking to the Express,MrMortimershared his concerns on what arooming house could do to the quiet street of Emerald Court, Churchill.
“My number one concern is the parking of each resident, each (existing) resident (of Emerald Court) has approximately two cars with enough room for them to park their cars off the road,” Mr Mortimer said.
“Number two is who will maintain the property to an acceptable standard, and not leave the grass to grow out?
“Willthere be abody that’s responsiblefor the
behaviour of the boarders, or will they just be left to run amok?
“Does the company have astandard application for the tenants that they are excepted to be of proper behaviour and respect their neighbour’s privacy, and can (the EmeraldCourt residents) have acopy?”
Amongthose concerns listed above, Mr Mortimer was surprised by the fact there was no notice of any kind, which he thought would’ve been necessary. The uncertainty of knowing what kind of residents will be moving in on Emerald Court also doesn’t sit well with Mr Mortimer and his wife Robyn, who moved to the quiet street to downsize.
Whenasked on what he would thinkifthere were no legal issues with the development, Mr Mortimer
said: “What can Ido? Ijust want an answer as to why we weren’t informed beforehand”.
“Theyshouldn’t be allowedtogoaheadand do thesethings in what is aquiet court,” he added.
LatrobeCity Councilconfirmed to the Express that abuilding permitwas lodged, and aplanning permit is notrequired for the development.
“Based on our records abuilding permit has been lodged by aprivate building surveyor and the premises wouldalsorequiretoberegistered withcouncil under the Public Health &Wellbeing Act 2008 before they could commence operation,” acouncil spokesperson said.
“The house would alsorequire registration with Consumer Affairs Vicasa rooming house.
“A planning permit is not required under the

state planning provisions for arooming house in aresidential zone when anumberofrequirements are met.”
Those requirements include:
The total floor area of all buildings on the land, measured from the outside of external walls or the centre of party walls, does not exceed 300 square metres, excluding outbuildings;
No more than 12 persons are accommodated, and;
No more than nine bedrooms are provided.
With the two dwellings across the two lots under construction, Mr Mortimer still fears that according to those provisions above,amaximum of 24 people could potentially be added to Emerald Court.
Mr Mortimer and his 76-year-oldwife, Robyn moved to Emerald Court in April 2022, downsizing from their one-acre block on the other side of town -their home of 32 years.
Prior to moving to the region, Mr Mortimer had lived his whole life in Melbourne. He and his wife were the first homeowners on Emerald Court.
The developer, Stone Horizon, as well as the listedcontact were contactedfor comment, but did not respond.
According to the StoneHorizon website, they “help new and experienced investorsinvest in properly wisely”.
Their website also states: “We design, build, and manage positive cash flow properties for the investor”.
The Stone Horizon headofficeislocated in Scoresby,south-eastofMelbourne, northof Dandenong.






















By LIAM DURKIN
WHAT adifference afew weeks can make.
Traralgon could be home to the next Victorian Premier, with latestpollnumbers indicating Liberal leader John Pesutto has edged ahead of incumbent Jacinta Allan for the first time.
In figures released by the Resolve Political Monitor, Mr Pesutto holds an ever-so-slight lead over Ms Allan by one per cent in the preferred Premier stakes.
The opposition leader wasaheadon30per cent to Ms Allan’s 29 when the Express wenttopress on Monday afternoon.
Speaking exclusively with the Express,Mr Pesutto said he wasn’ttakinganything for granted.
“I’m very conscious that my colleagues and Iwill continue and need to continue to work very hard to earn the trust and confidence of the Victorian people,” he said.
“Polls will come and go and there’s along way to the next election, but we’re focussed on Victorian households and businesses who are doing it tough under Labor’s cost-of-living crisis.
“As the alternative Premier, Ihave aresponsibility to hold the government to account but also to outline our positive vision for our state’s future.
“Victorians are clearly fed up with adecade of Labor government that has seen record debt, over$40 billion wasted on cost blowouts on major projects, falling education and health outcomes, and crumbling roads.”
Granted poll numbers can be largely fabricated, the Resolve Political Monitor is used monthly on behalf of The Sydney Morning Herald and The Age,two mastheads generally consideredtobe the epitome of reasonable and accurate analysis
Theresult comes just weeks after Mr Pesutto’s leadership came under fire, as his defamation case against former LiberalcolleagueMoira Deeming dragged on.
Mr Pesutto hadfaced apotential leadership spill, but emerged relatively unscathed.
Withthe next state election not due until November 2026, neither party leader appears to have too much cause for concern or optimism this far out.
Ms Allan quickly deflected the subject when asked by reporters in Melbourne last week, while closertohome, Memberfor Eastern Victoria and Labor Minister Harriet Shing did not wish to comment when asked by the Express.
The Coalition would need to defy recenthistory if it is to win the next election, having been absolutely annihilated by former Premier Daniel Andrewsthe last three times Victorians casttheir vote.
However, with Mr Andrews now out of the picture following his unexpected resignation last year, the Liberals could see aclearer path to government.
Mr Pesuttowas born in Traralgon and attended school at Lavalla CatholicCollege.Healso played soccer for Olympians and Traralgon City in his younger days.
He admitted ‘future Premier’ was not ajob spoken about in his careers class.
“Whilst admittedly Iwas not the best-behaved student for much of adolescence (having way too much fun), Idid get serious about my studies in years 11 and 12,” he said.
“By that stageIwas increasinglypassionate aboutpublic service andthe responsibilities that go with it, and Iwas ably encouraged by my teachers to pursue that course.”
Regardless of how the next state election goes, Mr Pesutto may wish to take advice from one of the great Traralgon events -the race to Spring Street is amarathon, nota sprint.







































ONE POINTERS


1. True or false: aporcupine is arodent?
2. Amerino is atype of what animal?
3. Which name was given to the kings of ancient Egypt?
4. What is amale camel called? TWOPOINTERS
5. Which countr yconsumes the most coal?
6. Which continent has no permanent human population?
7. What does an altimeter measure?
8. Who wrote “The Jungle Book”? THREE POINTER
9. How many members are in The Pet Shop Boys?
10. What countr yinvented ice cream?
11. What countr yissoft drink Irn-Bru from?
12. What is the most popular non-alcoholic drink in the world?
FOUR POINTER
13. Which Australian PM changed the gun laws in 1996?
14. What colour are sunsets on Mars? FIVE POINTER
15. Name the top 5most spoken languages in the world, one point for each correct answer
Howdid youfare?
page55



























By BLAKE METCALF-HOLT
LOCAL motorcycle club, Us &Them Tourers carried out another successful initiative, donating to Carry On Café, Morwell.
More than $1000 was donatedtothe veteran support business. Also operating as asupporting servicefor the localfood bank, the proceedswill help provide more free meals to both regular veterans that visit and those that come through every now and again.
Café Manager, Kerry Hamley was thankful for the motorcycle club’s now yearly contribution.
“The donations are amazing, that helps along way with food,” she said.
“Weprobablygiveaway maybe15-20 mealsto people each week andifwecan branch that out even further we would like to do that.”
Us &Them Tourers Social Motorcycle Club hold an annual poker run rafflethe weekend before Melbourne Cup, which again saw people dig deep knowing where the money was going to.
Club president Dave Watts said club members came from across Victoria, and even interstate.
“We have our local businesses that support us, they support us so that we can support them (Carry On Café),” he said.
“If it wasn’t for them and if it wasn’tfor the biking community too, we wouldn’t be able to do this, but we do this becauseit’slocal and that’s our number onething.
“Our local communities are suffering so, (we’re) pretty passionate about it.
“This is somethingthat brings us all together which is good.”
Local veteran Adrian Morley said the café offers genuine service which comes from staff trulycaring for the wellbeing of people.
“Normally whenyou go somewhere it’s very official and bureaucratic and that sort of thing, but this is just informal which makes it alot easier (if you’re) just walking off the street… it’s just an easyway forpeopletofeel comfortable going in and sit down and have acup of coffee,” he said.
Ms Hamley said the staff form strong relationships with the local veterans and regularly check in on them.
“You can tell that they need ahand so, we’ll come out and say ‘hey, what do you need help with?’ because aveteran won’t ask for help, they never ask for help and that’s the big thing Ifound working

here as the manager is that you’ve got to be that one step ahead and look for signs that somebody’s doing it tough,” she said.
“Friendshipshave been formed here too. There’s been veterans that have come in and they haven’t had alot of family support or they don’t have a family and the café has sort of become that family to them.
“We have aveteran that comes in every single day and hasa coffee andthat’stheir timeout every day.”
Carry On Cafe also has avolunteer base which is there to support veterans, as well as awelfare team for veterans to go to in times of help.
Mr Watts, whohas been withthe motorcycle club on and off since 1996, said the club was aplace for people to find themselves from all walks of life.
“We’ve been around for along time, not alot of people know about us,” he said.
“We’ve got ourown veteransinthe club ourselves, we’ve got disabled people in the club, old people, young people, awide variety of bikies,wedon’t discriminate against anyone.
“It’s just something where we all want to find each other really, it’s just somewhere we go, some people don’thave bikes, they just come in the morning and have acoffee and go depending on where they’re at (during) life.”

THEAlcohol andDrugFoundation’s Victoria Manager, SkyeMackay saidthe annual Good Sports Awards celebrate strong community sporting clubs and volunteers who are passionate about their community, their membersand making their club the very best it can be.
“The awards are the ultimate trophy for any Good Sports club. They shine the spotlight on success, celebrate the volunteers who are the backbone of community sport, and provide winning clubs with the recognition they deserve,” Ms Mackay said.
Good Sports clubs can enter multiple categories including Club of the Year, Volunteer of the Year,
Safe Transport Award, Mental Health Excellence Award, Junior Club of the Year, New Club of the Year and Community Club of the Year.
“Whether it’s your club’s champion volunteer, managing alcohol responsibly, looking after your junior members or supporting club members’mental health, you know your club’s biggest strength.”
“We encourageGood Sportsclubs to nominate today for achance to win,” Ms Mackay added.
GoodSports clubshave untilThursday, November 28 to nominate for their chance to be awinner at an awards ceremony in Melbourne next year and win ashare of more than $13,000 in prize money.

Great outcome: Corinella
and Angling Club membersand Member forEasternVictoria Region,
Bath arepleased fishing competitions remain heretostay. Photograph supplied
VICTORIANanglershave sighed with relief after the state government was forced to backdown on its intention to ban fishing competitions. Ahard-fought grassroots campaign led by Corinella Boating and Angling Club, Women in Fishing advocate Amanda Keilar, and Nationals Memberfor Eastern Victoria, MelinaBath, achieved its aim of pushing the state government to announce the fishing competition exemption.
The drafted new animal welfare laws were set to ban fishing competitions with clubs and anglers facing massive fines -from $58,000 for clubs and $12,000 for individuals.
The Gippsland petition, protesting the move attracted almost 3000 signatures.
Entering the awards is quick and easy, just visit: goodsports.com.au/awards
Good Sports is Australia’s largest community health sports program, helping to build strong community sporting clubs across Australia for over 25 years.
Working with more than 12,000 local sports clubs across Australia, Good Sports supports clubs to set up better environments for players, volunteers, supporters, and officials -helping to tackle tricky topics such as alcohol, drugs, smoking, mental health, and safe transport.











“Any consideration of fining Victorians for organising or participating in fishing competitions is atotal overreach, and it should have never been contemplated,” Ms Bath said.
“The failure to immediately ruleout the ban shows the Allan Labor government was testing the waters to see if they could impose it on alegitimate recreation activity.
“The Nationals will continue to support recreation and sport anglers, and recognise the significant contribution clubs, charter operators and small businesses make to our local communities.
“Fishing is an inclusive and accessible activity that can be enjoyed by all Victorians, it should be encouraged, and its future never threatened.”
Ms Bath congratulated the Gippsland fishing community for leading the chargeand forcing the state government to listen and act on their concerns.



MOE South Fire Brigade has benefittedafter receiving an upgrade tanker.
Now operational and ready for the upcoming fire season, the tanker was acquired thanks to supportfrom aCFA program upgrading to newer technology vehicles and equipment.
Moe South Fire Brigade Captain, Stephen Bates said the changeover hadbeen in the pipeline for anumber of years.
Thenew tanker came intooperationalservice when MoeSouth Brigade members undertook some familiarisation sessions last October.
The old tanker has served the brigade well over the past 34 years, for accessing 4WD tracks, in particular around the local HVP Plantationsand many bush tracks around the Latrobe Valley area, however due to its age it has had afew reliability issues of late.
Theupgradedtanker, which was previously beingused at Poowong, is aHINO RangerPRO 8Z (4x4) Type 3.4D tanker with an increased waterholding capacity of 3000 litres, as well as newer technology pumping controls and additional equipment now requiredtobecarried, whilst stillhaving the requiredfour wheel drive capacity -akey requirement for arural brigade like MoeSouth.
Moe South Fire Station is open most Sundays from 9.30am if anyone is interestedintalking to members or viewing the facilities and equipment. The brigade is also always looking for new members.
Moe South Fire Station is located at Lynne Avenue, Moe South.




YALLOURNNorth Senior Citizens celebrated their 50th anniversary with aparty held in their club rooms.
Members enjoyed abeautiful meal prepared by committee members followed by the cutting of the cake which was made by member Diane Coad and cut by the club’slongest serving memberMarie Holt.
Members dressed for the day. Best hat competitionwas won by Jean Cook, with second place going to Dice Perkins.
The club was originally formedin1974 and


eventually after much lobbying, agrant was received from Narracan Shire which enabled the clubroomstobebuilt attached to the Yallourn North Bowling Club.
The rooms were opened in 1995.
Over the past 12 months, the president has been collecting information from the club’s minutes books and has put together ahistory of the club.
The book was launched by oldest memberShirley Renwick (95) at the luncheon.
If anyone would like to purchase acopy for $10, ring Judy Redman on 0412 095 192.













LATROBE Health Services has started its Giving Tree Appeal at branches across Gippsland.
Latrobe Health is again supportingthe Gippsland community by accepting new, unwrapped gifts for children and young people who are cared for by Quantum Support Services.
The Christmas Giving Tree Appeal helps ensure that every Gippslander has aspecial festive season, and Latrobe Health is calling for community and member supporttogather as manygifts as possible.
Latrobe Health Services Chief Executive, Ian Whitehead said Latrobe Health is proud of its annual $5 million community investment, which supports many community organisations and health initiatives.
“We recognise the important work thatorganisations like Quantum do in our community, and we’re proud to be supporters of their work,” he said.
“Donating agift to our Giving Tree Appeal can bringa smile to the faces of children and their families at aspecial time of year.”
Spreadjoy this festive season by donating unwrapped new toys for childrenaged 0-18-yearsold or giving afinancial contribution.
Quantum is aGippsland-based organisation with officesinMorwell,Warragul, Sale and Bairnsdale. They support the local community with services including foster and kinship care, homelessness supportand family violence services.
Christmas Giving Trees are on display in Latrobe Health Services branches in Moe, Maryvale Private Hospital, Traralgonand Warragul.Gifts will be accepted until Friday,December 6. Check branch hours on the LHS website.
Alternatively, give a financial donation through this link: givenow.com.au/christmas-appeal-2024
Joy: Latrobe Health Ser vices staffKateJar vis and Kirsten McGill celebrating asuccessful haul of donationsfor Gippsland children. Photograph supplied

ST PAUL’S Anglican Grammar School students joined together to reflect and honour service personnel during the school’s Remembrance Day Service.
The respectful student-led service was areminder to preserve the memory of those who serve and have served the country, ensuring their sacrifice is never forgotten.
Respects: Year 6students
Adam, and Year 10 students Thang-Guwand
at the Traralgon Cenotaph on Remembrance Day. Photographs supplied












AS the ShadowMinisterfor Dandenong continues to harangue readers with essentially the same letter, did he ‘get’ the cutting subtlety of the editor’s headline: 'What have the Romanseverdone?' (Latrobe Valley Express Opinion, 06/11/24). Unless the writer is aMonty Python fan, which I seriously doubt, he would have missed the underlying premise, that his now familiar tirade be taken as comedy relief, rather than acoherent argument. Expanding his toxic wrath to all politicians, for the gentleman’s mental health, Isuggest emigration to amore worthy environment; one thatmight better suit his world view.
Writing in The Age,inpraiseofDandenong, Rhonda Garad said: “If Afghanistan, Albania and Sudanhad ababy, it would be called Dandenong”. So, the Shadow Minister is well used to non-Australians.
My short list for emigration included Vladivostok and Pyongyang but letters to the local paper can leadtolife imprisonment.Wuhan on the Yangtze, home to the COVID hoax, has pleasant river views andadecent market. But my runaway suggestion is Lone Star, East Texas. Most antivaxxers are dead, but EastTexas is awash with Trump sycophants, wild-eyed TV evangelists and undocumented immigrants. Fox News is the single source of information. Imagine our correspondent’s delight, on averanda rockingchair,chanting to his neighbours, “go back to where you come from”, as the new presidential regime does just that. With Go Fund Me now passing the$1b mark, this cause could mark acelebration point for Go Fund Me, and awin/win for both ourcorrespondent and this reader.
Ian Whitehead Traralgon
Use what we have
THE reading of aletterbyAnthonyWasiukiewicz in the Express earlierthis year ('Reality means coal will stay', 31/07/24), was very enlightening. Loy Yang is obviously not agood choice for nuclear, as geographically it is unsafe. His comments on Fukushima and Wonthaggi were very positive. The Star of the South was proposed in the Turnbull government and has not progressed because it’s not viable. Now is the time to stop jumping puddles: set agoal, get it done. The debateonnuclear and renewables with so much to and fro is wasting time. Why do we not consider making fossil fuel cleaner? Use what we have already available in bounty It will be the voters who will make adecision in the long run, but it is the government and the opposition who have to put aviableplanonthe board for us to decide our future.
Patricia Correa Traralgon
Right in
WE have the perfect candidate for anew chief executive at Latrobe City CouncilinDamian Andrews.
Duringthe recent elections, he gaveevery candidate (I was one) the chancetotalkabout local issues and if elected how we would make adifference.
Sincethe conclusion of the elections, he has promoted the many local attractions that we have in the LatrobeValley.Hesees potential in the area and is willing to back up his talk with results.
Damian would give Latrobe City Council the leadership that is urgentlyrequired to move forward as aregion as opposed to stagnating as we have done for many years.
Guss Lambden Moe
HARRY Houdini was just 52 whenhediedon Halloween in 1926 at Grace Hospital in Detroit, succumbing to peritonitis (blood poisoning).
Famous in lifefor his supernatural escapes, Houdini promised his wife (Bess) that -ifhedied before her -hewould escape fromthe grave to send her acoded message from the great beyond.
Over the next 10 years, Bess hosted annual seances on Halloween night in the hope that Houdini would make contact with her from the spirit world. But on Halloween 1936,she finally gave up, declaring to the world: "Houdini did not come through... Idonot believe that Houdini can come back to me, or to anyone."
Fast forward to 2024 and the current defiance of the lawsofphysicsand theSecond Law of Thermodynamics (aka arenewables-onlyeconomy championed by Australia's reality-proof Energy Minister Chris ‘Blackout’ Bowen) has Bowen's delusional pipedream entailing not only forcing industry to pay ever-rising gas and electricity costs, but also inflicting great misery and poverty on millions of Australian households.
American atmospheric physicist Professor Richard Lindzen, in closing hisspeech at aconference in Brussels in May this year, said thefollowing: "So here we are, confronted with policiesthatdestroy Western economies, impoverish the working middle class, condemnbillions of the world'spoorest to continuedpovertyand increased starvation, leave our children despairing over the alleged absence of afuture, and will enrich the enemies of the West who are enjoying the spectacleofour suicidemarch (China,Russia, et al), amarch thecowardly energy sector accepts, being too lazy to exert the modest effort needed to check the colossal damage that is being done to our economiesand the lives of whole populations in the name of supposed climate change."
It took Bess Houdini 10 painful years to finally wake up and accept the hard reality that Houdini was never coming back to her.
But unlike BessHoudini, Australia does not have 10 years, for by thattimeand if Labor is re-elected, therewill be no economyleft to resurrect as we will have passed the point of no return.
Joseph Lis
Morwell
LATROBECityCouncil’s significantincrease in charges for facility use and other cost requirements imposed for community events creates ahugebarrier to economic recovery and hinders job creation.
Steep cost increases faced by the Latrobe Valley Eisteddfod, or the quotation to the Briqueorium of $4215 for useofcouncil-supported facilities to hold aLegodisplay, or the addition of traffic management costs to community markets do more than limit events.
These increased costs by Latrobe CityCouncil stifle economic growth.
Historical retail pioneers like Sidney Myer understood afundamental principle: activity breeds activity.
Myer's success came from creating environments that drew people in and kept them engaged. Myer is known for dressing women staff in casual clothes and as agroup they rummagedthrough slowmoving garment tables.
This activity drew the attention of shoppers who weredrawntothose tables and shopped.This same principle can helprevitalise Latrobe City, but onlyif Latrobe City Council supports making its facilities accessible to community groups.
The mathematics of economicrevivalisclear.

Supportingcommunityevents creates multiple layers of economic benefit.
TheEisteddfod's six-weekprogramfromAugust to September this year is both aperforming arts festivaland an economic engine. Families book accommodations, dineinlocal restaurants,shop in local stores.
If Latrobe City is beautifullypresented, they not only return again and again but also recommend Latrobe City to others.
The dollars Latrobe City Councilspendson subsidising facility access multipliespositively through the economy and helps create jobs.
Importantly, regular community events create more sustainable employment than one-off large conferences. Sure, major conferencesgenerate impressive headlines, but any economic benefit (if any) is just aminor blip. One-off large events cannot provide longterm job creation.
Alternatively, acalendar fullofcommunity events enables local businesses to confidently hire permanentstaff,knowing there will be consistent customer flow throughout the year.
The evidence of Latrobe City Council’s failure to stimulate growth is in the many vacant shopfronts.
These empty spaces are opportunities waiting for aproactive leadership to create the right conditions.
Sidney Myer understood the benefit of expendituretocreatebuzz that leadstoeconomic benefits.
Rather than increasingly making things more difficult for community groups and smallbusiness, LatrobeCityCouncil need to acknowledge theirapproach of makingitharderfor community groups, multiples the economicdifficulty experienced in the community.
To achieve economic revival, council should:
-Createasupport package for community events that includes marketing assistance and logistical support, including traffic management;
-Develop acoordinated event calendarwith community organisations that maximises economic impact across the year, and;
-Track and measure the economic multiplier effect of these events to guide future investment.
The current high facility costs is preventing Latrobe City job creation and holding back economic growth.
Whencommunity groups are forced to payhigher costs by Latrobe City Council for holding events, theLatrobe City people are not just missing out on an event -wemiss outonvisitors, spending, publicity, and the chancetoshowcase Latrobe City to potential investors.
Council need to recognisethe solution to revitalising Latrobe City's economy isn't in restricting access to facilities -it'sinopening them up.
Support must be given for community groups to create vibrant, engaging events.
This will build the foundation for sustainable economic growth and job creation.
The choice is clear:maintainhigh facility fees with additional add-on costs and watch Latrobe City continue to struggle, or invest in the Latrobe City community groups and watch Latrobe City grow and thrive.
Damian Andrews Latrobe City Council Watch President
VICTORIA is Australia’s leading exporter of food and fibre products, with sales representing more than athird of the state’s overall exportsand supporting 330,000 jobs.
In 2022/23, Victoria’s food and fibre exports achieved arecord $19.6 billion, up seven per cent from the previous year.
This is areal testament to farmers, businesses and food manufacturers,who haveall shown
tremendous resilience to moderate the impact of the COVID-19 pandemic.
Victoria’s products are exported to key international markets including China, Japan, the United States, New Zealand,Indonesia, Singapore, Malaysia,South Korea, the United Arab Emirates, and India.
Demandfor grain, meat, dairy,horticulture, preparedfoods,seafood,wine,animalfibre and forest products are all helping drive this growth.
That is why Australia has alot to offer as a trusted and reliable trade and investment partner.
Importantly, federal Labor is helping Victoria unlock new opportunities that will delivermore exports and create more jobs.
When the Albanesegovernmentwas elected twoand-a-half-years ago, therewas $20 billion worth of trade impediments with the Chinese government.
That meant producers of barley, cotton, oaten hay, coal, meat products, copper ores, wine and timber logs had effectively been blocked.
With one in four Australian export dollars coming from trade with China, federal Labor set out to stabilisethis relationship with our country’slargest trading partner.
Today, less than $500 million of those impediments remain, largely thanks to the Albanese government’s calm and strategic response led by Minister for Trade, Don Farrell.
In greatnews,Australiarecently secured a timetable for the return of live rock lobster into China by the end of the year.
Recently, federalLaborstrengthenedagricultural ties with China by signing aletter of intent on cooperation to explore more efficient trade of organic goods exports.
Australia is also boosting exports in the Middle East, securing alandmark trade and investment agreement with the United Arab Emirates in September.
This major deal will remove more than 99 per cent of tariffs on Australian products and increase exports by almost $700 million ayear. It will deliver benefitsfor farmers and food producers on productssuch as sheepmeat, seafood, dairy, beef, lentils, nuts and steel.
With one in four Australian jobs relying on trade, federal Labor is creating new opportunitiesfor Victoria’s exporters, farmers, producers and businesses to diversify their markets.
And we will continue to ensure Victoria’s highquality products can be enjoyedbythe world,while delivering economic benefitsand more jobs for the regions.
Senator Raff Cicoone
Federal Labor Senator for Victoria and Deputy Government Whip in the Senate


ey pe to the editor.
Preference will be given to brief, concise letters which address local issues. Letters must include aphone number, email address and the author’s hometown for purposes of substantiating authenticity. The views expressed in letters to the editor are thoseofthe writers, and do not necessarily reflect theviews of Latrobe Valley Express management or staff.
Email letters to news@lvexpress.com.auand include ‘Letter to the Editor’ in the subject line. Deadline for letters is Thursday 3pm.












The vision for the White Ribbon movement is anation whereeverywoman is free from all forms of men’sviolence and abuse.
Alot of men sharethe belief that violence against women and children is unacceptable, yet sadly the issue still has huge prevalence throughout the country.
White Ribbon Australia invites men to step up, speak out and be partofthe change
Australia needs men and boys to join in making alasting change in attitudes and behaviors.
Men speaking to other men about violence against women is apowerful catalyst for change, and mobilising men is apowerful tool in ending men’sviolence against women.
Earlier this year,aseries of focus groups wereheld with men and boys from all ages and stages of life, colours, cultures, shapes and sizes.
What was found was alarming.
Therewas avisible disconnect between men and the issue of violence against women.
The messages out in the community about preventing violence werenot reaching the people who needed to hear it most.
For too long, women have been alone in championing endingviolence against women.
To see change, men need to walk alongside women.
That all starts with men being willing to talk about violence against women.
Changing behaviour doesn’thappen by telling men how to think, act or feel.
It starts by listening and having honest conversations about how to be better for ourselves and others.
The simple symbol of the white ribbon signifies the desirefor change and the willingness to address the hardissues to see that happen.
It is time to talk, to open up anddiscuss wrong attitudes, it is time for men to step up and protect their women.
It all starts with men.


























































































CFAisurging residents to preparetheir properties ahead of the fireseason, with parts of Victoria already under firerestrictions.
Following adrier-than-average autumn and winter,several areas in Victoria arefacing an increased firerisk this summer due to abuildup of dead and dryvegetation, particularly in forested regions.
While CFA’s 52,000 members arewell equipped to supportcommunities, it’simportant for the community to understand that firesafety is ashared responsibility between fireservices and the public.
CFAChief Officer Jason Heffernan stressed the importance of early preparation this spring. Community members areencouraged to remove light and heavy fuels around homes and test their sprinklers, pumps and generators.
Simple tasks such as clearing gutters, pruning overhanging branches, maintaining grass at a safe height, and moving wood piles away from your house or shed can greatly improve your property’schances of withstanding abushfire.
Landowners areencouraged to conduct safe private green waste burn-offs wherepossible and notify authorities in advance.


Those conducting burn-offs must register online at the FirePermits Victoria website (www.firepermits.vic.gov.au),orbycalling Triple ZeroVictoria on 1800 668 511
Youcan check if your area is under Fire Danger Period here https://www.cfa.vic.gov. au/warnings-restrictions/fire-danger-period/ fire-restriction-dates
Everyhousehold should take the time to create aBushfireSurvivalPlanfor their property and their family and areencouraged to keep it somewherevisible and practice it beforethe season.
Being prepared saves lives, and it could save your home. Find out how you can create aplan at www.cfa/vic.gov.au/bushfireplan
Do not drive through high firerisk areas on hot, dry, windy days. Plan an alternate routeor delay your travel if possible.
Stay informed about conditions and ratings within your local area, and always use more than one source of information for warnings and alerts. Tune into emergency broadcasters, download the VicEmergency App or visit emergency.vic.gov.au






























































































Monday25th of November to Sunday1st of December 2024

NAAW2024 provides an opportunity to mark 21 years since asbestos was completely banned in Australia.
During NAAW2024 let’scelebrate the progress that has occurred since the ban, but also highlight that asignificant amount of ageing asbestos-containing material remains in Australia’sbuilt environment.
This means thereisanongoing need for vigilance to prevent exposureto asbestos fibres and aneed to focus on safe, proactive removal.
Asbestos and Silica awareness event
ON Friday 29th November at 11am the Asbestos and Silica Awareness Day Event will be held at Gippsland Heritage Park in Moe.
The event raises awareness of
asbestos and silica and its effects on sufferers, their families, the community and the environment.
Several speakers of interest will provide valuable information and resources.
The YesICan Choir and RichardHarris Bagpiper will be partofthe event along with an ecumenical service conducted by Reverend Gradwell Fredericks to remember those who aresuffering and those who have succumbed to asbestos and silica disease.
Families will be able to lay flowers and pay tribute to their loved ones.
Therewill be acommunity BBQ at the conclusion of the event prepared and cooked by the Moe Lions Club.
Forfurther information please contact Vicki Hamilton on mobile 0407 274173.





































































ASBESTOS Awareness Week is an important event for Victorians, especially those living in the Latrobe Valley
Asbestos is amaterial that was used in building of residential and industrial buildings between the 1940s and late 1980s, beforeits health risks were known.
Asbestos materials werebanned nationally from December 31 of 2003, but remain an important material to look out for today especially when renovating.
Morethan half the homes in the Latrobe Valley still contain asbestos, so extra caremust be taken for people renovating their homes.
Any home pre1990 will have asbestos lurking in it.
Due to asbestos’ versatility and heat resistance, materials containing asbestos can be found in many areas of the home that one may not consider
Afew places to be especially careful of when renovating are; roof sheeting, floor coverings, inside of walls, fireplace infills and wall heaters, wet areas and ceiling cavities.
Before yourenovate ACV/GARDS highly recommends that youobtain an asbestos audit on your home


Are you repairing, renovating or restoring a building constructed prior to 1990?
No matter how large or small your project, asbestos needs to be identified and disposed of safely
To book an asbestos check or removalcontact us now.

JOINthe Latrobe Orchestra for an enchanting afternoon of music at the Postcardsfrom Europe concert on Saturday, November 30 at the Traralgon Town Hall.
The orchestra will take you on acaptivating journeyacross Europe withaselection of timeless compositions, featuring the stirring March Slav, the renowned Anvil Chorus from II Trovatore, and the vibrant Capriccio Italian.
The concert will also feature the magnificent voices of the Gippsland Children’s Choir, as well as performances from Latrobe Valley Orchestra’s beginner strings program musicians.
Concert starts at 5pm.
Traralgon Town Hall is located on the corner of Breed Street and Grey Street.
Admission is $18 for adults. Children under 18 get in for free.
Tickets can be purchasedatthe Gippsland Performing Arts Centre boxoffice or through the GPAC website.
PAR KL an eP re cinc tC ommun ity Ga rden will hold asod turning ceremony this Sunday (November 24) from 11.30am.
There are two vitalingredients to asuccessful community garden.
The first of theseiscommunity-and anumber of community and stakeholder meetings have been held this year, engaging local residents, including the Uniting Church, Good Start Early Learning Centre, Mind Australia, Food For All Latrobe Valley, Latrobe City, Uniting and the Rotary Club of Traralgon.
The second is the garden space itself. It needs to be open, inviting, welcoming and safe -aplace you want to spend time in, and not just to do the weeding. Good garden design elements include the practical spaces you would expect in acommunity garden, and some gathering and reflective spaces.
This really is an exciting time as the key outcomes for the community garden initiative are:
Building community at the Park Lane precinct;
Building the physical infrastructure for a community productive garden and outdoor gathering space;
Connecting with others to provide resources to address food insecurity in the region, and;
Providing learning opportunities around growing and preparing food.
Join us as we celebrate the start of the garden constructionphase at 19 Park Lane, Traralgon.
The Park Lane Precinct will also be launchingits paint apicket program so people can be involved in painting pickets for border fencing.
For enquiries, phone Heather on 0483 803 922.
MOE Latrobe Valley Jazz Club will hold its final function for 2024 this Sunday (November 24) at Moe RSL.
Commencing at 2pm, music will be provided by Hot BHines.
This band,led by the ever popular Ken Collins, has been playing at Moe Jazz Club and festival for more than 30 years.
During that time, the band has proved to be the most popular to play at Moe and this year will be no exception. For enquiries, phone Bruce on 0427 743 516.
IN the first game of the round, Jack Holme defeated Ian Hamilton who won all other clashes in Latrobe Valley Chess.
Ben Jacksonstruggled withform early, but was then able to force checkmate against Cliff Thornton who had won three tight battles.

Emma Jackson created chances but errors were punished in key games.
PeterBakker finishedwith two wins, two losses and adraw.
Steve Ahern kept in the fight although the material deficitleft few choices other thanto resign.
The first series of battles for Matt Jackson provided challenges and he was rewarded with one win.
Gerrard Dyke found awinning streak before his early finish.
HannahJackson was forced to defend the attacks and managed to find one win.
Phone Cliff Thornton on 0413 330 458, or Ian Hamilton (0400 221649)for more detailson local chess.
KNITTED Knockers, Traralgon branch held their major raffle recently.
Winners were:
First prize: KGore
Second: HJackson
Third: UFisher
4th: RJones
5th: Toni and Stef
6th: DCarlton
7th: KMurray
8th: JNeville
9th: SHalliday
10th: SMcNeil
11th: MCieslak
12th: Shellie
All winners have been notified.

ORGANISERS of the Great Aussie BBQ wish to send ahugethank you to all for their support.
The barbecue, held on October 27 at the Uniting Church ParkLane, saw morethan $2000 raised for Frontier Services.
The money goes to supporting outback farmers with property maintenance,education and food on the table in tough times.
Thanks to all who attended or forwarded donations. It is well appreciated.
JOIN Latrobe Valley Dance Promotions Inc to have fun, socialise and dance the night away at the end of year social ballroom dance (no lessons).
The dance will be held Thursday, November 28 at the Girl Guide Hall (18 Margaret Street, Morwell) from 7pm to 10pm at acost of $5 per person.
Please bring aplate of supper to share.
Since this is the last dancefor the year, feel free to come dressed in Christmas attire. Phone Norm on 0428 543 737, or Lynda (0428 489 041) for more information, or email: latrobevalleydancepromotioninc@gmail.com
TUESDAY, November 12: 1st Heather Watt and AnneHowes (63.54 per cent); 2nd Kaye Douglas and Roshni Chand (62.04). Thursday, November 14: 1st Helen McAdam and Moira Hecker (61.11); 2nd Don Tylee and Roshni Chand (56.94).
If you would like to play or learn more about Bridge,phoneTraralgon Bridge Club President, Greg Nicholson on 0419 365 739.
LATROBEValley Prostate Support Group will be held at Morwell Club on Wednesday, November 27 from7pm.All membersare invited, while new members are most welcome. Somemembers gather at 6pm for acounter tea before the meeting.
This meeting is the last for the year. For mor ei nfor ma tio n, pho ne Al lan Cunningham on 0458 111 688.
ACOMMUNITY in the Latrobe Valley who love singingspend each Friday afternoon at different aged care and similar venues to sing for senior citizens.
With Christmas fast approaching,the group is currently presenting anumber of carols. If anyone would like to join sharing the joy of song, call Judith Thompson on 03 5135 6126.
IF youare acommunitygroupand have any newsitems you need publicised, feel free to email us at news@lvexpress.com.au
You can address the correspondence to Editor, Liam Durkin.
Please write ‘Community Corner’ in the subject line and nothing else.
Deadline is Friday 9am to appear in the following Wednesday issue.












Bo wel canc er is one of the mostf eared dia gnos es becau se of the associa ted is sues witheverything from scree ning to surgical int er vention and per ceived risk to life
With this sa id it is onl yo ne of an umber of cancers th at for th em ost part affect the bod yl at er in life.
There are ac ou ple of genetics yndr omes such as familial adenosis polypos is or Ly nch syndrome that can affect peo ple early in life,c ha ra cterised by ac arpe tof polyp sw ithi nt he la rge bo wel but fort he most part the risk of bo wel cancer is associ at ed witholder people. Bo wel canc er does not strike out of theb lue .
Acolonoscopy is the gold standardto diagnose the cause of the blood in the bowel motion andifa polyp is found it can be easily removed.
Polyps can turn into bowel cancers.
Colonoscopies arerecommended usually at three to five yearintervals or if apolyp is found it is recommended to repeat the colonoscopy ayear later
Colonoscopies aresafeinskilled hands with the risk of misadventurebeing very very low
Both surgeons and gastroenterologists are skilled in doing colonoscopies and most importantly in determining what to do if something is found.
If something is found asurgeon is well placed to advise what to do.
In regional and rural centres the surgeon who did the colonoscopymay be able to offer an operation.
Careisthereforeseamless without travel and alongwaiting time for an operation




















































ange
Screeni ng for bo wel cancer with af ae cal occul tb lood test is sensitive an dquick and easy
It is onlya screeningt es ta nd ap osit ive testd oes no t mean you ha ve ac ancer
The blo od can come fro manum ber of sourc es such as haemorr hoids ,i nflamma tor yb ow el disease or polyps
Blood detec ted in the bo wel moti on requires a colonoscopy
with asurgeon you don’t know
An operation forbowel cancer canvary in complexity depending on thenatureof the cancer,where it is located; its size and whether other organs close by areinvolved.
Keyhole operations areobviously preferred and techniquesvaryfromkeyhole assisted, robotic assisted and classic open operations.
In general mostbowel cancers detected early have agood prognosis.
Early detection is important and can result in chemotherapy or other treatments not even being necessary.
It is important to be properly assessed and referred.
Colonoscopy is verystraightforwardtaking only about half an hour and is only aday case procedure.
The result is durable for about three to five years
Just ask your GP for areferral.


































by Joanne Madeline Moore



Aries (Mar 21 - Apr 19)
November 18 –November 24 2024
Joint ventures and trust issues are on the table but don t spoil a potentially productive week by being a verbally blunt and/or physically reckless Ram Slow down, think before you speak and consult with loved ones and colleagues before you make any important moves Pluto shifts into your hopes-and-wishes zone mid-week (where it stays until 2043) so its a wonderful week to set transformative goals and dream powerful dreams for the years ahead

Libra (Sep 23 - Oct 22)
With Pluto transiting into your leisure and friendship zones, you’ll be drawn to exploring hobbies, people and places A childs talent blossoms, a new friendship flourishes or a burgeoning romance progresses to a deeper level So expect a busy week full of pleasing partnerships, convivial conversations and colourful creativity The weekend looks wonderful courtesy of a work opportunity, an outdoor adventure or a favourite four-legged companion

Taurus (Apr 20 - May 20)
Powerful Pluto transits into your career zone mid-week (where it stays until 2043) so there are ambitious goals to set and lofty heights to reach over the next few years Which will require hard work, passion and plenty of persistence No procrastinating or snoozing on the sideline, Bulls! Then Fridays Venus/Saturn link is fabulous for planning a heavenly holiday networking with work colleagues or nurturing a long-term personal relationship

Gemini (May 21 - June 20)
It’s time for a well-organised pivot Gemini! Smart Twins will examine all possibilities, especially ones that come from left field With powerful Pluto transiting into your aspirations zone it’s important to have ambitious longterm goals that you re steadily working towards You ll have to be patient though, as you focus on bringing your dreams down to earth via a practical plan Then – when everything is in place – you ll know the perfect time to pounce

Cancer (June 21 - July 22)


This week the planetary focus is on your daily routine and work zone but expect some challenging developments and stressful moments Resist the urge to be a bossy, moody and cantankerous Crab Try to ground your emotional energy and calm your restless mind Your motto for the moment is from actress Goldie Hawn (who turns 79 on Thursday): “The ability to remain calm and focused in stressful situations is central to making positive decisions ”
Leo (July 23 - Aug 22)
Its a lovely week for Lions! On Tuesday, there’s a terrific Sun/Neptune trine which boosts creativity and compassion so you’ll feel like painting writing performing or helping someone in need The Sun (your patron planet) shimmies into fellow fire sign Sagittarius (on Friday) when you’re fired up and ready to socialise fraternise travel and explore! Then the Sun links up with Pluto, which will help you take a deep dive into a special close relationship

Virgo (Aug 23 - Sep 22)
Many V rgos w ll fee very unsett ed on Monday, when the Mercury/Jup ter opposition stirs up your restless s de Then P uto powers nto your work and wel being zones, where it stays unti 2043! So your job and your hea th wi l be under the m croscope for many years to come t’s a good t me to reorganise your da ly routine and work schedule, p us make your diet hea th er and your fitness routine more regu ar Your motto for the moment? Health is wea th

Scorpio (Oct 23 - Nov 21)
Your power planet, Pluto, transits into Aquarius and makes a positive link with the Sun, which is fabulous for boosting personal charisma and generating creative ideas Don t be stubborn and unimaginative about your current plans and choices though As birthday great, singer-songwriter Bjork observes: “I sometimes fall into the trap of doing what I think I should be doing, rather than what I want to be doing” Keep your mind flexible and your options open

Sagittarius (Nov 22 - Dec 21)
Theres an impulsive Mercury/Jupiter opposition on Monday which boosts your blunt and tactless side So slow down Sagittarius and think (carefully) before you speak especially when dealing with family and friends Pluto powers into your communication and education zones mid-week, which could signal a learning renaissance as you consider studying a topic that has always fascinated you Then the Sun shimmies into your sign, and its your turn to shine!

Capricorn (Dec 22 - Jan 19)
After sixteen years, Pluto finally transits out of your sign and into your inner/outer security zone Hopefully you’ve learnt some important, transformative lessons along the way Now you re set for a major transformation involving self-esteem or financial matters over the next few years Clever Capricorns will concentrate on personal development and growing your nest egg for the future Friday is fantastic for strategic, long-term planning


Aquarius (Jan 20 - Feb 18)
Pluto transits into your sign, so curious, quirky Aquarians are keen to ricochet off in transformative new directions And don’t worry about making messy, complicated (or embarrassing) mistakes along the way Keep stretching your wings, trying new things and being the authentic you Draw inspiration from actress Goldie Hawn (who celebrates her 79th birthday on Thursday): “I want to dig deep and ask - Who am I? What do I have to offer? What do I have to learn?”

Pisces (Feb 19 - Mar 20)
Tuesday’s Sun/Neptune tr ne favours compassionate, creat ve and spiritual pursu ts But are your asp rations for the future ambit ous enough? The current stars favour ruminating over b g-p cture deas And there’s no room for fa se modesty or passive Piscean procrastination as you enjoy talking text ng post ng, promot ng and socia ising, and then come up with a cracking plan and pursue it Powerfu P uto also encourages you to dream big and d g deep
COPYRIGHTJoanneMadelineMoore2024




By MORWELL HISTORICAL SOCIETY
SHAW Street in Morwell and Churchill is named after Donald Shaw.
Donald Shaw (1832-1911) at age 18 emigrated from the Isle of Mull, Argyllshire, Scotland with his parents Archibald Shaw (1801-1891) and Ann Shaw (nee MacDonald, 1806-1882) and his brothers, Neil, Col and John, and sisters Marion (Sally) and Jessie, sailing on the Ascendant from Plymouth to Port Adelaide arriving on January 15, 1851.
In 1854, theShawfamily left South Australia forVictoriawhere Donald purchased 60 acres of freehold land in Tarneit.
In 1874, on hearing that land was available for selection in the Morwell area, Donald Shaw and his brother Col selected 320 acres each in Hazelwood North. The landwas heavily timbered and required clearing and then cultivated with grassesand the rotation of crops (oats) andpotatoes to improve the soil.
Donald began dairy farming and the cream was sent to the Morwell Butter and Cream Factory. Donald won first prize for his butter at the Morwell Agricultural Society Produce Exhibition in March 1892. He was renowned for introducing Ayrshire cattle to his dairy herd to improve the quality of the milk production.
to where the better landcould be selected. He was amember of the Morwell Agricultural Society and the HazelwoodNorth Presbyterian Church for many years.
In their latter years, Lillie’s parents William and Laura Gardner came to live in Church Road, Hazelwood North on aproperty of 40 acres and nearby to Donald and Lillie’s property. William and Laura died just three days apart in November 1918 and are both buried in the Shaw family grave at Hazelwood Cemetery.
In 1888, Donald Shaw led adeputation of ratepayers to theShire of Traralgon Councilrequesting expenditure on roadsinthe West Riding (Morwell/ Yinnar/Boolarraareas)proportionate with the amount of rates collected from the ratepayers in that riding.
In August 1890, apetition signedbythe majority of ratepayersinthe WestRiding, was presentedto His Excellency the Governor of Victoria in council requesting the severance of the West Riding from the Shire of Traralgon and that anew shire be formed –the Shire of Morwell.

In 1881/1882 Donald Shaw and his brother transferred their respective leases to each other. The allotment then held by Donald Shaw was known as Otterburn.
Donald’s sister Marion(also known as Sally) had marriedArchibald McDonaldatMoonee Ponds in May 1856.

Adeputation of ratepayers from the West Riding met with the Minister for Public Works in February 1891toagainseek the severanceofthe WestRiding to create anew municipality. It was not until May 27, 1892 in the Government Gazette that the Governor in Councilmadean Order constituting the Shire of Morwell and redefining the boundaries of the Shires of Traralgon and Narracan. It was also ordered that the newly constituted Shire of Morwell should consist of six councillors.














To advertise your bargains, products or services in










It is likely that Marion, with her four sons, two daughters and stepson joined the Shaw family at Hazelwood North in 1874.
At the poll conducted on Thursday,August 25 1892, Donald Shaw was elected and topped the poll with 432 votes. Other councillors elected were: John English,William Murdoch, William Murphy, Edmund Kelleher and Michael Mulcare.

























Marion Shaw first selected land at Bennetts Creekin1877 and shortly afterwards, two adjacent allotments.Marion’syounger sister Jessie selected land near her brothers Donald and Col in 1877.
In 1881, Donald’s younger brother John arrived withhis family and selected landinnearby Jeeralang.
Donald’sparents came to live at Otterburn.Ann passed away in 1882 and Archibald in 1890.
In March 1883,Donald at age 51 years, married Lillie Gardne (25) at Tarneit. The Shaw and Gardner familieshad been neighbours in Tarneit Donald andLilliehad eight children: Anne (married Herbert ‘Joe’ Bolding), Archibald (md. Ivy Mills), Donald Jr (md Lavinia ‘Sis’ Williams), William (md. Rose Hoyle), Laura (md. Uriah ‘Sec’ Billingsley), Alexander (md.LucySilcock),Charles (md.Flora McKay) and Victoria (md. HenryVinall)
There are many descendants of this Shaw family in the Morwell area today.
Donald was highly regarded in the area and his opinion was sought from prospective selectors as
At thefirst council meeting held on Wednesday, September 14, 1892, Cr Shaw was nominated and unanimously elected by his fellowcouncillors to be Shire President.
The councillors praised Cr Shaw for his standing in the community, for being on the committee that drafted the petitionfor separationand for seeking support for this among the ratepayers.
Cr Shaw humbly accepted the position,and “thanked his fellowcouncillors for the honour and that he would use his earnest endeavours to conduct business lawfully and felt that the Shire of Morwell was destined to be the model council in Gippsland”. Cr Shaw remained on council for six years. Donald Shawpassed away on December 3, 1911 aged 79 after aperiod of ill-health. He is buried in the Shaw family plot at Hazelwood Cemetery.
Donald Shaw was duly honoured to have astreet named after himinMorwell and again in Churchill

DESSERTMASTERS
10, Sunday, 7pm
Thesweet life: MelissaLeong andAmaury Guichon present DessertMasters



From dessertsthatlookjustlikeVegemite jarstoburningcloudsoffairyfloss, this season has seen some incredible sweet treats designed to tantalise all the senses. Now,it’sthe Grand Finale, with the final three contestants creating fiveservesofverdant green and glittering gold creations, overtwo courses, to seewho comesawaywith the prizeof$100,000 and thetitle of 2024 Dessert Master.Judges Melissa Leong and AmauryGuichon arenot alone in deciding the winner –they’llbejoined by season one competitors, “Queen of Chocolate”KirstenTibballs, “Sweet Assassin”Adriano Zumbo and inaugural winner,Tarts Anon’s Gareth Whitton, to crownanew sugary monarch.
Wednesday, November 20
ABC TV (2)
SBS (3)
THE GREAT HOUSE REVIVAL SBS, Saturday, 9.25pm

Architect Hugh Wallace follows homeowners acrossIrelandasthey trytorestore and transform derelict properties into comfortable homes –while saving apieceofarchitectural heritage –inthis charming series. Tonight’sseason opener sees carpenter Sully and mental health nurse Mary-Claire(both pictured) put in alot of hardgraft to restoreThe Parson’s House –afour-bedroom Georgian cut stonebuilding located at the central crossroads of Churchtown in County Cork. Over the course of ayear and ahalf, and including the adoption of afurry addition to thefamily,the pair create astunning modern home while paying homage to the building’srich past.
10, Monday, 7.30pm
Filmed in Manchester, England, the iteration of this perennialgame sh sees expat Australians testtheir w solving skills under the guidance o host-with-the-mostGraham Norton. Premieringtonight,the reinvigorated format will see three players spinthe wheel to be in with the chance of winning $50,000.Norton’strademark wit and charm bring areal warmth to thegameashe shares the players’highs and lows andthrows in ajokeor two.Atthe end of each episode, Norton invites the player with themostwinnings to spin the “Min Wheel”. If they can solveone final puzzle within 10 seconds, they cou be goinghomewith the big prize.






SEVEN (7,6)
6am Morning Programs. 9.10 Lucknow. (PG, R) 9.20 Paul O’Grady’sLittle Heroes. (PGa, R) 9.50 ForThe Love Of Dogs. (PGa, R) 10.50 Soccer.2026FIFAWorld Cup CONMEBOL Qualifier.ArgentinavPeru. 1.00 PBS News. 2.00 Such WasLife. (PG, R) 2.10 SecretsOf The TowerOfLondon. (PGa,R) 3.00 Plat Du Tour 3.10 The Cook Up.(R) 4.10 The Supervet. (PGa, R) 5.05 Jeopardy! (R) 5.30 Letters AndNumbers. (R) 6.00 Sunrise. 9.00 TheMorning Show. (PG) 11.30 SevenMorning News. 12.00 My Kitchen Rules (PGl, R) 1.40 Border Security: International (PG, R) 2.10 Catch Phrase. (PG, R) 3.00 TheChase. (R) 4.00 SevenNews At 4. 5.00 TheChaseAustralia.


NINE (9,8) 6.00 News Breakfast. 9.00 ABC News Mornings. 9.55 The SpaceShuttleThat Fell To Earth. (PG,R) 10.55 Q+A. (R) 12.00 ABC News At Noon. 12.30 NationalPress Club Address. 1.35 Media Watch. (PG, R) 2.00 Parliament QuestionTime. 3.00 ABiteToEat With Alice. (R) 3.30 Long Lost Family.(PG,R) 4.15 GrandDesigns New Zealand (PG, R) 5.00 AntiquesRoadshow. (R)
ABite To EatWith Alice. 6.30 Hard Quiz. (PG,R) 7.00 ABC
7.30 7.30 8.00 Hard Quiz (PG) 8.30 Question Everything. (PG) Presented by WilAnderson and Jan Fran 9.05 Fisk. (Ml, R) Ray has a big announcement 9.30 Planet America. 10.05 Spicks And Specks. (PG, R) 10.35 Adam Hills: The Last Leg. (R) 11.15 ABC Late News. 11.30 The Business. (R) 11.50 Mother And Son. (Ms, R) 12.45 Grand Designs New Zealand.(PG,R) 1.30 Killing Eve. (MA15+v, R) 2.15 ParliamentQuestion Time 3.15 Long Lost Family.(PG,R) 4.00 Rage.(MA15+adhlnsv)
4.30 Gardening Australia. (R) 5.30 7.30.(R)
6.00 Mastermind Australia. (R) 6.30 SBS World News. 7.35 Michael Mosley: Wonders Of TheHuman Body Presented by the late Michael Mosley.
8.30 TheJury: DeathOnThe Staircase: TheEvidence. (Malv) Day fiveofthe trial delivers aseries of surprisesfor the members of the jury.
9.30 TheOld Man (MA15+v) Chase and Harper’s choices backfire
10.45 SBS World News Late. 11.15 Maxima. (Premiere,Mls) 12.10 Miniseries: DI Ray.(Malv,R) 3.40 Inside The Modelling Agency.(Ml, R) 4.35 Bamay.(R) 5.00 NHK World EnglishNews Morning. 5.30 ANC PhilippinesThe World Tonight.
6.00 SevenNews. 7.00 HomeAnd Away (Final, PGav) Remi refuses to be silenced.
8.30 TheBig Trip (PGal) The teams travel to Streaky Bay,where Lehmo teaches Dilruk to drive.
9.30 FirstDates UK (Ma) In a Valentine’s Day special, followssingles, including Chris, Saskia andRoisin, as they embarkonfirst dates.
10.35 TheLatest:Seven News
11.05 Unbelievable Moments
Caught On Camera (PGal, R)
12.05 Stan Lee’sLucky Man. (MA15+av)
1.05 Travel Oz. (PG, R)
2.00 Home Shopping. (R) 4.00 NBC Today. 5.00 Sunrise 5am News. 5.30 Sunrise.
Country 7.30 Harry’sPractice. 8.00 Million Dollar Minute 9.00 Left Off The Map 9.30 NBCToday Noon Better HomesAnd Gardens. 1.00 Escape To The Country. 2.00 Sydney Weekender 2.30 TheYorkshire Vet. 3.30 Left Off


Spinking: Graham Norton hosts Wheel ofFortune Australia

e latest ow favourite word-puzzle f niuld W
SBS, Tuesday, 8.30pm
ComposerAndrew Lloyd Webber pictured) delves intohis family’s historyinthe firstepisodeofthis 9th UK season of genealogical nvestigations, eager to find out wherehis talent and love formusical heatrecomesfrom. Searching his mother’s side,the Catsand Phantom oftheOperamaestro discovers his neage is “posher thanwethought”, finding aknighted hero of the Battle of Waterloo andaformidable Tudor Duchess who stooduptoHenry VIII. Turning to his father’s line,he uncovers the work of amissionary n19th-centuryLondon and a group of 18th-centurytheatrical musicians with eerie similaritiesto he current-day Lloyd Webberclan.
TEN (10, 5)
6.00 Today 9.00 Today Extra. (PG) 11.30 9News Morning. 12.00 MOVIE: Snowkissed. (2021, G, R) 2.00 Pointless. (PG) 3.00 Tipping Point (PG, R) 4.00 9NewsAfternoon 4.30[VIC]TippingPoint Australia.(PG) 5.00 Tipping Point Australia. (PG) 5.30[VIC]WINNews. 6.00 The Talk.(PGa) 7.00 Deal Or No Deal. (R) 7.30 Farm To Fork. (R) 8.00 Neighbours.
6.00 9News
7.00 ACurrentAffair
7.30 Taronga: Who’s WhoIn TheZoo: Saving Koalas (PGm) The team assesses koala populations.
8.30 ARIAAwards. (Mls) Coverage of the Australian music industry’smajor awards ceremony from HordernPavilion, Sydney 10.30 9News Late
11.00 My Life As ARolling Stone. (Madl, R) 12.15 Law &Order:Organized Crime.(Mav)
1.15 Innovation Nation. 1.30 TV Shop: Home Shopping. (R) 2.30 Global Shop.(R) 3.00 TV Shop: Home Shopping. (R) 4.00 Believer’s Voice Of Victory.(PGa) 4.30 ACurrent Affair (R) 5.00
ABC (2) SBS (3)
6.00 News Breakfast. 9.00 ABC News Mornings. 10.00 Australian Story.(R) 10.30 Back Roads. (R) 11.00 Plum. (Madl, R) 12.00 ABC News At Noon. 1.00 Grand Designs Australia. (R) 2.00 Parliament Question Time 3.00 ABite To Eat WithAlice. (R) 3.30 Long Lost Family.(PG, R) 4.15 Grand Designs New Zealand. (PG, R) 5.00 Antiques Roadshow. (R)
7.30
by Sarah Ferguson.
8.00 Grand Designs Australia: Surry Hills (PG) Hosted by Anthony Burke
9.00 Long Lost Family (PG) Davina McCall and Nicky Campbellmeettwo people haunted by events of the past.
9.45 Fake Or Fortune? Cosway Or Lawrence. (R) Afamily portrait is investigated.
TheBusiness. (R)
Grand DesignsNew Zealand. (PG, R)
Killing Eve. (MA15+v,R) 12.50 Parliament Question Time 1.50 Long Lost Family.(PG, R) 2.35 Rage. (MA15+adhlnsv) 3.30 Catalyst. (PGm, R) 4.30 Gardening Australia. (R) 5.30 7.30.(R)
6am MorningPrograms. 10.10 Paddington Station 24/7.(PGa,R) 11.00 Secret Cities. (PGan, R) 12.00 BBCNews At Ten. 12.30 ABC World News Tonight. 1.00 PBSNews. 2.00 SuchWas Life. (R) 2.10 Secrets Of TheTower Of London. (PGa, R) 3.00 Plat Du Tour 3.10 Railway Vietnam. (PG,R) 3.40 The Cook Up.(R) 4.10 TheSupervet. (PGa,R) 5.05 Jeopardy!(R) 5.30 Letters And Numbers. (R) 6.00 Sunrise. 9.00 The Morning Show. (PG) 11.30 SevenMorningNews 12.00 MOVIE: Malicious Mind Games. (2022, Mav) Laura Ault,AprilHale, RaianySilva. 2.00 Your Money &YourLife. 2.30 Border Security: International. (PG, R) 3.00 TheChase. (R) 4.00 SevenNews At 4. 5.00 TheChase Australia.
6.00 Mastermind Australia. (R) Presented by Marc Fennell.
6.30 SBS WorldNews.
7.30 Going Places With Ernie Dingo. (PG) Rae Johnston goes stargazing.
8.30 OsherGünsberg: AWorld Of Pain. (Mads) Osher Günsberg spearheads apersonal investigation into the causes of chronic and persistent pain.
9.40 Miniseries: Steeltown Murders (Premiere, Malv)
Authoritiesreopen the investigation into three murders from the’70s.
10.45 SBSWorld News Late.
11.15 Miniseries: TheTypist. (Masv, R) Anne Liebig makesa discovery 12.20 Pandore. (MA15+av,R)
4.05 Peer To Peer (R)
4.35 Bamay. (R) 5.00 NHK World EnglishNewsMorning 5.30 ANC PhilippinesThe WorldTonight.
SBS VICELAND (31) 6am Children’s Programs. 6.05pm Kangaroo Beach. 6.20 Bluey 6.25 Paddington. 6.40 Pfffirates. 6.50 Ginger And TheVegesaurs. 6.55 HeyDuggee. 7.05 Andy And The Band 7.20 Bluey. 7.30 Shaun The Sheep 7.35 Little Lunch. 7.50 Operation Ouch! 8.20 BTN Newsbreak. 8.25 SecretsOfThe Zoo. 9.10 Teenage Boss:NextLevel. 9.40 DoctorWho 10.25 Merlin. 11.10 Late Programs.
6am Morning Programs.
2pm StoriesFromThe Land. 2.30 The CookUp. 3.00 The MagicCanoe. 3.25 TheWorld According To Grandpa. 3.35 Spartakus. 4.05 Cities Of Gold. 4.35 Motown
ABC FAMILY (22) 6am Malcolm. Continued. (1986,PG) 7.05 An Ideal Husband.(1999,PG) 8.55 Sometimes Always Never. (2018,PG) 10.35 Australian Rules. (2002, M) 12.25pm Hounds. (2023, M, Berber) 2.10 Tourism. (2017) 3.35 Without AClue. (1988,PG) 5.35 Another Mother’s Son. (2017,PG) 7.30 TheLast Vermeer.(2019,M) 9.40 Hurricane.(2018,MA15+) 11.40 Late Programs.
6.00 SevenNews.
7.00 TheForce: Behind TheLine. (PG, R) Police search forillegal firearms.
7.30 HighwayPatrol. (PGa) Documents the work of the members of the Victoria Police HighwayPatrol.
8.30 TheFront Bar:YearIn Review (Ml) SamPang, Mick Molloy and Andy Maher takealighter look at theyear that wasinsport
10.00 To Be Advised.
10.30 Jimeoin: Result. (Ml, R) Stand-up performance by Jimeoin.
11.50 Unbelievable Moments
Caught On Camera (PGa, R) Footage of headline-grabbing moments.
12.45 Magnum P.I. (Mav)
2.00 Home Shopping. (R)
4.00 NBCToday 5.00 Sunrise 5am News. 5.30 Sunrise
6.00 Today. 9.00 TodayExtra.(PG) 11.30 9News Morning. 12.00 Taronga: Who’s Who In The Zoo. (PGm, R) 1.00 My Way. (PG) 1.30 Getaway.(PG,R) 2.00 Pointless.(PG) 3.00 Tipping Point. (PG, R) 4.00 9News Afternoon. 4.30[VIC]TippingPoint Australia.(PG) 5.00 Tipping Point Australia. (PG, R) 5.30[VIC]WINNews.
6.00 9News
7.00 ACurrentAffair
7.30 RPA: Joseline’s New Liver (PGm) Apathologist battles his ownmortality.
8.30 Emergency (Mm) Doctors urgently needanswers in acase involving one of the sickest patients they haveseen
9.30 A+EAfter Dark. (Mlm) Aman is rushedinto Majors suffering acollapsed lung, with airleaking into his chest cavity.
10.30 9News Late.
11.00 Casualty 24/7 (Mm, R) The paediatric teambattles alack of beds. 11.50 ResidentAlien. (Mav) 12.40 Tipping Point. (PG,R)
TV Shop: Home Shopping. (R) 2.30 Global Shop (R) 3.00 TV Shop: Home Shopping. (R) 4.00 Believer’sVoice Of Victory. (PGa) 4.30 ACurrent Affair (R) 5.00 Today Early News. 5.30 Today
6.00 Deal Or No Deal
HostedbyGrant Denyer 6.30 TheProject. Alook at the day’snews. 7.30 TopGearAustralia. (PGl) Theboysbattle it out to determine which decade wasthe best for cars. 8.50 MOVIE: Mission: Impossible –GhostProtocol. (2011, Mv,R)After a covert organisation is implicated in the bombing of theKremlin, aspy and his team go rogue to uncoverthe truth. It appears the agencyhad stumbled across aplot by aRussian to startanuclear war. TomCruise,Jeremy Renner,Simon Pegg 11.30 10’s Late News Coverage of news, sportand weather 11.55 TheProject. (R) 1.00 TheLateShowWith Stephen Colbert. (PG) 2.00 HomeShopping. (R) 4.30 CBSMornings. 6am WorldWatch. 10.00 TheMovie Show Noon WorldWatch. 12.30 Hustle 1.25 WhoKilledThe WCW? 2.20 Ice Cowboys. 3.15 Cook Up Bitesize. 3.20 Wine Lovers’ Guide 3.55 WorldWatch. 5.55 Adam EatsThe 80s 6.15 Curse Of Oak Island. 7.05 Jeopardy! 7.35 8Out Of 10 Cats DoesCountdown. 8.30 GreatestEscapes With Morgan Freeman 10.10 Invisible Nation. 11.45 Late Programs.
SBS WORLD MOVIES (32)





Friday, November 22
ABCTV (2) SBS (3)
SEVEN (7,6)
NINE (9,8) 6.00 News Breakfast. 9.00 ABC News Mornings. 10.00 Planet America. (R) 10.30 IWas Actually There. (PG, R) 11.00 Fake Or Fortune? (R) 12.00 ABC News At Noon. 1.00 Shetland. (Malv, R) 2.00 Plum. (Mls, R) 3.00 ABite To Eat With Alice. (R) 3.30 Long Lost Family (PG, R) 4.15 Grand Designs NewZealand. (R) 5.00 Antiques Roadshow (R)
7.30 Gardening Australia. Tammy Huynh refreshes pot plants.
8.30 Shetland. (Mal) Unnerved by herdiscovery,Calder decides to stay on in Shetland.
9.30 Fisk. (Ml, R) Ray has a
1.05 Rage New Music. (MA15+adhlnsv) 5.00 Rage.(PG)
7.05 Andy And The Band. 7.20 Bluey. 7.30 Shaun The Sheep 7.35
YoungJedi Adventures. 7.50 The
Chores 8.00 Scooby-Doo And
8.25 BTN
6am MorningPrograms. 10.05 Paddington Station 24/7.(PGal, R) 11.00 Secret Cities. (PGav,R) 12.00 BBC News At Ten. 12.30 ABC World News Tonight. 1.00 PBSNews. 2.00 Such WasLife. (PG, R) 2.10 SecretsOfThe Tower Of London. (PGa, R) 3.00 Nula. 3.30 Plat Du Tour 3.40 The Cook Up.(R) 4.10 The Supervet. (PGa, R) 5.05 Jeopardy! (R) 5.30 Letters And Numbers. (R)
6.00 Mastermind Australia. (R) 6.30 SBS WorldNews 7.30 EveryFamilyHas ASecret: Peter Eden And Derek Pedley. (Mav,R)A man searches for the truth about his father
8.35 Castle Secrets: TheWarlock, Joan Of Arc, AFortress In The Holy Land. Takesalook at castles.
9.30 Kennedy:The Kennedy Machine (1956-1960) Kennedy embarks on afive-yearcampaign.
10.20 SBSWorld News Late. 10.50 Elvira (Premiere,Malv) 12 25 The Wall: TheChateau Murder.(Mlv,R)
2.55 Inside The Modelling Agency.(PGl, R) 4.45 Destination Flavour ChinaBitesize. (R)
5.00 NHK World EnglishNewsMorning 5.30 ANC PhilippinesThe WorldTonight.
8.30 Mythbusters “There’s Your Problem!” 8.55 Robot Wars:BattleOfThe Stars 9.55 Doctor Who. 10.40 Late Programs. ABC FAMILY (22) 6am Sometimes Always Never. Continued. (2018,PG) 6.35 AnotherMother’s Son. (2017,PG) 8.30 Whisky Galore. (2016, PG) 10.20 Iron Sky.(2012,M) Noon IronSky 2. (2019, M) 1.40 LoveAnd Friendship (2016,PG) 3.20 Malcolm. (1986,PG) 4.55
6.00 Sunrise. 9.00 The MorningShow. (PG) 11.30 SevenMorningNews 12.00 Beach Cops. (PG, R) 12.30 Test Cricket: Pre-GameShow. 1.20 Cricket. First Test.Australia v India.Day 1. Morning session. 3.20 Test Cricket:The Lunch Break. 4.00 Cricket. First Test. Australiav India.Day 1. Afternoon session.
6.00 SevenNews.
7.00 Cricket. FirstTest. Australia v India. Day 1. Late afternoon session. From Optus Stadium, Perth. 9.00 Cricket. Women’s Big Bash League Match 36.Brisbane Heat vMelbourne Stars. From Allan BorderField, Brisbane
11.30 TheFront Bar: Year In Review (Ml, R) Sam Pang, Mick Molloyand Andy Maher take alighter look at theyearthat wasinsport.
1.00 GetOnExtra. Alook at the weekend’s bestracing.
1.30 Taken. (Mav,R)Santana must face her past.
2.30 Home Shopping (R)
4.00 Million DollarMinute. (R)Hosted by Grant Denyer
5.00 NBC Today. News and current affairs.
6.00 Today 9.00 Today Extra. (PG) 11.30 9News Morning. 12.00 MOVIE: Christmas By Chance. (2020, G) Winny Clarke, Jacob Blair 2.00 Pointless. (PG) 3.00 Tipping Point. (PG) 4.00 9News Afternoon. 4.30[VIC]TippingPoint Australia.(PG) 5.00
6.00 9News.
7.00 ACurrent Affair.
7.30 David Attenborough’s Planet Earth III:Extremes. (PG, R) Narrated by Sir David Attenborough.
8.40 MOVIE: U.S. Marshals. (1998,Mlv,R)A US Marshal, accompanying agroup of convicts on aflight,pursues an escaped fugitive. TommyLee Jones, WesleySnipes, Robert Downey Jr
11.20 Inside Beverly Hills (Md) An escapist exploration of Beverly Hills.
12.15 Tipping Point (PG, R)
1.05 Helloworld (R)
1.30 TV Shop: Home Shopping. (R)
4.00 SkippyThe Bush Kangaroo (R)
4.30 Global Shop. (R)
5.00 TV Shop:Home Shopping. (R) 5.30 Postcards.(PG, R)


TEN (10, 5)
6.00 Deal Or No Deal (R) Hosted by Grant Denyer 6.30 TheProject Alook at the day’s news. 7.30 Jamie Oliver: Fast &Simple. Presented by Jamie Oliver
Matlock. (PGals, R) Matty’srusty trial skills areput to the test during a wrongful termination case by awoman claiming she wassexuallyharassed by herboss. Shae, the firm’s jury consultant and master
ABCTV (2) SBS (3) SEVEN (7,6)
6.00 Rage Charts. (PG) 7.00 Weekend Breakfast. 9.00 Rage.(PG) 12.00 ABC News At Noon. 12.30 TheLarkins At Christmas. (PG, R) 1.35 JuliaZemiro’s Home Delivery.(PG, R) 2.05 Question Ever ything. (PG, R) 2.35 Spicks And Specks. (PG, R) 3.05 Countdown50Years On (R) 4.40 Headliners. (PG,R) 5.30 Landline. (R)
6.00 Australian Story:Stepping Up –Elly-MayBarnes. (R) Elly-May Barnessharesher story
6.30 Take 5With Zan Rowe: Dannii Minogue. (PG, R) Dannii Minogue sharesfive songs.
7.00 ABCNews. Alookatthe topstories of the day
7.30 All CreaturesGreatAnd Small. (Return,PG) Jamestries to save adog fromits owner
8.20 Vera (PG, R) Vera investigates afatal stabbing outside anightclub.Identifying the victim as aformer police officer
9.50 Plum. (Madl, R) Gavin returnshome from Bali 10.45 TheSearch ForThe Palace Letters. (PG, R) Thestory of ProfessorJenny Hocking. 11.45 Rage. (MA15+adhlnsv)
6am MorningPrograms. 9.05 WelcomeTo My Farm. (PG, R) 10.05 Love Your Garden. (R) 11.00 Ageless Gardens. (PG) 11.30 Australia With Julia Bradbury. (R) 12.00 BBC News At Ten. 12.30 ABC World News Tonight. 1.00 PBS News. 2.00 Figure Skating. ISU Grand Prix 5. Highlights. 4.30 Plat DuTour 4.35 Ancient Egypt By Train.(PGa, R) 5.30 Forgotten Frontlines. (PGav,R)
6.30 SBS WorldNews.
7.30 Secrets Of TheRoyal Palaces: Private Lives. Explores secret storiesofpalace life
8.25 TheJur y: DeathOnThe Staircase: TheEvidence. (Malv,R) Day fiveofthe trial delivers aseries of surprises for the members of the jury.
9.25 TheGreat House Revival: Parson’s House, Co Cork. (Return,PGv) Hugh Wallace meets newlyweds who decided to renovate The Parson’s HouseinCountyCork 10.20 So Long, Marianne (Mals) 11.15 Paris Paris. (Ms, R) 12.15 Hope (MA15+av,R) 2.30 Face To Face.(Mals,R) 4.20 Peer To Peer.(PG, R) 4.50 Destination Flavour China Bitesize.(PGa, R) 5.00 NHK World English News Morning. 5.15 France 24 Feature. 5.30 ANCPhilippinesThe World Tonight.
6.00 NBCToday 7.00 WeekendSunrise. 10.00 The MorningShow: Weekend. (PG) 12.00 Border Security:International. (PG, R) 12.30 Test Cricket: Pre-GameShow 1.20 Cricket. First Test.Australia vIndia. Day2 Morningsession. 3.20 Test Cricket: The Lunch Break. 4.00 Cricket. First Test.Australia v India. Day 2. Afternoon session. From Optus Stadium, Perth.
6.00 SevenNews. 7.00 Cricket. First Test.Australia v India. Day 2. Late afternoon session. 9.00 MOVIE: 65 (2023,Mav) After a catastrophic crash, apilot discovers he is on aprehistoric Earth 65 million years in the past. With only one chance at rescue, he and the other survivor must cross aterrain riddled with dangerouscreatures. Adam Driver,Ariana Greenblatt,Chloe Coleman.
11.00 MOVIE: Tears Of TheSun. (2003, MA15+v, R) AUSspecial operations commander and his team head to Nigeria to rescue adoctor Bruce Willis, Monica Bellucci. 1.30 Taken. (Mav,R)A senator’s wife is kidnapped.
2.30 HomeShopping. (R)
4.00 Larry TheWonder Pup (R) Follows aterrier called Larry. 5.00 My GreekOdyssey. (PG,R)
6.00 Getaway. (PG, R) 6.30 ACurrent Affair (R) 7.00 Weekend Today.
NITV (34)
6am MorningPrograms.
1.20pm Brazil Untamed. 2.10 Nula. 2.40 MOVIE: Luis AndThe Aliens. (2018, PG) 4.20 Carpool Koorioke 4.30 Great LakesWild. 5.00 Taste Of The Territory 6.00 Carpool Koorioke. 6.20 News. 6.30 The OtherSide 7.30 Deadly Funny 2023 8.35 MOVIE: Child’sPlay.(1972,MA15+) 10.20 MOVIE: The Wrecking Crew! (2008,PG) 12.10am Late Programs.
6.00 9News Saturday.
7.00 ACurrent Affair
7.30 MOVIE: TheWizard Of Oz. (1939,G,R)Inthe middle of atornado,a youngKansas girl is transported to the magical land of Oz. JudyGarland,Ray Bolger
9.35 MOVIE: Hairspray. (2007, PGls, R) Ateenager’s obsession with aTVdance show pays off after shelands aspoton theprogram. Nikki Blonsky,Zac Efron.
11.45 MOVIE: TheSun Is Also A Star. (2019,Ml, R) Yara Shahidi.
1.30 Getaway. (PG, R)
2.00 TheIncredible Journey Presents. (PGa)
2.30 TV Shop: Home Shopping. (R)
4.30 Global Shop. (R)
5.00 TV Shop: Home Shopping. (R)
5.30 HelpingHands. (PG, R)
6.30 MOVIE: Moana (2016,PGa, R) The daughter of aPolynesian chieftain searchesfor ademigod responsible for aterrible curse. Auli’i Cravalho,DwayneJohnson.
8.50 TheCheap Seats (Mal, R) From major news storiestoentertainment and viral videos, presenters Melanie Bracewell and Tim McDonald take alook at the week that was. 9.50 Ambulance Australia. (Madl, R) Aman claims to havejumped off Brisbane’s Story Bridge and the team races againsttime to savehis life 10.50 Shark Tank. (PGa, R) Twoinventors havesome fast talking to do whentheir new improvedtoiletbrushsnaps. 11.50 Ambulance UK (Mdlm, R) Awoman goes into labour 1.00 Home Shopping. (R) 5.00 Hour Of Power. 6am WorldWatch.
10.00 TheMovie Show Noon Scrubs 2.05 Beyond Oak Island. 2.55 United We Drive. 3.20 Jungletown. 4.10 WorldWatch. 6.05 TheFuture 6.35 The Secret Genius Of Modern Life.(Final) 7.35 Impossible Engineering. 8.30 Great Australian Concerts: Diesel. 9.35 Great Australian Concerts: Grinspoon. 10.40 OsherGünsberg: AWorld Of Pain. 11.50 Late Programs.
6am The Movie Show. 6.30 LoveAnd Friendship.(2016,PG) 8.15 Without AClue. (1988,PG) 10.15 OSS117:From Africa WithLove.(2021, M, French) 12.20pm The Last Vermeer.(2019,M) 2.30 Another Mother’s Son.(2017, PG) 4.25 Whisky Galore. (2016,PG) 6.15 Lucky You. (2007, PG) 8.30 MichaelCollins. (1996 M) 10.55 Twin Flower.(2018, M, French) 12.45am Sound Of Metal. (2019, M) 3.00 Late Programs.
7TWO (72, 62)
6am Home Shopping. 8.30 Travel Oz. 10.00 Harry’sPractice. 10.30 IEscaped To The Country 11.30 GetOn Extra Noon Horse Racing. Cranbourne CupDay,The GongRaceday and Tattersall’sClassic Raceday 5.30 RSPCAAnimal Rescue 6.00 TasteOfAustralia With Hayden Quinn. 6.30 Bondi Vet. 7.30 The Yorkshire Vet. 8.30 Escape To The Country 11.30 The Yorkshire Vet. 12.30am Late Programs.
7MATE (73,64)
6am Morning Programs. 1pm Blokesworld. 1.30 On Tour With Allan Border 2.00 Rides Down Under: Workshop Wars. 3.00 Football. AFL Women’s.Preliminary final. 5.00 Counting Cars. 6.00 Test Cricket: TeaBreak. 6.20 Cricket. First Test. Australia vIndia. Day 2. Late afternoonsession. 7.00 Football. AFL Women’s Preliminaryfinal. 9.15 MOVIE: MiamiVice. (2006, MA15+) 11.55 Late Programs.
9GEM (92, 81)
6am Morning Programs. 8.30 Tomorrow’sWorld. 9.00 Turning Point. 9.30 TV Shop 10.00 Helping Hands. 10.30 My Favorite Martian. 11.00 MOVIE: TwoWay Stretch. (1960) 12.50pm MOVIE: Golden Ivory. (1954,PG) 2.40 MOVIE: Comanche. (1956,PG) 4.30 MOVIE: The Hallelujah Trail.(1965) 7.30 MOVIE: TheVow (2012, PG) 9.35 MOVIE: The FiveYearEngagement. (2012, MA15+) Midnight Late Programs.
9GO! (93, 82)
6am Children’s Programs.
1.10pm MOVIE: Pokémon TheMovie:Kyurem Vs TheSword Of Justice. (2012) 2.35 MOVIE: Pokémon TheMovie: Genesect And The Legend Awakened. (2013) 4.00 Surfing Australia TV 4.30 MotorwayCops: Catching Britain’s Speeders. 5.30 MOVIE: ShortCircuit. (1986,PG) 7.30 MOVIE: Harry Potter And The Prisoner Of Azkaban. (2004, PG) 10.15 Late Programs.


Sunday, November 24
ABC TV (2) SBS (3)
SEVEN (7,6)
NINE (9,8) 6.00 Rage. (PG) 7.00 WeekendBreakfast. 9.00 Insiders 10.00 Offsiders. 10.30 The World This Week.(R) 11.00 Compass. (PG, R) 11.30 Songs Of Praise. 12.00 ABC News At Noon. 12.30 Landline. 1.30 Gardening Australia. (R) 2.45 Nigella’s Christmas Kitchen. (R) 3.15 Long Lost Family.(PG, R) 4.00 Restoration Australia. (R) 5.00 Antiques Roadshow. (R)
6.00 Grand DesignsAustralia. (PG,R) 7.00 ABCNews.
7.30 Spicks And Specks. (Final, PG) HostedbyAdam Hills.
8.00 Fisk. (Final, Ml) Helen is plunged into crisis.
8.30 Plum (Final, Ml) After much anguish, drinking and avoidance, Plumtakes the advice long on offer andshareshis truth.
9.30 IWas Ac tually There: Beaconsfield MineDisaster (Final, Ml, R) Alook at the Beaconsfield Mine collapse.
10.00 Pick Of TheLitter (R) 11.20 New Leash On Life. (R) 11.50 Miniseries: Why Didn’t They Ask Evans? (Final, Malv, R) 12.50 Rage. (MA15+adhlnsv)
3.05 Australia Remastered:Nature’s Great Divide. (R) 4.00 Gardening Australia: Family EasterSpecial. (R) 5.00 Insiders. (R)
9.05 FreshOffThe Boat 9.50 Speechless. 10.10 Doctor Who 11.00 Late Programs. ABC FAMILY (22)
6am MorningPrograms. 2pm Football. Big Rivers Football League. Women’s Grand final.Ngukurr vEastside. Replay 3.15 Football. NTFL.Women’s.Under-18s. Replay 4.20 MOVIE: The Wrecking Crew! (2008,PG) 6.10 News. 6.20 WildMexico 7.30 Great LakesWild. 8.30 Gulpilil: One RedBlood. 9.30 MOVIE: Dark Age. (1987, MA15+) 11.15 Late Programs. NITV (34)
6am MorningPrograms. 11.30 Australia With Julia Bradbury. (R) 12.00 APAC Weekly 12.30 PBS Washington Week. 12.55 Plat Du Tour 1.00 Speedweek. 3.00 Cycling. MTB Enduro National Championships. Highlights. 3.30 Such WasLife. (R) 3.40 Portillo’s Greatest Railway Journeys. (PG, R) 4.35 TreasuresOfIstanbul. (PG, R) 5.30 Forgotten Frontlines. (PGa, R)
6.30 SBS WorldNews
7.30 Etruscans: Mysterious Civilisation (PGa) Alook at the Etruscan civilisation.
8.30 Secret Sardinia Mysteries Of TheNuraghi. Ateam of archaeologists and scientists explores the Nuragic civilisation in Sardinia.
9.35 WhySharks Attack. (Ma, R) Exploresthe cause of recent shark attacks.
10.40 Curse Of The Ancients: BC. (PGa, R) 11.35 SavingVenice (R) 1.15 Royal Autopsy. (Ma, R)
3.00 Inside The Modelling Agency.(PG, R) 3.55 How To Get Fit Fast. (PGn, R) 4.50 Destination Flavour China Bitesize. (R) 5.00
NHK WorldEnglish NewsMorning. 5.15 France 24 Feature 5.30 AlJazeera News.
6am WorldWatch. 9.30 Small Business Secrets. 10.00 MovieShow. Noon In My Own World. 12.55 FIG Trampoline World Cup Series. H’lights 1.55 Jeopardy! 4.00 WorldWatch. 4.30 PBS Washington Week. 4.55 Fashionista. 5.10 Shane Smith HasQuestions. 6.05 12 DishesIn12Hours. 6.40 Mysteries From Above 7.35 Abandoned Engineering. 8.30 Disaster Autopsy. 9.25 TokyoVice. 10.30 Late Programs. 6am Whisky Galore. Continued. (2016, PG) 7.25 Vanity Fair.(2004,PG) 10.00 Heartbreak Ridge. (1986,M) 12.25pm Suffragette. (2015,M) 2.25 Anandi Gopal. (2019,PG, Marathi) 4.50 To Catch AThief.(1955 PG) 6.50 Poms. (2019,PG) 8.30 LetThem All Talk. (2020,M) 10.35 Yalda, ANight ForForgiveness. (2019,M,Farsi) 12.15am Strangerland. (2015 MA15+) 2.20 Late Programs.
6.00 NBCToday 7.00 WeekendSunrise. 10.00 Cricket. Women’s Big Bash League. Match 39.MelbourneStarsvAdelaide Strikers. 1.00 Test Cricket: Pre-Game Show 1.20 Cricket. First Test. Australia vIndia. Day 3. Morningsession. 3.20 Test Cricket: TheLunch Break. 4.00 Cricket. First Test Australia vIndia. Day 3. Afternoon session. From Optus Stadium, Perth.
6.00 SevenNews. 7.00 Cricket. First Test.Australia v India. Day 3. Late afternoon session. 9.00 Cricket. Women’s Big Bash League Match40. Brisbane Heat vSydneySixers. From Allan Border Field, Brisbane
11.15 Crime Investigation Australia: MostInfamous: TheGirls Who Knew TooMuch –Sallie-Anne Huckstepp And Juanita Nielson. (Madv,R)A look at the case of Sallie-Anne Huckstepp
12.30 Miniseries: Patrick Melrose. (MA15+, R)
2.00 Home Shopping (R)
3.30 Million Dollar Minute. (R)
4.00 NBC Today. 5.00 Sunrise 5am News. 5.30 Sunrise.






TEN (10, 5)
6.00 Hello SA.(PG,R) 6.30 ACurrent Affair (R) 7.00 WeekendToday 10.00 CrossCourt. 10.30 Fishing Australia. (R) 11.00 Drive TV.(PGl) 11.30 Helloworld. 12.00 Golf. Australian PGA Championship.Final round. 5.00 9NewsFirstAtFive. 5.30 Postcards. (PG) 6am MorningPrograms. 9.00 Loving Gluten
6.00 9News Sunday.
7.00 60 Minutes. Current affairs program. 8.00 ARemarkable Place To Die. (Mlv) Anais investigateswhena body is found locked in an abandoned gold-mining tunnel. 10.00 9News Late.
10.30 See No Evil: Fallen Star (Ma) Documents the murderofKJTaylor 11.30 TheFirst48: Gangland. (Ma) Alook at the murder of Dallas Spruill. 12.20 World’s GreatestNatural Icons: Ear th. (R) Alook at some of Earth’s iconic structures
Believer’sVoice Of Vic tor y. (PGa)
9GEM (92, 81)
7TWO (72, 62) 6am Children’s Programs. 12.30pm Basketball. WNBL.Bendigo Spirit v Southside Flyers. 2.30 MotorwayCops: Catching Britain’s Speeders. 3.30 MOVIE: Getting Even With Dad. (1994, PG) 5.30 MOVIE: AgentCody Banks 2: Destination London. (2004,PG) 7.30 MOVIE: Gladiator.(2000,M)
Of The Jackal. (1973,PG) 11.30 Late Programs.
The final three contestants compete for the title of DessertMaster for2024and thechancetowalk away with $100,000 8.25 TheGraham Nor ton Show. (l) Graham Norton is joined on thecouch by Nicole Kidman, Cynthia Erivo, James Norton,
6.00 News Breakfast. 9.00 ABC News
Mornings. 10.00 Landline.(R) 11.00 Antiques Roadshow. (R) 12.00 ABC News At Noon. 1.00 Australia Remastered:Forces Of Nature. (Final, R) 2.00
Media Watch. (PG) Presented by Paul Barry. 9.50 Q+A. (Final) 10.50 ABC Late News. 11.05 TheBusiness (R) 11.25 Planet America (R) 11.55 GrandDesigns NewZealand. (R) 12.40 Parliament Question Time. 1.40 Long Lost Family.(PG, R) 2.30 Rage.(MA15+adhlnsv) 3.30 Catalyst. (PG, R) 4.30 Gardening Australia. (R) 5.30 7.30.(R)
R) 2.50 Plat Du Tour 3.00 Railway Vietnam. (PG, R) 3.35 The Cook Up.(R) 4.05 The Supervet. (PGa,R) 5.05 Jeopardy! (R) 5.30 Letters And Numbers. (R) 6.00 Sunrise. 9.00 The MorningShow.(PG) 11.30 News. 12.00 Beach Cops. (PG, R) 12.30 Test Cricket: Pre-Game Show 1.20 Cricket. First Test. AustraliavIndia. Day 4. Morning session. (Pleasenote: alternativeschedule may be shown due to changes to cricket coverage). 3.20 Test Cricket: TheLunch Break. 4.00 Cricket. First Test.Australia v India. Day 4. Afternoon session. 6.00 Today. 9.00 Today Extra. (PG)
6.00 Mastermind Australia. (R)
6.30 SBSWorld News
7.35 TheMighty Mississippi With Nick Knowles (Premiere, Ma) Nick Knowles travelsalong the Mississippi.
8.30 8Out Of 10 CatsDoes Countdown. Game show,featuring contestantsJon Richardson, Jack Dee,Lee Mack andRose Matafeo 9.25 NeverMind TheBuzzcocks. (M)HostedbyGregDavies
10.05 Have IGot NewsFor You
U.S. (Mals) Hosted by RoyWoodJr. 11.00 SBS World News Late.
11.30 ACriminal Affair (Mal) 1.10 Pray ForBlood.(MA15+av, R) 2.50 Love Your Home AndGarden. (PG, R) 3.45 Inside The Modelling Agency.(PGls, R) 4.40 Bamay. (R) 5.00 NHK World EnglishNews Morning. 5.30 ANCPhilippinesThe World Tonight
6.00 SevenNews 7.00 Cricket. First Test.Australia v India. Day 4. Late afternoon session. 9.00 Murder In ASmall Town. (Mav)Albergsearches forakiller when severalofCassandra’sformer classmatescelebrating their high school reunion discoveradead body at the marina, whose identity is unknown.
10.00 S.W.A.T. (Madv) SWAT teams up with the DEA,led by Mack Boyle to conductamassivegang sweep.
11.00 Code Blue:One Punch Killers. (Madv, R) Exploresthe issue of one-punch killings. 12.00 Satisfaction. (MA15+as, R) Neilmakes adeal with Simon.
2.00 Home Shopping (R) 4.00 NBC Today. 5.00 Sunrise5am News. 5.30 Sunrise
6.00 9News. 7.00 ACurrent Affair.
7.30 RBT. (Mdl)Follows the activities of police units.
8.30 Australian Crime Stories: TheInvestigators: Jane Doe. (Mv, R) Authoritiesinvestigate the discovery of the body of ayoung womaninSydney’ssouth in 1991.
9.30 AKiller Makes ACall: Daynes. (MA15+av) Alookat thecaseofLewis Daynes.
10.30 9News Late.
11.00 Chicago Med. (MA15+amv)
11.50 Tipping Point. (PG, R)
12.40 Pointless. (PG,R) 1.30 TV Shop: HomeShopping. (R) 2.30 Global Shop.(R) 3.00 TV Shop: Home Shopping. (R) 4.00 Believer’sVoice Of Victory.(PGa) 4.30 ACurrent Affair.(R) 5.00 TodayEarly News. 5.30 Today
6.40 Pfffirates. 6.50 Ginger And The Vegesaurs. 6.55 Hey Duggee. 7.05 Andy And TheBand. 7.20 Bluey 7.30 Shaun The Sheep 7.35 LittleLunch. 7.50 Operation Ouch! 8.20 BTN Newsbreak. 8.25 Hard Quiz Kids. 8.55 Teenage Boss:NextLevel. 9.25 Poh’sKitchen 9.55 Doctor Who 10.40 Late Programs. ABC FAMILY (22) 6am Children’s Programs. Noon Gossip
6am Morning Programs.
2pm StoriesFromThe Land. 2.30 The CookUp. 3.00 The MagicCanoe 3.25 TheWorld According To Grandpa. 3.35 Spartakus. 4.05 Cities Of Gold. 4.35 Motown Magic. 5.00 Our Stories. 5.30 News. 6.00 Bamay. 6.30 News. 6.40 Brazil Untamed. 7.30 Who Do YouThink YouAre? 8.30 Karla Grant Presents. 9.30 The LakeOfScars. 11.15 Late Programs.

6.00 Deal Or No Deal Hosted by Grant Denyer
6.30 TheProject. Alook at the day’snews. 7.30 WheelOfFortune Australia. (Premiere) Hosted by Graham Norton. 8.30 Matlock. (PGal) Olympia tasks Matty with getting close to their client,who is fighting forjustice in thewrongfuldeath of his wife. 9.30 Five Bedrooms. (Mls) Heather’s bliss is short-lived when her seemingly perfect boyfriend throws her agraduation party. 10.30 10’s Late News. Coverage of news, sportand weather 10.55 TheProject. (R)A look at theday’s news. 12.00 TheLate ShowWith Stephen Colbert. (PG) 1.00 Home Shopping. (R) 4.30 CBS Mornings. 6am WorldWatch. 9.30 Small Business Secrets. 10.00 TheMovie Show Noon WorldWatch.
Show. 6.05 Poms. (2019,PG) 7.45 Lucky
(2007, PG) 10.00 Twin Flower.(2018, M, French) 11.50 Michael Collins. (1996,M) 2.20pm Sissi: The Young Empress. (1956,PG, German) 4.15 Skies Of Lebanon. (2020, PG, Italian) 6.00 RedObsession. (2013, PG) 7.30 Brother And Sister.(2022, M, French) 9.35 The Perfect Dinner.(2022,M,Italian) 11.35 Late Programs. 7MATE (73,64)
Resto. 5.30 Pawn
6.00
Tea Break. 6.20 Cricket. First Test. AustvIndia. Late afternoon session. 7.00 Pawn Stars. 7.30 Outback Farm. 8.30 Mega Mechanics. 9.30 When Big Things Go Wrong.(Premiere) 10.30 Late Programs.
9GO! (93,
3.30
4.30 The Addams Family 5.00 Bewitched. 5.30 I Dream Of Jeannie. 6.00 The Golden Girls. 6.30 The Nanny. 7.30 Seinfeld. 8.30 LoveIsland Australia 10.00 MOVIE: Pitch Perfect. (2012, M) 12.10am Seinfeld. 1.10 TheNanny 2.10 Life After Lockup 3.00 Bakugan. 3.30


Tuesday, November 26
ABC TV (2) SBS (3)



.IIknowright know



If youansweredyes,then just thinkhow manyother people have also seen this ad. Then saytoyourself, “ifIhadadvertisedinthisspace, thosepeoplecould bestaring atmy business,productsorservicesfor awholeweek.” Hmmm... certainly somethingtothinkabout?
Toadvertise in theTVGuideorany other sectionofeach Wednesday’s Latrobe Valley Express, contactyourlocal representativetoday or call theofficeon 51354444 to speaktoone of ourfriendly,experienced consultants.








SEVEN (7,6)
NINE (9,8) 6.00 News Breakfast. 9.00 ABC News Mornings. 10.00 Teenage Boss: Next Level. (R) 10.30 SecretScience. (PG, R) 11.00 Antiques Roadshow.(R) 12.00 ABC News At Noon. 1.00 Headliners. (PG, R) 2.00 Parliament Question Time. 3.00 ABite To Eat With Alice. (R) 3.30 Long Lost Family.(PG, R) 4.15 Grand Designs New Zealand. (R) 5.00 Antiques Roadshow.(R)
6am MorningPrograms. 10.55 The World’s Most Remote Hotels. (Premiere, PGa) 12.00 BBC News At Ten. 12.30 ABC World News Tonight. 1.00 PBS News. 2.00 Have IGot News ForYou U.S. (Mals, R) 2.50 Such Was Life.(R) 3.00 The Weekly Football Wrap.(R) 3.30 Plat Du Tour 3.40 The Cook Up.(R) 4.10 The Supervet. (PGa,R) 5.05 Jeopardy! (R) 5.30 Letters And Numbers. (R)
6.00 Sunrise. 9.00 The MorningShow.(PG) 11.30 News. 12.00 Beach Cops. (PG, R) 12.30 Test Cricket: Pre-Game Show 1.20 Cricket First Test.AustraliavIndia.Day 5. Morning session. (Please note: alternativeschedule may be shown due to changes to cricket coverage). 3.20 Test Cricket: The Lunch Break. 4.00 Cricket. First Test.Australia v India. Day 5. Afternoon session.
TEN (10, 5)
6.00 Today. 9.00 Today Extra. (PG) 11.30 9News Morning. 12.00 Postcards. (PG, R) 12.30 Getaway.(PG,R) 1.00 Space Invaders. (PGa, R) 2.00 Pointless. (PG, R) 3.00 Tipping Point. (PG, R) 4.00 9NewsAfternoon 4.30[VIC]TippingPoint Australia.(PG) 5.00 Tipping
5.30[VIC]WINNews.
6.00 9News.
4.30 GardeningAustralia. (R) 5.30 7.30.(R)
6.00 Mastermind Australia. (R) 6.30 SBS World News. 7.30 GreatCoastal Railway Journeys: Faversham To Chatham. 8.30 Who Do YouThink YouAre? Andrew Lloyd Webber (Return) Andrew Lloyd Webber explores his roots. 9.40 GreatestTrain Journeys From Above:Darjeeling HimalayanRailway (R) Follows theDarjeeling Himalayan Railway. 10.35 SBSWorld News Late. 11.05 Babylon Berlin. (Ma) 12.50 Son Of.(MA15+v,R) 2.25 Love Your Home And Garden.(PGa, R) 3.20 Inside The Modelling Agency. (PGl, R) 4.15 Peer To Peer.(PG, R) 4.45 DestinationFlavour Down Under Bitesize. (R) 5.00 NHK World English News Morning. 5.30 ANC Philippines The WorldTonight.
6.00 SevenNews. 7.00 Cricket. First Test.Australia v India. Day 5. Late afternoon session. 9.00 MOVIE: Kingsman: TheSecret Service. (2014,MA15+lv,R)A troubled youngman must prove his mettle, and savethe world fromabillionaire set on killing millions of people, after he is recruited as acandidate to join a secret British spy organisation. Taron Egerton, Colin Firth,Samuel LJackson. 11.45 TheForce: Behind TheLine. (PG, R) Police conduct asearch warrant. 12.15 Satisfaction. (MA15+as, R) 1.15 Your Money& Your Life (PG, R) 2.00 Home Shopping. (R)
4.00 NBCToday 5.00 Sunrise 5am News. 5.30 Sunrise
7.00 ACurrent Affair
7.30 Travel Guides. (PGln, R) Thetravelguides headtoFrance.
9.00 TheGrand Tour (Ml, R) Presenters JeremyClarkson, RichardHammond and JamesMay head to Whitby,England.
10.20 9News Late.
10.50 RestoMyRide Australia. (PG, R) Thecrew restores aHRHolden. 11.50 Transplant (MA15+m)
Tipping Point. (PG, R)
TheGarden Gurus. (R)










Leader: GBSRecruitment Director,Rob Darbyisexcited forthe next chapter in the company’s journey. Photograph supplied
LOCAL recruitment partnersGBS Recruitment and Best Match Recruitment have come together through the acquisition of Best Match by GBS.
This strategicpartnership has unitedtwo well established brands, with hopes of broadening the range of services available to clients across Gippsland and beyond.
Best Match clients will be taken in by GBS, further helping employees find work and employers recruit staff.
GBS says the merger reinforcesthe company’s commitment to providing unparalleled recruitment solutions,creating new opportunities for clients, candidates,and the wider Gippsland community.
GBS Traralgonislocated at 7Post Office Place.
Jobseekers looking to register can phone 03 5174 2665.
By TOMHAYES
ALREADY proving to be apopular addition at Traralgon’s Crown Hotel is the new upstairs function room -Phelan’s.
Afterbeing in the worksfor about 12 months, CrownHotel finally opened Phelan’s for bookings last month, taking on one booking per weekend on average.
So far,Phelan’sisbooked outfor functionsfor the rest of the trading year, as well as some getting bookings ahead for 2025.
The upstairs function room can hold aminimum of 50 people, and as manyas200. Many of the features downstairs can be found in Phelan’s, fittedwith abar,entertaining area, toilets, and an outdoor balcony.
Also upstairs is akitchen, equipped to serve canapesatfunctions,socustomers can choose fromfoodslike roasttomato and goatscheese bruschetta, wagyu beef meatballs, and macaroni and cheese croquettes.
“It startedoff well and its proving very popular,” Crown Hotel Part Owner, Brett Melbourne said.
“We’ve had alot of enquiries, but we’ve already
SARAH Armstrong was awarded the prestigious 2024Money TalkPlanners ‘YoungProfessional of the Year’.
Ms Armstrong beatafield of more than100 eligible candidate sacross the country, and was recognised within the ResiliumInsurance Brokering (RIB) network.
This Morwell-based standoutwas nominated by thehead officeteamand selected by the executive committee for her exceptional achievements.
The recognitioncelebratesMsArmstrong’s commitment to delivering outstanding service, her innovative solutions to complex insurance challenges, and her significant contributions to both the industry and clients.
beenbooked out forthosedays,sothere could have been even more,” Crown Hotel Function Co-Ordinator, Emma Campbell added.
The two mentionedthe appeal of the function space being in Traralgon’sCBD,ascustomershave the decision to bar hop across town, or simply go downstairs following their function.
The name ‘Phelan’s’ holds special traditions to the Crown Hotel, named after the 1927 licensee of CrownHotel,Michael Phelan, who held the position for 30 years alongside his son, Denis.
The Phelan legacy continued in 1979 when Michael’s grandson, Terrance, brought the Phelan name back to Crown for the first time since 1957. Terrance purchasedthe freeholdin1983, solidifying Crown in Traralgon.
The currentownergroup of Crown Hotel had the pleasure of hosting Terranceand Nanette Phelan, withtheir extended familyfor the firstprivate viewing of Phelan’s in late October.
Newaddition: CrownHotel Function Co-ordinator,Emma Campbelland Part Owner, BrettMelbourne test out the baratPhelan’s Photograph: TomHayes






























Kats Fish &Chips 31 BarkerCrescent
HazelbankFish &Chips 2Hazelwood Road
Foodworks 13 Hyland Street
Foodworks 63 HenryStreet
KosciuskoCornerStore Cnr CosterCircuit
Traralgon Bowls Club Cnr Gwalia Street and LiddiardRoad
Traralgon News &Lotto
Franklin Street
Manny’s Market
Post Office Pl, Traralgon








































































By KATRINABRANDON
TYERS Art Festival again celebrated the best of the local art scene.
Thisyear’sfestival held added significance, being the 45th instalment.
About 50 people attended the gala opening, and many were in awe as soon as they stepped into Tyers Hall.








Throughout the weekend,people could view pieces and even buy their favourites to take home.
Before the event, judges Kelly Brumley, Lea Jones, Karen Rosato, Heather Snowdon, Colin
The festival featured about 500 paintings in acrylic, sketch, textile, and other media, covering Tyers Hall from top to bottom. There was no shortage of media styles and creations throughout the exhibition, alongside music, food and drinks.









McKeown, TonySmith, and Shelley Ditterich made the difficult choice of who won each category.
There was 17 main award categories and eight categories for young artists. Some categories included the Tyers Award, Oil, Acrylic, Watercolour,MixedMedia, Pastel,Drawing, GLaWACArt Award, Portrait Photography, Landscape Photography, Other Photography, Hangers Choice Award, Popular Choice,Designer
Craft Textiles, Designer Craft Metalwork and Designer Craft Other Artists suchasfeatured artist Ling Wang, Sale-based photographer Lotje McDonald, and local artist and musician Naomi White were among athrong who enjoyed the opening night. The Saturdayand Sunday(November 9-10) showcases saw an even flow of attendees looking forinspiration,their next local art piece, or afun day celebrating local talent.








































STUDENTSfromthe Academy of Music at St Paul’s Anglican Grammar School captivated the community at the Gippsland PerformingArts Centrewithanunforgettable evening of orchestral and choral masterpieces during their Kapelle Konzert.
Theconcert showcased atalented ensemble of student musicians fromYears 3to12, representing
bot ht he schoo l’s Trara lgo na nd War rag ul campuses. It featured adiverse range of works from renowned composerssuchasRameau, Haydn, Mussorgsky, Gilbert &Sullivan, and The Verve.
In addition, the evening also highlighted the academy’s pipes and drums program.
St Paul’s Academy of Music offers students the
opportunity to personalise their musical learning journey, supported by experienced music educators who inspire them to actively pursue their future musical potential.
As aresult, the program has become an aspirational model for others,admired by student musical groups both near and far for its ability to foster accomplished and confident musicians.

Reappointed: Professor Duncan Bentleywill continue as vice chancellor and president of Federation Universityfor anotherfiveyears.
PROFESSOR Duncan Bentley will continue as vice chancellor and president of Federation University Australia after being reappointed to the position for afurther five-year term.
STUDENTS from Traralgon Secondary College visitedENGIE and Eku Energy’s Hazelwood Battery, the first utility-scale battery to be builtat the site of adecommissioned coal-fired power station in Australia. The visit was part of aweek-long STEM program delivered for the first time in the Latrobe Valley by globalengineering, architecture and construction services company GHD.
GHD Manager for Gippsland and Technical Director for Dams and Traralgon local, Elise McQuilten explained the program.
“GHD’s Traralgon officedeliveredaweeklong Science, Technology, Engineeringand Mathematics
(STEM) program from October 14 to 18, 2024, in partnership with Traralgon Secondary College.”
“The STEM program was aimed at engaging with female Year 10 high school students to encourage them to pursue STEM-based subjects into Year 11 and 12, and onwards.
“GHD in Melbourne developedand hasbeen running this program for over seven years. It has grown quite large and is now being implemented across our regional offices. This was ourpilot year in the Traralgon office.
“The program consisted of anumberofintroductory sessions to aspects of engineering, some

external site visits, including to ENGIE and Eku Energy’s Hazelwood Battery, and aweek-long project that the students worked on and presented at the end of the week to representatives from their school, their parents, GHD representatives and client representatives.”
GHD’s Technical Director for Energy Storage & Renewables and fellow local, Peter Killeen said the tour gave students an insight into finer details of the power industry.
“As part of the STEM program GHD ran for the fourTraralgon Secondary College students, Itook thegirls to visit ENGIE andEku Energy’s battery energy storage system (BESS) with my colleague Emily Haberle, who is asenior geologist with GHD and also has long working history at Hazelwood mine,” he said.
“For their mini project, we had tasked the girls with developinga BESS project, lookingata few various engineering disciplines and what is required to bring aproject to life
“GHD arranged asitevisit of ENGIE and Eku Energy’s Hazelwood BESS to give the girlsan appreciation of areal life, operational battery to helpthem gain abetterperspective on the project they were doing, as well as to show them akey enabler of the transition to renewable energy through the deployment of BESS projects around Australia.
“ENGIE Project Manager, NoelAshford,who was involved in theconstruction of the battery, facilitated the tour and was very informativein explaining the various systems and functions to the students and the tour overall was agreat success and the girls found the trip very insightful.”
The Hazelwood Battery continues to support Victoria’s ambitious target of achieving 95 per cent of its energy from renewables by 2035.
Photograph: ENGIE/Noel Ashford
Insight: Traralgon College students Adaraand Imogen, GHDSenior Geologist EmilyHaberle, students Amyand Laraand GHD TechnicalDirector and BESS Subject MatterExper t, PeterKilleen at the HazelwoodBattery
The Hazelwood BESS utilises the existing 1600 MW of latent transmission infrastructure at the siteofthe former Hazelwood PowerStation to connect with the grid, providing rapid response capabilities to support grid frequency and stability, as well as for the greater integration of renewable energy resources
Professor Bentley was first appointed vice chancellor in 2020 at atimewhenthe university was navigating the challenging impacts of the COVID-19 pandemic, and has since led the university on a transformation agenda aimed at improving the learner experience,strengthening engagement with regional communities and ensuring itslong-term financial sustainability.
Akey achievement duringProfessor Bentley’s first term was the introduction of the Federation Co-operative Education Model -aglobally proven model which gets students world and work ready through paid placements, career preparation and workplace skill development.
“I am delighted and honoured and to be reappointed to the position of vice chancellor and president of Federation University Australia,” ProfessorBentley said.
“My tenure at Federation has coincided with one of the most challenging, yet also exciting times for our university, and Iamespecially proud of seeing our co-operative education model move from strength-to-strength as it is embraced by students, staff, employers and communities acrossthe country.
“My focus for my second term will be to position Federation as Australia’s first fully co-operative university, deliver an outstanding learnerexperience -particularly focused on supporting thosefrom equitygroups, whilealsosupporting Federation TAFE’s ambition to become the number one TAFE in Victoria.”
Federation’s reputation as aworld-class regional university has been enhanced under Professor Bentley’s leadership, including asignificant improvement in the latest Times Higher Education World UniversityRankings, withthe university moving into the top 401-500 universities in the world, an upliftonits position last year when it was within the top 601-800 universities globally.
ProfessorBentley will continuetobeavocal advocate for the university and the regions it serves, while ensuring thatFederation continues to deliver on its core objective of transforming lives and enhancing communities through improving equitable access to tertiary education, and supporting regional economic growth through the delivery of world-class learning, teaching and research.
Federation has campuses in Gippsland (Churchill), Berwick, Ballarat, Melbourne, and in the Wimmera region.
STUDENTS at Kurnai College’s Morwell campus are learning how to plant and re-pot native plants thanks to apartnership with Gippsland Water.
One hundred and fifty Lomandra grass seedlings will be planted on campus, with another 100 seedlings to be re-potted and planted at Moondarra Reservoir.
Gippsland Water Managing Director, Sarah Cumming saidplanting and re-potting the grasses would help students learn new skills and encourage them to take pride in their natural surroundings.
“It’s important for younger generations to have the opportunity to learn about native plants and their roleinsupporting local ecosystems -including waterways,” Ms Cumming said.
“Thesegrasseswill not only contribute to the campus’ landscape but serve as apractical example of sustainable gardening practices.
“The students will also bring there-potted grasses to Moondarra Reservoir and plant them at the recreation area we manage, which is currently being upgraded.”
Lomandragrasses areresilient plants and remain green all year round, making them alow maintenance addition to both the Kurnai College campus and Moondarra Reservoir.
Kurnai College Principal, Anthony Rodaughan said the schoolwas pleasedtobeworkingwith Gippsland Water on the project.
“Kurnai College has had avalued and productive relationship with Gippsland Water over the last fewyears, focusing on developing aconnection to Gunaikurnai Country and our local First Nations students and families,” Mr Rodaughan said.
“The relationship continues to grow in positive directions and the college is delighted to join with GippslandWatertoprotect our local flora and fauna through this planting initiative.
“We thank and congratulateGippsland Water for their lead role in this project and look forward to our continuing cooperation together.”
To find out more about Gippsland Water’s work to protectand enhancebiodiversity, visit www. gippswater.com.au/biodiversity














By enteringintothe Latrobe Christmas Lights Competition Or simply register the location of your display for the whole community to enjoy!
Addressesofall registered and competition displayswill be printed in theLatrobe Valley Express during December.






The winningdisplay in each townwill receive: $50 Gift Voucher from $50 TM&H Gift Card PLUS






Email your NAME (not for publication), ADDRESS, PHONE NUMBER (not for publication) and a HIGH RESOLUTION PHOTOGRAPH of your Christmas display to: reception@lvexpress.com.au
All competition entries and photographs must be received by Latrobe Valley Express by 12 noon on Friday 13 December,2024

Judging will take place Monday 16 December, 2024 and winners will be notified by phone and published in the Latrobe Valley Express on Monday 23 December,2024.

Forfurther enquiries please phone Jenny on 5135 4444
Email: reception@lvexpress.com.au













ROYAL LifeSavingAustralia’s Keep Watch Campaign launchesahead of summer to remind Victorian parents and carers about the risks of child drowning.
Between 2014and 2024,there was 197 drowning deaths of children aged 0-4 years in Australia, 65 per cent of which occurred in aswimming pool or bathtub.
The majority (82 per cent) of swimming pool deaths occurred while the child wasnot being directly supervised by an adult.
Drowning risk for youngchildrenpeaks in summer,with37per centofall deaths occurring between December and February
With the warm wea ther and holi day season approaching,itiscrucial to ensure that one responsible adult is always actively supervising children whenever they have access to water, including social gatherings around water.
Tra gica ll y, dr own ing inc idents hav e occurred when one adult assumes someone else is watching the children.
Swimming pools arethe leading location fordrowning young children. Between 2014 and 2024, 92 children aged 0-4 years lost their lives in aswimming pool, with 41 per cent of these children aged just one year.The majority (91 per cent)occurred in abackyard swimming pool.
Most children accessed the swimming pool unsupervised through agate that had been propped open or not properly closed.
“It is vital you keep constant watch and restrict access to water around the home,”
Royal LifeSaving Australia Chief Executive, Justin Scarr said.
“This is the time of year to check your pool fence and gate are in working order.”
“If there is alapse in supervision, acorrectly installedand regularly maintained pool barrier can prevent your childfrom drowning. Alwayscheckyou’ve closedthe pool gate behindyou, never leave the gate propped open and restrict children’s access to outdoorareas without adult supervision.”
Accidental falls into water (75 per cent) were the leading activity prior to drowning in this age group followed by bathing (19 per cent).
Between 2014-2024, 37 children drowned in abathtub,with 54 per cent aged less than one-year-old.
Drowning in children is quick and silent, andamomentary lapse of supervisioncan be amatter of life and death.
It is essential youngchildrenare not left in the care of older children when around water.
Royal Life Saving Australia recommends the following safety tips to keep children safe around water:
Supervise: Actively supervise children around water and stay within arm’s reach;
Restrict: Restrict children’s access to water;
Teach: Teach children water safety skills, and;
Respond: Learn how to respond in the case of an emergency.
For more information about Royal Life Saving Australia’s Keep Watchcampaign, visit www.royallifesaving.com.au/keepwatch.
THIS Christmas, Santa’s switched things up and given Australia Post aspecial mission -he’s asked for help in making Santa Mail evenmoremagical!
Instead of relyingonthe usualmailboxmagic, Santa wants kids to deliver their letters in person to their local post office.
It’s awhole newway to send Christmas wishes straight to the North Pole, and Santa can’t wait!
Now’sthe time for littleones to hand-deliver their letters to the post office and receive aspecial response straight from the North Pole.
Eachchild whobringsintheir letterwillleave withareply straight from Santa, along with a special Christmas Pip theKoala ornament -a perfect keepsake to hang on the tree!
To ensurekids receive their magical reply before Santa and his elvesload up the sleigh for Christmas Eve, here’s how the festive fun works:
Write aletter: Kids are encouraged to write aletter to Santa, sharing their Christmas wishes and maybe afew good deeds they’ve accomplished this year;
Pop the letter in asealed envelope, no need for apostage stamp or return address. Santa has enough on his sleigh!
Visit the post office and drop off your letter.
Australia Post Executive General Manager Retail Brand and Marketing, Josh Bannister said the big fella was busily preparing for the festive season.
“Santa has asked for our help this year, and we’re thrilled to be part of the magic,” he said.
“We can’t wait to see the excitement on kids’ faces as they hand over their lettersand receive their reply from the North Pole.
“We hope every child enjoys writing their letters as much as we enjoyhelping Santa maketheir wishes come true.”
For more information about the Australia Post Santa Mailprogram and updates, visitauspost. com.au/about-us/supporting-communities/ literacy-education/santa-mail

Together: Relaying forLifeare St Paul’s Anglican Grammar Schoolstudents Jetson (Year 6), Luka (Year 1), Jack (Year 6) and Emma (Year 6).

Passionate: Walking with purpose areYear 6 students,Evelynand Natasha.
FOR more than 12 hours, St Paul’s Anglican Grammar School Year 6students collectively walked an impressive 27.5 kilometres for this year’s Relay For Life event. The walk raises awarenessand money for cancer research, support and education.
From 9am to 9pm, the Year 6studentswalked thecourse in good spirits, accompanied by other junior school year levels whojoined them for an hour throughout the school day.
In the lead-up to the event, students had engaged in discussions about the importance of the walk, celebrating survivors, remembering those lost and offering hope to those still fighting. Educators encouraged students to reflect on the








Peer support: Suppor ting the Year 6students areTheodore(Prep) and Oscar (Year 4).
personalmeaning of theirinvolvement, promoting the values of resilience, compassion and community support.
Throughthe experience, students also had the opportunity to personalise their learning, setting goals for the walk and supporting their own health andwellbeing.With encouragement from teachers and peers, they persevered through physical challenges such as blisters and sore muscles to walk fora purpose.
The Year 6students’ commitment to the cause and their wellbeingdemonstrated their dedicationto the community and theirgrowth as compassionate, self-aware individuals.

THE state government’s School Breakfast Clubs program served its 50 millionth meal last week.
More than 1000 schools participate in the SchoolBreakfastClubs program, which provides healthy breakfasts, lunches, snacks, and take-home food packs for students and families in need.
It is expected an additional 150schools will join the program by June next year. By June 2026, all government schools in the state will have had the chance to opt in –with the program set to support up to 200,000 students.
The programisdelivered in partnership with Foodbank Victoria.
Schoolsare alsosupporting families to plan and preparehealthy and affordable meals at home,with140 schoolshosting cooking classes for families.
Food provided through the program meets healthy eating guidelines, prioritises fresh and locally produced foods and caters for different preferences, with menu optionsincluding cereals, fresh fruit, soups and rice dishes.
The School Breakfast Clubs program is part of a$287million investment in the Victorian Budget 2024/25tohelp ease cost-of-living pressures for school families.
Families havestarted receivingletters from Victorian Premier JacintaAllan with their $400 School Saving Bonus.
“We know how tough it is for families right now. We’re helping busy families with the cost of living and the cost of learning –serving up 50 million meals so no child goes to school hungry and helping with back-to-school costs withour $400School Saving Bonus,” the Premier said.
The bonus supportsgovernment school students and concession card holders to help with back-to-school costs, and covers uniforms, camps, excursions, textbooks and other extracurricular activities through the year.
The stategovernment has alsoexpanded the Glasses for Kids program into morethan 400 extraschools, providing free vision screening for children in PreptoGrade 3and free glasses for students who need them.
















































BY BLAKE METCALF-HOLT
INEVER thought I’d see the day.
When the finalsiren sounded at Gaskin Park, Churchill on GrandFinal daylast September, signalling apremiership for the Yallourn Yallourn North team Iwas fortunate to be in, arushof emotions and thoughts flowed through my body and up to my head, leaving me lost for words for at least the next half-hour.
Immediately letting out everything you’vepossiblygot left-hands clenched and aroar to the surface.
It’s amixture of joyand reliefthat the jobisfinally done and that the long, difficult road has come to an endwith the ultimate reward at the finishline.
Thecomprehension kicks in that aGrand Final -the biggest game on any footballer’s or sportsperson’s calendar -has ended in your favour, creates those reactions.
In adazelikeI’d been smackedbyacloud of happy gas, calls from your teammates who you’ve gone to war with all season -inthis case the last three years -and Iturn around and immediately sprint into the best group hug imaginable. What feels like the entire club and YallournNorth community treks onto the field. Family, friends and other teammates create aclog that fills an entire pocket of the oval with everyone embracing one another.
Before we head to the podium, let’s put all this into context.
I’m arock chucker, through and through.
Although football wasn’t my initial sport of choice, once Iwas 10-years-old, my hometown and its footy club have been all Iknow and all Icare for (outside family of course).
Icould count on one hand the number of wins I had from my first year of football until Iwas top-age under 14s -and it wouldn’t even be close to five.
As Igot older,Ican’tdeny those years were frustrating -losing like we did was hard, but in the end, it’s the truest thing that you learn more from defeat than you do from winning.
Regardless, you playtobewith your friends, and we had some exceptional parents that backed us in and coached their hearts out.
Once joining the senior club, things began to lift as we lured some school mates over.
That still wasn’t certain. Two weeks before the start of our firsteverfourths (under 16) season, we had three guaranteed players.
It got rolling however, and we played finals for the first time in many of our junior careers, yet bowed out in the first week. It was agreat experience nonetheless.
The next year it was apreliminary final appearance, we were rising at apace faster than Ithought.
It was all coinciding with the seniors jumping back up the ladder over the span of four years, and while tears were shed having our best season to date end aweek too early, it wasn’t all bad as YYN broke a23-year premiership drought in the best grade.
The reserves won the flag and thethirds made the Grand Final, which for many local kids, including myself, was our first time on the big stage.
Smashcut andall of asudden two years had passedwith littlefootydue to somethingwe’d rather forget, and it was now time to step into the big boy’s league.
We now found ourselves in acompletely new league (YYN moved from Mid Gippsland to North Gippsland in 2021),with new opponents to face which made the jump even more daunting.



Still, the reserves were on apathtoglory after winning three flags in four years.
After winning sparinglythroughoutmyjuniors, I had now stepped into asidethat rarely losta game
We were crowned minor premiersin2022and lost the Grand Final in ablowout. That wouldn’t be as scarring as the next year however (I didn’t return in the first year until the decider and only then just snuck in).
We returned the following year anditwas a rematch against our newfound, most hated rivals TTU, and oh how we let that one slip.
Kicking 2.13 (25) in aGrand Final is never going to get it done, and we went down by three points. Come last season and all we were thinking about is how that pain shouldn’t and won’t ever return.
It was aseasonofredemption from each and every one of us.
Another minor premiership meant nothing and after losingthe second semi final by seven points to Woodside,wewent into apreliminary final against guess who? TTU.
It was to be practically two grandfinalsina row, and after abattling first half, we played out of our skin to be beat our rival Bombers and deny them three premierships in arow.
After that, even as early as the Sunday night the week before the Grand Final, Icouldn’t sleep.
You get yourself as right as you can with aweek to go, getting through training, but still the nerves arise, even more so than the last two.
We hadall the confidence to get it done -from
the moment we walked into thosehome change rooms, the energy throughout persisted from the week prior but wasn’t something I’d felt before. Althoughyou’re running through the same warmups and the same drills that have loosened you up all year long, this time there’s added consideration and you’re still heading out onto the ground with all the nerves and as stiff as ever.
The game played out as aGrand Final should -dirty, sweaty, everyone leaving it all out there. It wasn't pretty, but each player had amoment they can be proud of that got us over the line. Flashback to thescenes after the siren andits images and moments that stick with you forever. Simply walking over to the trophy presentation site, surrounded by red, black andyellow–the euphoria and the crowd carry you through.
Hearing your name and number called, walking up on stage, racing back there minutes later after ourcoach does hisbest to articulate all that has come together to bring us to this point in time. Getting to this moment and all that’s around adds up to amost special of occasions.
People I’ve played with, people who’ve believed, people who have been there from the beginning.
Someone like Hunter Paulet,who we’ve been together since the beginning, to win and embrace with him is something else entirely.
To getitdone with familyisanother thing,as your cousin leads us all season long in his first year coaching and to lift the cup at the end, wowee. It’s then time to celebrate knowing you’ve gotten to the top and reaped the rewards, and all that’s left is one thing.
Preseason has now started, and the challenge is to go again next year.

By KATRINA BRANDON
TRARALGON Table Tennis Association (TTTA)has
five new TOPS (tabletop) or beginner coaches ready for action, thanks to arecent visit by Manningham and Table Tennis Victoria coach, John Ind. Coach Ind visited the Traralgon club to teach them how to be decent juniors or beginners coaches, teaching basic table tennis skills and the concepts of group management,organisation, activity safety, and creating an enjoyable training environment. The new Traralgon coaching group includes Heath Spasato, Peter Gomez, Mark Strini, Kerri Thompson and Robert Thompson.
Coach Ind doesn’t have muchhistoryintable tennis, but he comes from amilitary background, where he practised his instructional abilities. He also toldthe Express that his journey into teaching table tennis started when the Manningham club asked if anyone in the club was interested in taking up coaching.
“I got into coachingbecause, at my club, the coach asked quite afew of us if we would like to do coaching, so we all said yes,” Ind said. “We were all doing this course (TOPS) here, but
B: AaronFawcett (Hill End), Lucas Towns (Morwell East), Jack Hayes(Fish Creek); HB: SamWilson (MDU), TomRober tson (Yinnar), MattWilliams (Tarwin); C: Ben Cheffers (Yinnar), AnthonyRosato (Thorpdale), Dylan Williams (Foster); HF: LukeCheffers (Yinnar), Darcy Berryman (Fish Creek), Brendan Mason (Boolarra); F: Jake Best (Foster),Chris Wangman (Morwell East), Nathan Wheildon (Newborough); FOLL: Isaac Abas (Morwell East), Tom Buckley(Fish Creek), Brad Kimberley (Morwell East); INT: Josh Tolner (Foster), James Morris (Foster), Jack Weston (Toora), Chris Verboon (StonyCreek); Coach: Jarrod Walker (Fish Creek); Captain: Lucas Towns (Morwell East); Vice Captain: AnthonyRosato (Thorpdale).
Goalers: Skye McDonald (Yinnar), Brylee Angwin (Foster), Jess Edgar (Fish Creek); Midcourt: Lisa Yates(Yinnar), KirraJones (MDU), MollyEdwards (Fish Creek), Jaime Chila (Yinnar); Defence: KelseyAngwin (Foster), Gabby Maynard(Yinnar), DanniDunn (Morwell East); Coach: Skye McDonald (Yinnar).
he (the coach) passed away before that, so Idecided to step in.After completing the TOPS course, Table TennisVictoria sawsomethinginmethat they didn’tsee from the normal coaches coming through BeforeIknewit, theyplaced me on the Level 1and Level2courses, the international Level1,and the instruction that Idofor the TOPS Course and the Level 1iswhatour aim was, in the long run, to get me involved.
“It wasn’t because Iplayed table tennis. It was because Icouldinstruct and teach people andmake them comfortable.”
The first course that coach Ind taught in 2018 happened to be in Traralgon.The TTTA is home to auniquepiece of equipment that seems mundane to some. Theitem is aballpicker and wire that helps pick up balls. While Ind’s version is ‘2.0’ with an additional stick to get balls from under the table, Ind said he was wrapped to returntoTraralgon to seehow much has changed.
From 2018 to now, Ind has taught about 80 coaching courses, whether TOPS/beginner, Level 1and Level 2. Ind is aLevel 3coach who has coached all over. He also told the Express that most who attend his course find his methodsdiffer from what other coaches are used to.
During the course at Traralgon, the new coaches practiced sessionplanning,basic techniques, multiball skills and practicalcoaching. The coaches also underwent assessments to see where their skills were.
During the sessionplanning assessment, coaches were to plan a50-minute lesson with beginner-level students. The lesson plans included the level of players, how many they would be coaching during that lesson,whatequipment they would need, location (such as aschool or at the association), warm-up activities, askill developmentsection, games to improve those skills, and acool-down. Each coach then had to demonstrate the lesson plantothe group, which tested the educator’s

communication, teaching ability, and organisational skills. The lessonplan criteria showed suitable goals for the training lesson andappropriate warms/cooldowns.
During the TOPS coaching course, coaches also underwent amultiball demonstration and performance, each demonstrating direct and indirect multiballing techniques. Coach Ind helped both coaches improve their techniques along the way and showed them ways to improve their coaching multiball skills,whether it be speed, placement, or general technique.
Coach Ind also recommended that coaches get a first aid certificate to help them know what to do
whenastudentgets injured. During the course,Ind reviewed safety measures and dangers to look out for around the court, such as what type of dividers are used (ifnet, that it isn’t aslippinghazard)and that students and coaches should never go under the table for aball. Instead, there should be tools around courts to help retrieve balls.
Coaches received aTable Tennis in Schools program book at the start of the course, where coaches cangobackthroughthe material for inspiration or just general needs before the lessons. The booklet covers general stuff such as bat grips, serving rules, games, and astep-by-step of multiple techniques.
FOOTBALL
NEALE Daniher has been nominatedfor Australian of the Year.
The father of current Moe Football-Netball Club senior footballer Ben Daniher, Neale Daniher will represent Victoriainthe Australian of the Year Awards in Canberra next year.
Neale DaniherAOhas thanked his tight-knit family, supportive friends and his FightMNDcolleagues after beingnominated as the 2025 Australian of theYear for Victoria, recognised with astanding ovation for his relentless andselfless workwith FightMND, and his very public battle with what he calls ‘the beast’.
The co-founder and patron of FightMND has been inspiring Australians with ice-slides and blue beanies for more than adecade, helping deliver over $100 million into research to find acurefor motorneuronedisease and carefor those living with MND.
Neale wasdiagnosedwith the debilitating disease in 2013 and together with the late Dr Ian Davis OAM and Pat Cunningham(who’s wifeAngie was living with the disease) formed what would become FightMND, acharity that has changed the landscape in awareness and funding around MND.
Even in his advanced stages, Neale has never shied away from the public eye and with his courage and unstoppable drive remains dedicated to deliveringhope, and eventuallyacure, for everyone living with MND.



He can be spotted at Ted SummertonReserve from time to time during footballseason, watching MoeLions play.
Moe FNC also holds an annual FightMND fundraiser,featuring locals dunking their heads under water for the cause (much like the annual ‘slide’ event at the MCG on the King’s Birthday).
“While it is not the reason we do what we do, on behalf of my wonderful family Iamhumbled and honoured to be named as Victoria’s Australian of the Year,” Neale said.
“As atight knit family, together we have taken on Motor Neurone Disease, and Iamsoappreciative of the emotional strength of my steadfast wife Jan and children Lauren, Luke, Bec and Ben and their partners. Their enduring guidance, and unwavering support has allowed me to maintain my battle against ‘the Beast’.
“My nomination is also anomination for everyone who has been impactedbythis insidiousdisease and allows us to appreciate that this fight is not yet over and continue ourfocus on thesearch for acure.
“It is aprivilege to be recognised amongst this group of amazing and inspirational Victorians whose talents and efforts were identified as our state’snominations for 2025, and Icongratulate my fellow nominees Madeleine Buchner OAM, Professor Deborah Cheetham FraillonAOand Wayne Holdsworth on their achievements and will look to watch on as theirefforts continue to unfold.”
The recognition of Neale’samazing efforts comes just ahead of FightMND’s announcement for the 2024 research cure and care grants, with universities andinstitutes in every state in Australia set to receive funding as the search continues for acure.





























“



The Range Retirement Village are ong time clients of the Latrobe Valley Express and have always enjoyed a great relationship with Jenny and her team in the advertising department


Theyalways go outoftheir waytomake sure our company has the best advertising for our business,always looking forwaystoimprove our ads, so we achieve the best results.
We recommend theLatrobe ValleyExpress to anyone looking to promote and advertise their business.

“ gets


LeighBrown

The Range Retirement Village l g
e













By BLAKE METCALF-HOLT
AIMING high, fighting through and taking it out.
Trafalgar East’s Izzy Grylls recently won gold at the Australian WeightliftingNationals, after lifting97kgtobenamed championinthe youth women’s 76kg category.
Grylls faced an uphill battle attempting an 80kg snatch, for which she was unsuccessful and settled for a76kg. Her opponent, Indianna Wilson lifted an 82kg, meaningGryllshad to go seven kilos heavier than that in the clean and jerk section. Before goingahead into the decisiveperiod, Grylls spoke about her mum taking her aside and keeping her steady in acritical moment.
“I feltabit of pressure fromher (Wilson)because she’s quite strong in the snatches, mum just took me out of the warmup room, she took me outside, she like reset me, we had atalkabout it andthen Icame back in to the warmup room and Iwas just ready to go,” she said.
“I just wanted to win, Iwanted to hit my numbers Ineeded to hit, (and) Ijust wanted to beat her.”
Grylls did just that,and ultimatelycompleted thecomebackwith arecord-breaking clean and jerk and total lift over 173kg.
“When Idropped the 97(kg) after Ihit the lift, it was apretty amazing feeling… I’m so glad to get the win, it was pretty good,” she said.
Grylls’ passion for competition arose from her mother and fellow weightlifter, Bonnie GryllsGraham, who was trained by national weightlifting coach Miles Wydall.
Aspontaneous occasion where Wydall travelled down from Queensland and took alikingtoGrylls has now seen both mother and daughter trained under him.
“He came down for aworkshop whenmum was lifting before Iwas lifting, and Iwas doing cheerleading at the time and Iwas in the back room just doing backflipsand just like basically flipping around,” Grylls said.
“Then Miles, my (soon-to-be) coach, he was like ‘can she squat?’ and then (he) basically taught me how to do the fundamentals.”
Taking up weightlifting at age 14, but given there isn’t many local clubs surrounding Gippsland,
Grylls was lucky to have her mum being more than familiar with the sport, so she had the ability to train in aweightlifting room attached to their home gym.
Finding her footing, Grylls usually trains by herself, but on the weekends and whenshe doesn’t have school, is tutored by her mum.
Gryllssaidher mum is supportive with allthe little things that go towards her goals, which includes keeping her focussed outside of the gym.
In terms of training in preparation for agold medal, following a14-weekprogram fromcoach Wydall is what it takes, according to Grylls.
“There’s normallythree weeks of heavy training and aweek of deload, which is justlike lightweights so your bodycan likerest and recover,” Grylls said.
Prior to winning gold, Gryllsalsocompeted at the Commonwealth Championships in Suva, Fiji where shefinishedsecondinthe youth women’s 76kg with atotal lift of 172kg.
Grylls now has her sights set on preparing herself and qualifying for the World Weightlifting Championships taking place in Lima, Peru next year
MORWELL Croquet Club has been very active.
At the start of the month, the club held its golf croquet tournament under sunny skies.
Participants hailed from neighbouring Gippsland clubsbut also travelledfrom as far afield as Orbost, Rosebud and Sorrento.
The competitionwas dividedinto two blocks and was hotlycontested, with thewinners of both blocks separated by the narrowest of margins.
Winners were:Division 1- PGoldstraw/D Lebbon (Sale), runner-up: TLacey/S Baker (Wonthaggi). Division 2- BMoir/I Fasham (Rosebud/Sorrento), runner-up: DEdwards/R Scott (Traralgon).
In mid-October, Morwell Croquet Club hosted the 1st Yinnar Scouts.
Ahigh tea evening was organised by one of the

By STUARTMORROW
PLAYERS took to the court for the first all abilities basketball tournament certainly in Gippsland, if not Victoria, as part of the Latrobe Valley Hoopla Masters Basketball Tournament.
The event wastobeheld at the Moe/Newborough Rec Centre,but was moved to Sale at the Gippsland Regional Sports Complex.
Thirteen men’sand ladies masters teams ranging in age from 30 to 72 participated. In the AA Division,WildcatsBlacktook on Wildcats White.
For all AA players, it was the first time they had ever worn auniform.
All players were individually announced on to the court, giving them ahugebuzz.
The standard of the two games played was impressive -the shooting and scoring incredible.
The WildcatsMasters Clubintends to run a midweek event at GRSConTuesday,November 26








THE state government is investing millions across the state to upgrade and build new local sports facilities.
Ministerfor Community Sport, RosSpence announced applications are now open for the RegionalCommunity Sports Infrastructure Fund (RCSIF) and the 2024/25 Local Sports Infrastructure Fund (LSIF) to help local communities plan, designand build the sport facilities they need.
Thefour funding streamsinthe Regional Community Sports Infrastructure Fund willhelp regional communities plan and build everything from indoor stadiums and aquatic facilities,upgrades for womenand girls, community facilities, and infrastructure and planning to encouragepeople from all abilities to get involved.
Additional grants of up to $50,000 are also availablethrough the Regional Community Sports Infrastructure Fund to help boost participation for people with disability at the new or upgraded facilities
The RCSIF is backed by the Regional Community Sport Development Fund and the All Abilities Sport Fund and since the first round of the program opened has invested more than $20 million in 26 projectsacross thestate.
Through LSIF, metropolitan councilscan apply for funds towards arange of community sports infrastructureand active recreation projects including sports courts, lights, change rooms, playgrounds, skate parks, to benefit local clubs and communities.
The fund has three funding streams including community facilities, community sports lighting, and planning.
Bothfundsare now open. LSIF closeson February 17, 2025 and RCSIF on March 17, 2025. For more information about the funds or to apply, visit: sport.vic.gov.au/funding



























































































































































































NUGGIES Roofing and Plumbing areafamilyowned and operated roofing and plumbing business with morethan 30 yearsexperience specialising in metal roof installation and re-roofing
Based in the Latrobe Valley, the team at Nuggies can re-roof your house and provide general plumbing around the Latrobe Valley and beyond.
Aroof maybeafunctional proper ty of ahome,however your choice of materials and colourscan also completelychange the style, making it astandoutfeature. A professionallyinstalled newroof will increase the valueofyour asset. Nuggies Roofing &Plumbing has afull rangeofstyles and profile to choose from and can offeradvice and examples to help youdecide what’sright foryou.
The team at Nuggies has awealth of knowledge and experience and areabletoget the job done on time.Theypride themselvesondelivering topqualityroofing and plumbing services and include the supplyoftheir ownhandrail, scaffold and safety harnesses to ensurethe safetyof their team
Nuggies continue to work closely






































































































































































































































Landscaping Mulch
Beautify your garden. Bulk quantity available, $30m3, $50 delivery. 0412 613
Price: $6 each or 2for $11 (GST incl).
Enquiries: 5135 4444
Angus, Limousin, Jersey, Hereford and Friesian, very quiet. 0447 331 762.
Hens for sale, 12 mths old, $15 each. Also POL's $30 each. Can deliver. Phone 0409 136 985.

LABRADOR p/bred black pups, 11 wks, 2females, wormed, vaccinated, m/c 9781420003319 18/2005, S/No. MB248403 $1000. Ph 0499 297 555.

7Albert St, Thursday 21 and Friday22ndNov 9am-5pm. Assorted items. MOE, 17 Bristol St, Sat. 9am -1pm. Houseware, clothing, beach/fishing goods, BBQ 4burner with Rotis bottle and cover, plus outdoor furniture.





















































Planningand Environment Act1987
LATROBE PLANNING SCHEME
Notice of the preparation of an amendment to a planning scheme Amendment C143
Overview
The amendment proposes to apply the Public Acquisition Overlay (PAO) to part of 11 properties in Newborough, part of 11 properties in Morwell and part of 1 property in Traralgon. The amendment is required to reserve land identified for ‘Road projects’ and/or ‘Drainage /Open Space Reserves’ projects in the Lake Narracan Development Contribution Plan (Newborough), the Morwell North West Development Plan and Development Contributions Plan, or the Traralgon North Development Plan and Development Contributions Plan. The Amendment also makes minor changes to Clause 72.03 (What does this scheme consist of?) to include updated map referencesand Clause74.01 (Applicationofzones,overlays and provisions) to outline how the Public Acquisition Overlay implements the MunicipalPlanning Strategy.Applying the PAOtothe identified properties will, in the long term, allow Latrobe City Council to compulsoryacquirethe reserved land to deliver infrastructuretosupportLatrobe’s growing towns.
Forfurther details, refer to the explanatoryreport about the amendment
Details of the amendment
The Latrobe City Council planning authority has prepared Amendment C143 to the Latrobe Planning Scheme.
The land affected by the amendment is:
1Thompsons Road,NEWBOROUGH, 1\LP142353
3Thompsons Road,NEWBOROUGH, 2\LP142353
10 Thompsons Road, NEWBOROUGH, 6\LP157245
5Hayes Road, NEWBOROUGH, 1\LP126050
Links Road, NEWBOROUGH, 2\PS636142
18 Thompsons Road, NEWBOROUGH, 1\TP594736
18 Thompsons Road, NEWBOROUGH, 1\TP248759
20 Thompsons Road, NEWBOROUGH, 3E\PP3273
22 Thompsons Road, NEWBOROUGH, 3H\PP3273
25 Thompsons Road, NEWBOROUGH, 1\TP582048
25A Thompsons Road,NEWBOROUGH, 2\TP582048
710John Field Drive, NEWBOROUGH, 34\LP121048
130Latrobe Road, MORWELL, 70E\PP3072
140Latrobe Road, MORWELL, 70D\PP3072
150Latrobe Road, MORWELL,70C\PP3072
160Latrobe Road, MORWELL, 70B\PP3072
25 English Street ,MORWELL, 70L\PP3072
40 English Street ,MORWELL, 1\TP211967
55 English Street ,MORWELL, 14\LP11865
65 English Street ,MORWELL, 70H\PP3072
23 Jason Street ,MORWELL, 1\PS404523
77 Ashley Avenue, MORWELL, 19\LP111605
Heritage Boulevard, MORWELL, H\PS739559
50Glendale Road, TRARALGON, 1\PS329021
The amendment proposes to:
Inserts Planning Scheme Map No.s 24PAO, 25PAO, 30PAO, 50PAO, 71PAO, and 76PAOtoapply the Public Acquisition Overlay (PAO2 or PAO3) to the 23 identified properties.
Amends the Schedule to Clause 45.01(Public Acquisition Overlay) to make:
Latrobe City Council the Acquiring Authority for the PAO2 with the purpose of the acquisition as ‘Roadprojects’
Latrobe City Council as the acquiring authority for the PAO3 withthe purpose of acquisition ‘Drainage /OpenSpace Reserves.’
Amends the schedule to Clause 72.03–Whatdoesthis planning scheme consist of? to reference 24PAO, 25PAO, 30PAO, 50PAO, 71PAO, and 76PAO.
Amends the schedule to Clause 74.01–Application of zones, overlays and provisi ons to outline how the Public Acquisit ion Overlay impleme nts the MunicipalPlanning Strategy
Youmay inspect the amendment ,any documents that support the amendment and the explanatoryreport about the amendment ,freeofcharge, at: Th eD epa rtment of Trans port an dP la nnin gw ebs it eh tt ps :// ww w. pla nnin g. vic.gov.au/planning-schemes/amendments/amendments-on-exhibition or by contacting 1800 789386 to arrangeatimet oview the amendment documentation.
The Latrobe City Council website at www.latrobe.vic.gov.au/C143. During office hours, at the office of the planning authority,Latrobe City Council Corporate Headquarters141 CommercialRoad, Morwell; Churchill Service Centre9-11Philip Parade, Churchill; Moe Service Centre1-29 George Street Moe; andTraralgon Service Centre34-38 KayStreet ,Traralgon.
Any person may make as ub mi ssion to the planning author ity about the amendment .Submissions must be made in writing giving the submitter’s name and contact address, clearly stating the grounds on which the amendment is supportedoropposed and indicating what changes (if any) the submitter wishes to make.
Name and contact details of submitters arerequired for the planning authority to consider submissions and to notify such persons of the opportunity to attend planning authority meetings and any public hearing held to consider submissions.
Theclosing date for submissions is 5pm 23 December 2024. Asubmission must be sent to the Latrobe City Council PO Box264,Morwell Victoria 3840 or via email latrobe@latrobe.vic.gov.au.
The planningauthority must make acopy of everysubmission availableatits office and/or its website for any person to inspect free of charge until the end of the two months after the amendment comes into operation or lapses.
G
STEVEN PIASENTE Chief Executive Officer
Looking for a lifestyle change? Wanting to be your own boss?

Jim's Mowing is looking for aFranchisee in the Latrobe Valley area. CONTACT 131 546 For ano-obligation free Info Kit
Vacant •
Delivery Drivers Delivery drivers required for early morning paper deliveries in the Traralgon area. This is acontract position. Must have own car and mobile phone. Must be avail. to work 7days. Please phone 5174 1806 or email resume to; sales@seymour stnews.com.au



























Would you like to deliver the Latrobe Valley Express newspaper to individual homes on Tuesday and/or Wednesday afternoons in Morwell, Traralgon, Moe, Newborou gh and Churchill? Please apply to the Circulation Manager 0456 000 541. Please note: Children must be 11 years or over as we will need to apply for agovernment Child Emplo ym ent Pe rmit Children younger than 11 cannot or will not be accepted. Adult deliverers also welcome.
PLEASE NOTE:
Much hardship and difficulty is caused to job seekers by misleading advertising placed in the employment columns.
Our Situations Vacant columns are reserved for advertisements which carry aspecific and genuine offer of employment. Ads for `Business Opportunities' and `Training Courses' and `Employment Services' should be submitted under those headings. Placing misleading ads is an offence against the Trades Practices Act and state/territory fair trading acts and all advertisements are subject to the publisher's approval. For further advice, contact the Australian Competition and Consumer Commission on 1300 302 502 or your state consumer affairs agency.
Does your current marketing hit the correct audience?





FORD Fairmont Sedan, '93, auto, cardinal red, garaged, reg. till 19 Jan 2025, FFM-088, 6cylinder, approx 125,000kms good cond. $4,000 ono. 0402 348 914.
HOLDEN, 1982 Deville Statesman, rebuilt back to new $60,000. No rust, no bog. Make an offer. Phone 0434 913 630.
Sprinter van, 2003, manual, high roof, 280,000km, 3 seater, g.c. r.w.c. $11,500 o.n.o. Ph 0475 088 025.


JAYCO Conquest FD20.1, Fiat Ducato, '13, 2.3L diesel, 65,000km, generator, d/batts, 3-way fridge, extra solar, large storage box (rear), reg. 2/25, 1UG-1YU
$89,500. 0402 140 919.
2007 Tray, Manual, Good Cond., Reg 1XX7GF $7,000. 2wheel drive. Ph 0466 399 576.
RENAULT Laguna 2002, silver, 2L, 191,000km, drives well, excellent throughout, ready for r.w.c. RXB-453 $3800 o.n.o. Ph 5633 2492.
Minimum 6lines$60 without aphoto or $74withacolour photo
0418 336 238, 5623 4782.

Total of 4consecutive editions in the Latrobe Valley Express and 4editions of the Gippsland Times paper THEY DO SELL!
DRIVE YOUR DOLLAR FURTHER Cars and Caravans are in demand

REQUEST FOR TENDER
Council is seeking submissions from qualified companies/applicants for the following: RFT/376 -Mirboo North Early Learning Centre Concept Design
Tender closes 2pm AESTon Tuesday, 10th December 2024.
Documentation is available from Council's e-Tendering Portal www.southgippsland.vic.gov.au/tenders Tenders

LCC-859 Roof Replacement (Court 9)
Gippsland Regional Indoor Sports Stadium, Traralgon
Tenders are invited from suitably qualified contractors for the above. See www.latrobe.vic.gov.au/tenders for details.
Submissions are to be lodged as detailed in the documentation. Council is not bound to accept the lowest or any tender.

Council is seeking submissions from qualified companies/applicants for the following:
RFT/419 -Fish Creek Streetscape Tender closes 2pm AESTon Tuesday, 17th December 2024. Documentation is available from Council's e-Tendering Portal www.southgippsland.vic.gov.au/tenders








Thanks •
Thank you to the 2ambos and 2 MICA guys who worked on me on Cup day morning.
Thank you!
AITKEN (Potter), Wilma Joyce. Passed away peacefully at Maryvale Hospital on 16 Nove mbe r2 02 4, surrounded by her loving family. Aged 93 years
Loving wife of Stan (dec.). Loved and loving mother to Ross, Barbara, Robyn and Leigh.
Adored nan to Tim and Brooke, Jaime and Terri and Kim and Matt. Cherished great-nanny to Summah, Maicy, Archie, Leo, Jack, Lachlan and Mitchell.
You were someone special, someone loving and true, You will never be forgotten, we all adored you.
Thank you for being a caring, loving and generous Nan. We were so blessed to have shared so many memories and milestones together.
Always loved and always remembered Love Kim, Matt, Lachlan and Mitchell.
Loving mother of Ross and Barbara. Mum you were the best! Ever caring, ever loyal, ever generous. Treasured memories and loved forever Love Ross and Barbara.
Cherished memories of our beautiful Nan. Gone but never forgotten and always in our hearts Jaime, Terri, Summah and Maicy.
Nan, we love you so much and will miss you everyday. Love Tim, Brooke, Archie, Leo and Jack.
BUCKNALL, Florence (Mollie).
10/3/1933 to 17/11/2024 Passed away peacefully at Margery Cole Traralgon. Mother of Kerri, Peter, Andrew (dec.), Rachael, and Colin. Mother-in-law of Jim, Anton, and Atik. Nan to Stella, Arlyn, Oscar, Leah, Poppy, and Chloe. Great nan to Chase and Julian, Odin and Autumn. Thank you to Waratah staff for their wonderful care of Mum.
Rest in Peace Mollie Private Cremation Held

MOE-MORWELL-TRARALGON TRARALGON 5174 2258 Place your tribute on latrobevalleyfunerals.com.au

DEAN (nee Saunders), Margaret Gwen. 12/3/1927 -17/11/2024. Great Gippsland girl gone to God. One of akind, a force of nature. Margaret was alegend in her own lifetime. Fiercely loved and loving fierce. Beloved of her gentle Greg. Devoted mum of Helen, Cathy, Fiona and Robert. Matriarch of afabulous clan. Loyal friend to many. Go well brave heart
FENECH, Carmel (Charlie). Passed away peacefully at his home in Churchill on 13 November 2024. Aged 73 years Dearly loved and loving husband of Agnes. Much loved father of Roy and Joan. Adored Nannu to his grandchildren.
GREAVES, Ian.
We are deeply saddened to announce the passing of Ian Greaves. Beloved father to Georgina, Quinton, and Martin, and father-inlaw to Grant, Simone, and Jae-Lee.
Much-loved Poppy to Blair, Cooper and Riley, Keeley and Hunter, Taj and Oceanna, he brought endless joy and warmth to their lives.
Dad/Poppyyou will be deeply missed, forever loved, and never forgotten
HARDAKER, Marlene Lorraine 23/1/1941 -17/11/2024. Dearly loved wife of Robert. Mother of Naomi, Simon and Jana and their families.
JARICH, Anton (Tony).
Such ashort time we spent together but it was a privilege knowing you. We shall miss your presence and voice in the choir. God Bless you Tony From all that sing in the 'Friends in Song' Choir. Be at peace
KAROUSSOS, Dimitrios (Jimmy).
Born 23 June 1947, Passed away 10 November 2024. Aged 77 years Passed away suddenly at home in Traralgon. Dearly loved and loving husband of Jenny (dec.). Much loved father and father-in-law of Maryanne and Craig and Simon and Kelly. Adored Grandpa to Lucas, Josh, Will and Isabelle. Beloved brother, brother-in-law and much loved Uncle. Your love will liveon in our hearts forever
LEE, Robert George (Bob). Peacefully passed away 7/11/2024.
Dearly loved husband of Claire. Wonderful father to Phillip, Karen and Denise. Loving grandad to Alana and George, Ben and Kyle (dec.), Abby and Jake. Much loved friend and helper to many. Safely resting in God's Memory
LEE, Robert (Dad). 7/11/2024. Atruly wonderful, gentle Dad who gave much love. We will hold fast to the many treasured memories, until the time of the res urrect ion, promis ed and demonstrated by Jehovah and Jesus (John 11:11-44).
Looking forward to real hugs then Karen.
oooOOooo
The best Grandad and teacher of all things mechanical and collectable (LOL). Thankful his passing was peaceful. Awesome Memories Always Ben.


NAPIER, Helen Margot. 8/4/1932 -13/11/2024. Passed away peacefully at DalkeithGardens, Traralgon on 13/11/2024. Aged 92 years
Much loved wife of Ron (dec.). Mum to Darren and Janet. Nanny (Goat) to Alana, Kayla and Jemma. Great Nanny to Lucas. Loved by Liz and family. "Listen"
You were such an independent woman, so determined and would often say "I can do it". Often we would find you scratching around in the garden raking leaves and tidying up. You loved your family and meeting your great grandson Lucas made you smile so bright. Sleep peacefully mum Bye for now
Love you, Darren and Janet.
NOBLETT, Robert (Nobby). There's agift in life you cannot buy, It's very rare and true, It's aspecial gift of friendship, That you and Iknew. As children we grew together, As adults went separate ways, But it broke my heart, The day you went away. Lifelong friend of John and Lynne Presley. Rest in peace, you will never be forgotten
NOBLETT, Robert (Nobby). Afriend of fifty years. The hardest part of great friendship is having to say goodbye. We have many funny and happy memories of our time with you. Thank you for being our friend.
We will miss you, Nobby The M's.
NOBLETT, Robert Darcy. Nobby, as he was known, lived next door to our family for 56 years. During this time we shared the growing up of family, good times, laughter and sadness. Through these years the family has grown to have families of their own. It is with asad heart that I send them lots of love and share their loss. He will not be forgotten Norma Tyrer and Gillian.

FENECH. Requiem Mass for the Repose of the Soul of Mr Carmel (Charlie) Fenech will

VARY, Brian Andrew. 14/2/1943 Morwell5/11/2024 Perth. Loved husband of Helen. Loving father of Rebecca and Andrew. Father-in-law of Kaori.
Loved grandfather of Erika and Louis.
Respected and loved brother and brother-in-law of Judy and Gary Surman, Des and Vera Vary and Kathleen Thomson. Loved uncle to all his nieces and nephews. Respected friend of your Japanese and Chinese business associates.


AITKEN. The Funeral Service to celebrate the life of Mrs Wilma Joyce Aitken will be held at the Gippsland Memorial Park Rose Chapel, Cemetery Drive Traralgon on THURSDAY (21 November 2024) commencing at 10am. At the conclusion of the service the Funeral will leave for the Traralgon Cemetery, Gippsland Memorial Park, Cemetery Drive, Traralgon.

MOE-MORWELL-TRARALGON
TRARALGON 5174 2258 Place your tribute on latrobevalleyfunerals.com.au
DAMBRAUSKAS, Mavis Joyce. The funeral service for Mavis will be held on THURSDAY (21 November 2024) at 2pm at the Rose Chapel, Gippsland Memorial Park, Traralgon.

The Funeral Service to celebrate the life of Shirley


KAROUSSOS. Funeral Service of Dimitrios 'Jimmy' Karoussos will be held at the Greek Orthodox Church Morwell, 42-44 Elgin St, Morwell on THURSDAY (21 November 2024) commencing at 12pm (midday). At the conclusion of the Service the Funeral will leave for the Traralgon Cemetery, Gippsland Memorial Park, Cemetery Drive, Traralgon. Jimmy's Service will also be livestreamed. To view the livestream please visit our website.

of
The
(Bob)
will be held at Latrobe Valley Funeral Services Chapel, 6Ollerton Avenue, Moe MONDAY (25 November 2024) commencing at 1pm. At the conclusion of the Service the Funeral will leave for the Willow Grove Cemetery. Bob's Funeral Service will also be livestreamed, for details please visit our website: latrobevalley funerals.com.au

MOE-MORWELL-TRARALGON
NAPIER. The Funeral of Mrs Helen Margot Napier will arrive at the Boolarra Cemetery, Barktown Road, Boolarra, TUESDAY (26 November 2024) for aGraveside Service to commence at 11am.


























ROGAN, Debbie. 30/3/1973 -22/11/1993. Each day you are loved, remembered and cherished in our hearts. Love Mum, Dad, Alison, Paul, Darcie and Kaylah.
LEVISTON, Peter Robert. Angela, Catherine, Caroline and James would like to express our sincere gratitude to everyone for the kindness and support shown to us on the passing of Peter.
We wish to thank everyone who attended Peter's funeral, those who travelled distances or watched on livestream. The flowers, cards, food, visits and messages were greatly appreciated. We thank Cabrini Hospital, Latrobe Regional Cancer Care Unit, Latrobe Community Palliative Care Services and Maryvale Private Hospital for the compassionate care shown to Peter. We would also like to extend our appreciation to the many people who supported Peter with visits and phone calls over the past three years. We wish to thank Latrobe Valley Funeral Services for the professional and caring support provided to us during this time and in particular Myra Krafft, Gary Drinken and Carly Maling.
















When you losesomeoneclose to you, it can be hardtoput yourthoughts and feelings into words Placeyour personal messageinthe Latrobe ValleyExpress and share your memories
To place your message today contact Classifieds
When you lose someone close to you, it can be hard to put your thoughts and feelings into words A personal message in the Latrobe Valley Express can say so much All notices placed in print also go in our digital edition For friendly advice on how to place a message contact



































BOWLS
STRZELECKI NORTH
WEEKEND PENNANT
BY MICHAEL HOLROYD
ROUND 6ofWeekend Pennant continued with muchhotter conditions and allgreensrunning quite quickly, leadingtosome bigwins and surprise upsets in some matches.
Drouin continued their good form with astrong win at Traralgon RSL in Division 1, despite the home rink of Beau Williamson together with Garry Trewin, Chris Mackintosh and Maurie Sutcliffe, winning 25 to 15.
This was not enough to beat the visitors, with abest rink of Gareth Richand his team of Alex Miller, together withJan and GraemeAubrey winning24-17, along with the winning rinks of Col Jeffrey and Les Firth.
Morwell got back on the winner’s list with an upset victory at Newborough against Longwarry. Danny McKeown and his rink of Abbas Mehran, Alex Monroe and Keith Gadsby won 30-20 along with winning skippers John Osborneand Brian Kingsley.
Trafalgar had anarrow win at home against Warragul, withNathan Cookand his rink of Sean Tatterson,Paul Dawson and David Cookwinning 29-22,leaving Trafalgar the winners by five shots.
Traralgon maintained top spotonthe ladder after
defeating Newborough at home, with Ian Kirkup and his rinkofPat Trewin, Abe Roeder and Trevor James winning 29-16 as they won by 18 shots.
DIVISION 2 saw Moe have amammoth 109-shot win against Thorpdale, with Michael Smogavec and his rink of Fred Martin, Lachlan Sim and Jayde Leech winning 57-3 in one of the biggest rink wins in recent history.
Traralgon (2) was too strong at Neerim District, winning by eightshots with the rinkofGraham Cross together with Dick Glossop, Ken Mooney and David Currie winning 23-13.
Traralgon (3) had astrong win at home against Traralgon RSL (2) with Roger Davey and his rinkof Barry Fernance, Jason Irvine and Max Cumming winning28-12, whilst for the RSL, Max Gibbins and his rink of JeffBaldwin, Duane Pendlebury andPaul Hobson won 25-12.
Morwell Club won all rinks at Garfield, led by TaraHarle and herrinkofJoLeslie,Vaughan Reimers and Roger Reimer winning 23-10.
DIVISION 3 has Boolarra perched atop of the ladder. Boolarra won by 68-shots against Trafalgar (2) with Chris Ward and his rink of Tony Snell, Colin Brick and John Cargill winning 39-9.
Morwell (2), with Ken Turner and his rink of Pauline Betteley,John Bradbury and Bob Wilson winning 30-13 had a14-shot win against Newborough (3).
Moe (2) defeated Newborough (2) by one with the home rink of Jeff Wetzel, together with Michael Holroyd,Carmel Goss and Joan Goldie winning 35-22. The visitor’s skippers Ian Caines and Paul Read won 23-13 and 22-18.
Drouin (2)had abig winathome against Yinnar with TerryMcFadzean and his rink of Ron Douthie, Dini Hone and Rudy Kerkvliet winning 31-6 and Andrew Kidd winning 32-11.
DIVISION 4 saw Traralgon (4) have a15shot win against Yallourn North. Ian Wills and his rink of Maureen Rooney, Len Rawlings and Cheryl Reynolds won 25-13.
Warragul (2) had a42-shot win over Churchill, with David Gatewood winning 25-10 and Brent Grigg 33-8.
Yarragon won all rinks against Neerim District (2), with Richard Polmear winning 31-9 and Jason Roberts 33-10.
Longwarry (2) had abig winathomeagainst Morwell (3).
DIVISION 5 led with Morwell Club (2) having a23-shot win over Garfield (2). Traralgon (5) had a21-shot win over Yallourn North (2). Warragul (3) had a21-shot win over Drouin (3). Trafalgar (3) had a50-shot victory against Morwell (4) and Traralgon RSL (3) had asix shot win over Boolarra (2).
DIVISION 6 results were: Newborough (4) defeated Longwarry (3) by 20 shots, Moe (3)
BOWLS STRZELECKI NORTH MIDWEEKN PENNANT
BY MICHAEL HOLROYD
MIDWEEKPennantbowls continued Tuesday, November 12 after aweek off for the Melbourne Cup holiday.
IN Division 1, Warragul had asix-shot victory at Traralgon RSL, with Margaret Ratcliffe and her rink of Russell Carrick, Bill Clappers and Pat Hammond winning29to17.
Newborough won 22-15 at home over Moe, with SherylAtkinsonand herrink of Maureen Leighton, Tony Knipping and Alan Ryan winning.
Trafalgarmaintained their unbeaten run with allrinks up at home against Drouin, with David
Cookand his rinkofShirleyMelsen, Pat Tatterson and Noel Rubenstein winning 24-12.
Traralgon, at home, had asolid win over Morwell Club, with Wayne Barnesand his rink of Clint Jones, Graham Cross and BillKirby winning 26-10
DIVISION 2 sawNewborough (2) have a12shot win over Morwell at Traralgon, with Julie Jackson and her rink of Glenys Perkins, Carmel Goss and Jeff Wetzel winning 29-17.
Drouin (2) won by 11 shots against Trafalgar (2). Yinnar won by 69 shots against Morwell Club (2), with Tom Rocheand his rink of RobertHooper, Liddy Davidson and Ray Tanti winning 47-8.
NeerimDistricthad another big win at home against Traralgon (2) despite May Cross winning 28-14for the visitors, only to be beaten by three shotswith Pat Fraser-Aurisch winning 23-16 and Karren Sheers winning 21-11.
DIVISION 3 led to Churchill having a13shot victory over Drouin (3), with Graeme Drury winning 24-14.
Traralgon (3) won all three rinks in a27-shot win over Yarragon with Ian Wills winning 25-9. Newborough (3), with only the rink of Peter Policha winning 30-10, defeated Morwell (3) by 11 shots.
DIVISION 4 sawWarragul(2) defeat Moe (4) by 24 shots. Longwarry had a54-shot win over Morwell (3) and Garfield defeated Traralgon RSL (2) by 10 shots.
In Division 5, Traralgon (4) defeatedNewborough (4),Yallourn North defeated Drouin (4) and Trafalgar (3) defeated Yinnar (2). Churchill (2) defeated Warragul (3), Morwell (4) defeated Traralgon RSL (3) and Traralgon (5)defeated Neerim District (2) in Division 6.
BOWLS
By MICHAEL HOLROYD
LAST Sunday saw the mixed pairs at Newborough Bowling Club, with four seasons in the one day afterahot morning which had twotorrential rain showers, wild winds and thunder and lightning.
After an hour’s delay, play resumed and the final games finished at 8pm with the grass greens recovering well after the rain.
WarragulpairDavid Smithand Lynne Thomas will play Jopel Anderson and Joelene Laukens from Boolarra this Sunday in the mixed pairs at Newborough.
Nathan Cook (Trafalgar) and Sarah Ashby (Morwell) will play Tommy Lodge (Trafalgar) and Julie Jackson (Newborough).
Tonight (Wednesday, November 20) the finalsofthe state fours will be heldat Traralgon.
MATCHES ARE:
Men: Ron Lyfield, Jopel Anderson, Steve Davy (allBoolarra), together with Danny Van Zuylen (Newborough) versus James Scullin, Shane Chapman, Matt Higgins (all Traralgon), together with ChrisWardfrom Boolarra.
Ladies: SherylAtkinson,Jo-AnneMichaels,Jo Gibcusand Maureen Leighton (Newborough) versus Lisa Arnold (Newborough),Joelene Laukens (Boolarra) and Sharon Twite and Natalie Cousin (both Longwarry).
More names are needed for the North versus Southclash on December 1and the Region Sides in Ballarat from January 10-12. Those interested are encouragedtolet their club know.
BLAKE METCALF-HOLT
MOE led the charge of Latrobe Valley sides in Round 7ofCountry Basketball League action.
The Meteors movedback into thehunt for finals, while Morwell continued on adisappointing trend PLAYING away against Sale, Moe’s men’s side made it look easy overcoming athree-game lull dating back to Round 2-winners 101 to 80 at Gippsland Regional Sports Complex.
The Meteors were definitely revitalised having only played two games in four weeks.
Any test the Sonics hoped to present to the reigning premier proved unlikely, with Moe getting to their spots whenever and wherever they liked, leading to a49-36 opening half.
Even they probably thought their leadshould have been more consideringhow stable they’d been, punishing Sale in the winning third quarter by 15 more points to convincingly secure the win.
Ben van Dyk was all over the court with 30 points, followed by four other doubledigit scorers including olderbrother Jayden van Dyk (21) and Rohan Demczuk (19).
Following that performance, the Meteors came out just as locked-in on Sunday afternoon on their home floor, besting Lakes Entrance 90-65.
Moe set the tone in the first quarter with30 points, which began with a12-3 run to start. Veteran guard Simon Vannapraseuth ran back the clock with nine points in the opening term.
ThePelicans keptthe Meteorsatbay foratleast one quarter duringthe second term, but were unable to get it under seven points.
Bothcontestedstrongly whenplayreturned, but the Meteorsweren’tabout to give any slitherof hope the way of Lakes Entrance, outscoring them 14-8 in the final four minutes of the third quarter to push their lead to 17 points.
Jayden van Dyk finished with 24 points and four three-pointersinthe win, followed by Demczuk (20) and Vannapraseuth (18).
MORWELL travelled to Korumburra, only to be done, 90-70, at the hands of the Wildcats.
After sustaining aseven-nothing start, Morwell ran the table with Korumburra thanks to a10-2 finish to the opening term due to the trio of Jordan Canovan, Nick Sedley and Ashton McAllan.
That would be the highestpointofthe Magic’s night however, as the Wildcats flipped the switch midway through the second quarter; down 10 points to end the first half with only athree-point deficit.
Momentum sure looked to have swung the way of Korumburra, but to Morwell’s credit, they stuck by for amajority of theopening portions of thelast half right behind by two points.
That was all she wrote however, as the Wildcats went on an impeccable run while the Magicfell into an abysmal hole, scoring just eight points the rest of the way as the lead ballooned to 20 by the time the final buzzer sounded.
Sedley finished with 21 points and five threes for Morwell, followedbyWilliamTankard with17.
Traralgon had the bye.
THE women’s competition was also led by Moe, who secured an impressive victory over Sale, winning by 38 points on the Sonics’ home court to begin their weekend.
After a43-17 opening half that included holding Sale to just seven points in the first quarter, the Meteors had already done all they needed to secure the win.
Tahni Hodgens finished with 21 points in Moe’s seismicvictory,followedbyMichelle Clarke (13) andDanielle Davies (12).
Anyone showing up early to Sunday’s round of games early in Moe would have been gobsmacked to see what played out.
The Meteors defeated Lakes Entrance by 101 points, 116-15 giving them an almighty percentage boost on their way to an unblemished five wins throughout the season so far.
Moe set the tone witha25-7opening quarter that did nothing but show who the winners were more than certainly going to be.
The Meteors held the Pelicans to just two points through the second and third term, while scoring 69 points themselves through the period as they went ahead 94-9.
Everyone on Moe’s roster scored at least four

points, headlined by Macey McGlead with 17. Morwell went down to Korumburra on Saturday night, 63-52.
The Magic led at quarter time but where outscored31-20inthe middle quarters, putting them to awin-loss record of 3-3 on the season but still
tied for afinalsberth as it currently stands. Abbey Noblett led Morwell with 15 points on the night.
PREVIOUS to this, Round 6saw games go down to the final seconds.
Traralgon continued on their merry way in the men’s,nailinganother victim, while Morwell missedtheir opportunitytoclimb ahead two games in arow.
The T-Birds were the first to send Pakenham packing, beating them 100 to 83 away from home. Morwell didn’t have the same luck, losing by just one point, 73-72 against Wonthaggi.
Tempers flared and fouls became the name of the game as both sides entered the bonus after Wonthaggi’s Angus Kemper hit acrushingthree to send the Coasters ahead for the first time since the second quarter with 90 seconds remaining. Magic forward Jordan Canovan would find the basket with 50 seconds left to tie the game up which followed crucial stops at either end for both teams.
The Coasters finishedwith the ball in theirhands for the final possessions, only as Jacob Winen took acostly foul which sent Wonthaggi’s Vincent Monaghan to the line and gave them the game.
Morwell hoped to avenge themselvesonthe Sunday afternoon when they travelledover to Sale.
The Sonics managed their first win of the season however,inanin-the-end convincing 101-87 victory at Gippsland Regional Sports Complex. It was Sale’s first win since October last year.
THE Women’s competition returned for Latrobe Valley clubs, with Morwell entering the court against Wonthaggi.
Both sides kept it close through the first half of play at Latrobe Leisure Morwell, before the Coasters climbed ahead by seven points with a quarter remaining.
Although outscoring their opponents in the final term,Morwell succumbed 58-54.
Olivia Ouchirenko finished with 17 points for the Magic.
Moe had the bye across both competitions.
THE state government is backing the Shane Warne Legacy to save liveswithfreeheart health checks during the Boxing Day Test.
Victorian Premier, Jacinta Allan announced a grant of $400,000 to the Shane Warne Legacy to deliver additional medical grade machines that can complete free four-minute hearthealth checks at the Melbourne Cricket Ground during the Test, following the success of the campaign last summer.
Australia’s most renowned cricketer and leg-spin bowler,Shane Warne,suffered afatal heartattack in 2022, aged 52.
The Shane Warne Legacy recognises his impact and honours his life by raising awareness about cardiovascular health.
Cricket Australia ChiefExecutive,NickHockley said the King’s legacy would live on.
“Thousands of fans took aShane WarneLegacy Health Checklastyear and we encourage allthose attending this year’s Test Match to do the same,” he said.
“Shane is acricketing and sporting icon, and it is great to see the Victorian government getting behind Shane Warne Legacy to help to continue his incredible impact, both on the game and the health of Victorians.”
Heart disease is one of the leading causesof death and impacts one in six people Australiawide.
Cardiometabolicdisease, such as heart disorders, diabetes, obesity and chronic kidney disease, impactsmanyVictorians,but early detection can help save lives.
Victorians can access preventative heart health checks at their GP, but the Shane Warne Legacy is making it even easier for cricket fans to get a free checkup.
Last year, more than 33,000 people received a free Shane Warne Legacy Heart Health Check, with 7732 checks completed at the Boxing Day Test cricket matchalone –around one in every 20 attendees.
The state government opened Australia’s first specialist cardiachospital, the Victorian Heart Hospital, in March last year.
The hospital’s cardiac emergencydepartment saw 3303 presentationsinits first six months More than half of these patients were men, with amedian age of 65.
By BLAKE METCALF-HOLT
DISCUSSION around local footynever seems to stop.
As the season is now behind us, attention now turns to next year.
The Express will be providing updates on such movements.
Keep up to date with all the ins and outs from the Gippsland League, Mid Gippsland FootballNetball League and North Gippsland FNL.
BAIRNSDALE
Recommitted: Ethan East, Josh Lando, Randall Stewart.
In: CalebCrofts (Paynesville), Lucas Lakay (Lindenow). Out: Link McKenna (Lucknow).
DROUIN
In: Malual Aleer(Warragul Industrials), Kyle Baker (Warragul).
GIPPSLAND
Round 6ofGippsland Athletics Club trackand field season washeld Tuesday 12th November 2024.
RESULTS:
800M
Women: U/14–Xanthe Dalton 3:22.24, Brooklyn Wyatt 3:39.40; U/16–Zaria Dalton 2:59.32
Men: Open –JackDoderico 2:06.46, Aaron Saltmarsh-Milne 2:43.62, Cameron Hughes 3:36.26.
HAMMER
Women: U/14–Brooklyn Wyatt 19.02; U/16 –Zaria Dalton 19.28; Open –Brandy Forget 18.25; Masters–Fiona Saltmarsh 16.91
Men: Open –Aaron Saltmarsh-Milne 25.86, Cameron Hughes 25.56; Masters–Simon VanBaalen 40.61, Wayne Seear 24.78, StuartDalton 20.40.
TRIPLE JUMP
Women: U/14–Melian Archer 8.18, Brooklyn Wyatt 8.01, Xanthe Dalton 7.13; U/18–Janella Archer 9.45
Men: Open –Aaron Saltmarsh-Milne 10.35, Cameron Hughes 7.48; Masters–Simon VanBaalen 8.77
SHOTPUT
Women: U/14–Brooklyn Wyatt 7.80, Melian Archer 6.05; U/16–Zaria Dalton 6.65; U/18 –Janella Archer 7.56; Open –Brandy Forget 7.01;Masters–Fiona Saltmarsh 7.76
Men: Open –JackDoderico 8.99, Cameron Hughes 8.74, Aaron Saltmarsh-Milne 7.82; Masters–Simon VanBaalen 11.99, Stuart Dalton 8.06, Wayne Seear 6.39. 100M
Women: U/14–Brooklyn Wyatt 14.87, Melian Archer 15.56, Xanthe Dalton 16.54; U/16 –Zaria Dalton 13.04; U/18–Janella Archer 14.41; Open –Brandy Forget 22.07
Men: Open –JackDoderico 11.70, Aaron Saltmarsh-Milne 12.32, Cameron Hughes 14.55; Masters–Simon VanBaalen 15.54, Stuart Dalton 16.63, Wayne Seear 18.82. Gippsland Athletics Round 7will be held on Tuesday 19th November,6pm at the Joe Carmody Track, Newborough Events: 100m, Javelin, 3/5km run/walk, Long Jump, Discus, 400m.
GOLF
CHURCHILL &MONASH
4Person Ambrose Saturday9nd November 2024.
Winners: D. Byers, M. Hutchison, C. Waring,
In: Ben Crocker (Collingwood VFL, ex-AFL).
MORWELL
In: Tom Caile (returning), Nathan Noblett (Noble Park).
SALE
Recommitted: Daniel Byron, Kai McDonald. In: Connor and Zane Waixel (both returning).
WARRAGUL
In: Damon Eastwell (QAFL), Will Hayes (Euroa and Carlton VFL).
CHURCHILL
In: Dale Furphy (coach, MDU). Out: Ashley and Luke Di Ciero (Bentleigh).
COWWARR In: Lachlan Sykes (Barooga).
GLENGARRY Recommitted: Jack Burgess, Jet Hodges, Jesse Lee, Benjamin Truin.
R. Dent Nett56.375
RunnersUp: W. McGrath, A. Wright, J. Garth, M. Hammer Nett56.625
Third: G. Sanders, T. Sanders, D. Cluderay
B. Cluderay Nett57.5
N.T.P: 3rdC.Gosling,5th P. Bolding,12th
(Pro Pin) J. Welsh, 14th R. Abel.
Target Hole: C. Waring
StrokeMonthly Medal and 1st roundof Championship Tuesday12th November 2024. DayWinnerand Medal Winner: M. Ryan
87/67 Nett
BGrade: C. Sterrick103/70 Nett
Scratch Winner:R.Madigan 85
D.T.L: 1. M. Smith 91/70 Nettc/b,2.S.Turner
95/70 Nettc/b Birdie: 3rdM.Smith
Putts: S. Caldwell 27
N.T.P: 3rdL.Van Rooy,5th S. Caldwell, 12th
J. Clegg, 14th C. Sterrick
MOE
Sunday, 10 November 2024
OPEN Sunday9holeStableford
Grade AWinners: Shaw, Karen(21) 14
Sunday, 10 November 2024
Grade AWinners: Solohub, Phillip (11) 30
C/B
Place Getters: Babet, Alain 30
Wednesday, 13 November 2024
WOMEN'S WEDNESDAY 9HOLE
Stableford
Grade AWinners: Rankin, Joyce(54) 16
Place Getters: Auchterlonie,Janice 13
Wednesday, 13 November 2024 2nd Rnd
WOMEN'S CLUB CHAMPIONSHIP Stroke
Grade AWinners: Young,Gwen(26) 76
Grade BWinners: O'Reilly, Christine (32)
71
Place Getters:Tulau, Susan 73 Griggs,Andrea 76
Dyt, Phyllis 76 Great Score: Christine O'ReillyBirdie @8
PatThompson Birdie @9
Christine O'Reilly- Target Hole Prize
Wednesday, 13 November 2024 Twilight
Stableford
AGrade Winner: Jake Stanlake(36) 21
Birdies
8th -BarryMead, 14th -TonyJohnson
Thursday, 14 November 2024 OPEN Medley Stableford
Grade AWinners: Beveridge,Eric(10)40
C/B
Grade BWinners: Keenan, Peter(18)44
Grade CWinners: Griggs,Daryl (20) 42
Place Getters: Johnson, Tony 40 C/B
Pace,William 40 Nyko, Steve38C/B
VANBAALEN, Simon
38 C/B Mead, Barry
38 C/B Azzopardi, Nato38Gauci, Anthony
Recommitted: Trent Baldwin, Jake Green. In: Jarvis Kirk (Cowwarr).
HEYFIELD
Recommitted: Mitchell Bennett, Kyle and Tyson Graham.
In: Michael Driscoll (coach, Wodonga).
SALE CITY
Recommitted: Hudson Tollner.
YARRAM
In: Brett Mitchell (coach).
HILL END
Recommitted: Joey Conley, Liam Cumiskey, Harry Moore. In: Dane Fawcett (returning, Neerim Neerim South). Out: Rohan Marra (Yarragon).
38 Spiteri, Patrick37C/B Hibbs, Steven 37 C/B Shearing,Andrew 37 C/B Cropley, Mike
37 Jenkins,Brian 36 C/B Wolski, Ted36C/B
Great Score: PeterKeenan (Birdie) @8
Raymond Lubawski (Birdie) @4 Andrew
Shearing (Birdie) @4 Paul WOODALL (Birdie) @14Rob King (Birdie) @4 Andrew Shearing (Birdie) @8 John Pisa (Birdie)
@8 Nearest to Pin: 4th Andrew Shearing 8th Tony Johnson 14th Simon Duff Friday, 15 November 2024
WOMEN'S STRAIGHT Foursomes
Overall Winners: Tickell, June &Keily, Bev 88 Scratch Champions Robertson, Jenna &Watkinson, Linda 90 Scratch RunnersUp
Grade BWinners: B-1 Tate,Sandy & Shaw, Karen97Minor Scratch B-2 Wight, Gail &Cameron, Heather 101 Minor Scratch
Overall Winners: Tickell, June &Keily, Bev 72 Handicap Winners Tate,Sandy &Shaw, Karen74Handicap RunnersUp
Place Getters: Mitchell, Evelyn & Thompson, Pat75.5 Batchelor,Jan &Chapman, Annie 76.5 C/B Boyes, Irene& Anton, Leigh 76.5 Marriott, Joy& Ahearn, Kerri77
Saturday, 16 November 2024
Competition :Final Rnd MEN'S Club Championship Type :Stroke
Grade AWinners: Stansbury, Les (11) 68
Grade BWinners: Weir,Charles (16) 73 C/B
Grade CWinners: Allen, Ray(29) 72
Place Getters: Collings,Dale 72 Geisler
Graham 73 C/B Johnson, Charles 73 C/B Harber,John 73 C/B Jamieson, George 73 Backman, Shane 74 Beath, Ken74C/B Keenan, Peter74C/B Mead, Barry74C/B Weir,Liam74Gross Winner
Aaron Bassman 74 Great Score: LukeVan Der Meulen Hole in
One PrizeLes Stansbury(Birdie)@8
AnthonyGauci (Birdie) @8
Nearest to Pin: 4th Dale Collings
8th AnthonyGauci 14th LukeVan Der Meulen (Hole in 1)
MORWELL
Wednesday13th November 2024
Womens 4BBB Championships
Round 1.Winners: IYoshimura&S Karleusa 49 pts
NTP: 2nd Lvan Rooy 8th DVuillermin 11th
SKarleusa 15th CBoers. Birdies: 8th NTePaa
BASKETBALL WNBL BY BLAKE METCALF-HOLT
LATROBEValleystars returned to the court forRound 3ofWNBL action.
Traralgon’sJade Melbourne and the UC Capitals went down to Perth Lynx 92 to 90 at AIS Arena last Thursday (November 14).
Melbourne was an offensivebeast finishing with 20 points, eight assistsand three rebounds
The Capitals dropped to a0-4 starttothe year after another loss,this timetoSouthside Flyers at the State Basketball Centre, 98-77 on Sunday.
Moe’s Jaz Shelley is working on a50per cent win rate to begin her professional career, after Geelong Unitedsecured their second win in threegamesagainst Adelaide Lightning,72-66, at Geelong Arena last Saturday.
Shelley filled the stat sheet finishing withnine points, six reboundsand four assists in the win.
BASKETBALL
NBL BY BLAKE METCALF-HOLT
TRARALGON’S Jack Whitemissed Melbourne United’s third successive win against Adelaide 36ers, 113 to 93, after injuring his calf against Perth Wildcats the week before.
White was also withdrawn from the Australian Boomers’ FIBA Asia Cup Qualifiers squad due to play tomorrow (Thursday, November 21) against Bangkok and Sunday (November 24) against Korea.
White’s next opportunity to don the green and gold again, after being cut for the 2024 Paris Olympics, will be the Boomers’ next qualifying games held in February.
NBL action goesinto an 11-day hiatusreturning on November 28, while United play Sydney KingsonDecember 1, givingWhiteample time to return at full health for their push towards finals.
TRAFALGAR
Friday, November 15th 2024, Open Men’s &Ladies Stableford
AGrade Winner: Paul Spiteri40pts C/B
BGrade Winner: Paul Fogerty 37 pts C/B
DTL's: David Winfield 40, Jamie Winters38, Shane Woodall 38, Jess McGrath 37,Glenn Doolan 36, RayWiseman 36, HayleyBorg 36, Darryl Blackshaw36, Brian McKenzie 35 C/B
Birdies: 2nd: PeterHobson 5th: Dan Chapple,Laurie Snowball 11th:David Winfield 13th: Jamie Winters15th: Jamie Winters, Paul Spiteri, Jess McGrath Saturday, November 16th 2024, Stroke–2nd Round Club Championships
AGrade Winner: Tony Shearer 68 nettC/B
BGrade Winner: RonDavey 67 nett
CGrade Winner: Chris Griffin71 nett
DTL’s: Glen Roberts 68, Graeme Ayre 69, PeterRhodes 69, John Tabuteau 70, Reno Borg70, Jeff Hasthorpe 70, George Petkovic 70, JoePedemont 71, Tony O’Reilly 71, Raywilliams 72, Nathan Dart 72, Wayne Robbins 72, Chris Moody 72
NTP’s: 2nd: Reno Borg5th:Graeme Ayre 11th: NickRowe13th: Reno Borg15th: Paul Massey Birdies: 2nd: Bruce Aplin 5th: Graeme Ayre,Phil Town, Jordan Chapman, Anthony Gould, GarryJansen 15th:LukeBryant, Joe Pedemont
Sunday, November 17th 2024,Trafalgar Plate
AGrade Winner: Grant McLure36pts
BGrade Winner: Mitchell McQuillen 37 pts
CGrade Winner: MarkAndo 35 pts
ScratchWinner: Bill williams 72 gross
DTL’s: Neville Lindsay35, John Hoare35, David Johnson 35, Bill Williams 35, Russell Dent 34, PeterMoss 34, Tony Shearer 33, MarkHiriart 33, Alan Storer 33, Anthony Carolan33, Grahan Geisler 32, Anthony Gould 32, Reno Borg32, Nathan Lugton 32, Laurie Veenman 32, PeterBurghardt 32
NTP’s: 2nd: Nathan Lugton 5th: Mitchell
McQuillen 11th:TerryDonnison 13th:Grant
McLure15th: Ryan Williams
Tuesday12/11/2024 -Split 6
Players:24,Women 1, Men 23
Winner: RichardGould (26)
Runner Up: Les Pearce (24 c/b)
DTL: Chris Griffin(24), SteveGould (23), Tony Shearer (22), Franc Kiss (22)
NTP: RichardGould (5)
Thursday:14/11/2024 -Stroke
Players:54,Women 17,Men 37
Women’s Winner: Christine Payne(27)
Runner Up: Lorna Risol (32)
DTL: June Tickell (33), Nola Fordham (34), Aileen McNair (34)
NTP: Lorna Risol (15)
Men’s Winner: Ivan Grant (28)
Runner Up: Duane Baker (29)
DTL: AnthonyCunningham (30), Steve Gould (30), Laurie Snowball (30), Peter Cooke(30), Graeme Grant (32), Mark Jackson (32), RobCusworth-Warner (32), Glenn Doolan (33)
NTP: PeterCooke(15)
Par3Event: PeterCooke
WednesdayWomen's results: 13/11/24
Stroke-November Monthly Medal -18 players.9-Hole Stableford- 2players November Medal Winner: Chris Payne (41) 68 Nett
Runner-Up: June Tickell (11) 68 NettC/B Scratch Winner:June Tickell 79
DTL: Lorna Risol (23) 70, JennyEvison (24) 70, Ange Bayley(21) 70, Jo Baker (31) 71, KarenMacGregor (23) 71
NTP: 5th Lorna Risol ,15th BevKeily 9Hole Stableford: Winner: Heather Savige (37) 18 points
Runner Up: Olwyn Balfour
Gobblers: 11th KarenMacGregor and 12th SueKlemke
TheTrafalgar Women's ChallengeBowl Playedonthe 11/11. It wasaPerfect day and the course wasinpristine condition. The winning team wasMirboo North with a fantastic scoreof113 points.Congratulations to theteam of Maree Thompson, Barb Stimson and Dot Kidd. The SilverDivision winner wasMerryn Dear -Churchill Monash (17) 39points,BronzeDivision winner wasBarb Stimson Mirboo North 42 points Sincerethanks to Drummond Golf Traralgon fortheir sponsorship of this event.
PISTOLS
Mon 4/11/24. air pistol
BGrade: MTrent 523-58-581
CGrade: FBorgnine 508-62-570. D Chandler 479-100-579. EBeaufort476-89565.M Howard 416-113-529. Dgrade: DO'Rourke












Round1-April 5
Bairnsdale vMoe
Morwell vDrouin





WonthaggivWarragul
Traralgon vLeongatha (twilight)
Sale vMaff ra (Sunday)
Round2-April 12
Maff ra vWonthaggi
LeongathavSale
Warragul vMorwell
Drouin vBairnsdale Moe vTraralgon
EASTER -April 19
Round3-April 26
Traralgon vMorwell (Friday) Wonthaggi vDrouin
Bairnsdale vLeongatha Moe vMaff ra
SalevWarragul
Round4-May 3
Warragul vBairnsdale
Drouin vSale
Leongatha vMoe
Morwell vWonthaggi
Maff ra vTraralgon
Round5-May 10
Sale vWonthaggi
TraralgonvWarragul
Bairnsdale vMaffra Moe vDrouin
Morwell vLeongatha















Round6-May 17
Warragul vLeongatha Moe vSale
Wonthaggi vBairnsdale
Maff ra vMorwell
Drouin vTraralgon
Round7(spilt round) -May 24
Traralgon vWonthaggi
Warragul vMaff ra
Round7(splitround) -May 31
Morwell vMoe
Sale vBairnsdale
Leongatha vDrouin
Round8-June7
Drouin vMaff ra
MoevWarragul
Sale vMorwell
Bairnsdale vTraralgon
Leongathav Wonthaggi
Round9-June14
Maff ra vLeongatha
Morwell vBairnsdale
Traralgon vSale
Wonthaggi vMoe
Warragul vDrouin (Sunday)
Round10-June21
MoevBairnsdale
Drouin vMorwell
Warragul vWonthaggi
Leongatha vTraralgon
Maff ra vSale








Round11-June28
WonthaggivMaff ra
SalevLeongatha Morwell vWarragul
Bairnsdale vDrouin
Traralgon vMoe
Round12-July 5
Drouin vWonthaggi
Leongatha vBairnsdale
Maff ra vMoe
Warragul vSale




Morwell vTraralgon (Sunday)
LEAGUE BYE-July12
Round13- July 19
Bairnsdale vWarragul
Sale vDrouin
Moe vLeongatha WonthaggivMorwell
Traralgon vMaff ra
Round14-July26
WonthaggivSale
Warragul vTraralgon
Maff ra vBairnsdale
Drouin vMoe
LeongathavMorwell
Round15-August 2
LeongathavWarragul
Sale vMoe
Bairnsdale vWonthaggi
Morwell vMaff ra
Traralgon vDrouin









Round16-August 9
WonthaggivTraralgon
Bairnsdale vSale
Maff ra vWarragul
Moe vMorwell
Drouin vLeongatha
Round17-August 16
Maff ra vDrouin
Warragul vMoe
Morwell vSale
Traralgon vBairnsdale
Wonthaggi vLeongatha
Round18-August 23
LeongathavMaffra
Bairnsdale vMorwell
Sale vTraralgon
Moe vWonthaggi
Drouin vWarragul
FINALS
QualifyingFinal August 30
Elimination Final August 31
SecondSemi Final September 6
First Semi Final September 7
Preliminary Final September 13
GrandFinal
September 20

BY BLAKE METCALF-HOLT
THE Gippsland League fixture for season 2025 has released well ahead of yet another anticipated and sure to be great year of top-tier country football. As it is every year,the inevitable complaints and finger-pointing at what club hasbeenfavouredwillbemade -it happensatany level of football.‘Why are Collingwood fans complaining when they play 15 games at the MCG every year?’
Some intriguing points regarding the draw have surfaced, which could factor into who will and who won’t be playing off for the premiership in 2025.
BAIRNSDALE aren’t only the first team mentioned because of alphabetical placement -they have been dished one of the toughest cards of all.
The Redlegs play five away games in eight weeksbetween Round6and 12, by far the most kilometres in one stretch during the season for any club. Even more is the challenges that present during this period, where they have to travel to Wonthaggi (200kms), Sale, Morwell, Moe and Leongatha with an added homegameagainst premier Traralgonsandwiched in Round 8.
Fuel cards maybenecessaryfor Bairnsdale players and officials during this time.
Considering the Redlegs were only a game off fifthspotwith around to go last season, things seem to have only gotten more difficult.

MOE will be at Ted Summerton Reserve in four of the first six rounds, which includes four home games in five rounds if you remove their Round 1match in Bairnsdale.
That is evened out in the backend of the regular season though, where the Lions play fourawaygames in five rounds from rounds 11 to 15.
LAST season, Wonthaggi fought from a1-4 start in the win-loss column to play finals.
The Power will sure hope to get off to the best start possible to avoid keeping themselves outside of the postseason loop for the first time since 2019. Not only willWonthaggi matchup against last year’s top trio in Traralgon, Leongatha and Moe (firsttwo away
games) back-to-back-to-back from Round 7toRound 9, they’ll alsohave to be ideally placed ahead of their final five matches.
The Power conclude with games against Sale, at Bairnsdale, Traralgon, Leongatha and at Moe before the homeand-away season is completed.
Depending on how they track in the lead up and through those stretches, it could set them up for finals -although, the luxury of resting players ahead of finals most likely won’t be on the cards.
THE Gippsland League season will commence on Saturday,April 52025.
The schedule again features 18 homeand-away matches, with anumberof marquee fixtures. Traralgon will unfurl its senior premiership flag against

Challengeaccepted: CanMoe complete thethree-peat next season?
season 2024 runner-up Leongatha at Terry Hunter Oval in Round 1ina twilight time slot.
The Battle of the Birds between Maffra and Sale will also be akey fixture on the Sunday in the opening weekend of matches.
The AGrade Grand Final rematch between Moe and Warragul willhaveto wait until Round 8after the Gippsland League fulfilled Moe’s request to take on Warragulonthe King’sBirthday Weekend.
Bairnsdale and Moe will both continue their MND theme match days on the King’s Birthday weekend in Round 8, with this year’s draw also containing three significant league-run theme rounds.
The annual Mental Health Round returns to Round 2inthe fixture, while Orange Round will again be scheduled in June with the introduction of an Indigenous Recognition Round in July. The byes will fall on Easter and in the July school holidays. Round 7will also featureabye with asplit round being re-introduced to provide abreak for clubs leading into June.
Drouin footballand netballfixtures will be relocated during the season due to ground resurfacing works at Drouin RecreationReserve. The venues for Drouin home matches will be advised at alater date.
Finalsbegin on the last weekend in August, with the Grand Finalscheduled for September 20.
FOOTBALL
GIPPSLAND LEAGUE
BY LIAM DURKIN
ON the surface,the 2025 GippslandLeague fixture appears relatively straightforward.
Everyone plays each other twice, making for an equal competition between 10 teams across 18 rounds.
Analysing the schedule morethoroughly however can reveal just where some clubs might holdan advantage,while others couldunfortunately be set up to fail.
The following analysis factors in home ground advantages, travel, recovery time between games, and the expected strengthofthe competing senior football teams.
Granted it is hard to judge the latterduring preseason, and no games in the Gippsland League should ever be marked as certainties, it makes for an interesting exercise nonetheless.
After all, we still need some footy to talk about at this time of year.
Last season: premier Draw difficulty: 3/10
For:
Fixture goes home/away throughout all 18 rounds.
Has an eight-day break before playing Maffra in Rd 4.
Has two weeks to freshen up for trip to Bairnsdale in Rd 8.
Run of games against Maffra, Warragul and Drouin Rd 13-15 could be the ideal block to rest/
freshen/nurse players back before finals.
Against:
No home rooms next season.
Verdict: Just about the perfect fixture froma management perspective.
Last season: runner-up Draw difficulty: 2/10
For:
Comfortable run home (Warragul, Drouin, Wonthaggi, Maffra).
Consecutive home games before last three weeks.
Against:
Wonthaggi will be coming off a14-day break compared to Leongatha’s seven when they meet in Rd 8.
Verdict: Much of amuchness. Interesting the rivalry game isn’t until Rd 8.
Last season: third
Draw difficulty: 5.5/10
For:
Four home games in the first six rounds.
Play one game outside the Latrobe Valley between Rd 2-8.
Two longest road trips (Bairnsdale/Wonthaggi) done in the first half of the season.
Could be agreat runhome, playing Warragul and atravelling Wonthaggi in the last two rounds.
Against:
Consecutive away games Rd 11-12 followed by Leongatha first game after the bye.
Danger game against Warragul in Rd 8. The Gulls will have an extra weeks rest heading into that game.
Verdict: Have been dealt some very good cards.
Last season: fourth
Draw difficulty: 4/10
For:
Could be 4-0, should at least be 3-0 to start.
Will be coming off a14-day break when they play Leongatha in Rd 8
Only travel twice in the last six weeks.
Against:
Very tough three games to finish (Traralgon, Leongatha, Moe).
Get one less day’s rest before playing Morwell in Rd 4.
Verdict: Would want to have at least 10 wins by Rd 15.Consecutive home gamesstraightafter the last byeshouldhelp
Last season: fifth
Draw difficulty: 6.5/10
For:
At home for three out of four games between Rd 5-8.
Play Traralgon in the last round. Could be perfect finals warm-up.
Against:
Only get six days to recover before travelling to Leongatha in Rd 2.
More consecutive away games than home.
Play consecutive away games in the last three rounds.
Verdict: Bit of amix and match.Home for two weeks, then away for the next two in the middle of the year.
Last season: sixth
Draw difficulty: 8.5/10
For:
Should be 2-0 heading into Easter.
Get an eight-day break before playing Wonthaggi at home in Rd 4.
Play four games in the Latrobe Valley in five rounds between Rd 3-7
Get Drouin coming off asix day break in Rd 10.
Against:
Travel four weeks in the last six rounds, two to the furthest locations (Wonthaggi/Bairnsdale).
Play Traralgon, Wonthaggi, Leongatha in consecutive weeks twice over.
Play Wonthaggi and Leongatha away in consecutive weeks.
Potential virtual elimination finals Rd 15-17 (Maffra, Moe, Sale).
Play Bairnsdale away in the last round.
Verdict: Draw of death. As tough as it gets playing Wonthaggi and Leongatha away in consecutive weeks during the middle of winter.
Last season: seventh
Draw difficulty: 7/10
For:
No Sunday games.
Three of last four games at home.
Against:
More consecutive away games than home.
Face Traralgon coming off a14-day break in Rd 8.
Play three 2024 finalists in arow between Rd 15-17.
Verdict: Catch-22. Play mostly at home before finals but against likely quality opponents.
Last season: eighth
Draw difficulty: 5/10
For:
More consecutive home games than away games.
Travel once in five rounds (Rd 6-10).
Have 14-day break before playing Moe in Rd 8.
Against:
Six-day break before playing Wonthaggi in Rd 10
Away for three of last four games.
Verdict: Can consolidate with consecutive home games either side of one away game in the middle of the year.
Last season: ninth
Draw difficulty: 9.5/10
For:
Will see the last two games as winnable. Against:
Expected to be playing every game away from home.
Cop all 2024 finalists in arow (Rd 3-7, Rd 12-16).
Face Maffra coming off a14-day break in Rd 8.
Six-day break before playing Morwell in Rd 10.
Verdict: Almost unfair to judge, and equally irrelevant. Will be well and truly up against it.
Last season: 10th
Draw difficulty: 8/10
For:
More consecutive home games than away.
Get a14-day break coming into Drouin game in Rd 8.
Chance to finish off the year with winnable games against Warragul and Drouin both at home in Rd 16-17.
Against:
First four rounds are all against 2024 finalists.
Follow that with trip to Bairnsdale in Rd 5.
Get one less day’s break than Traralgon before Rd 4game.
Play all 2024 finalists in arow between Rd 9-13, in the middleofwinter.
Verdict: As SIA sang “I can’t competewiththe she wolf”. Maffra could be “falling to pieces”.
CRICKET
CLVPREMIER A
BY LIAM DURKIN
SLIP, slop, slapcarried atripleentendre in Cricket Latrobe Valley at the weekend.
With the temperature topping 30 degrees for the firstday of Round 6, the heat led to some teams slipping up,sometobesloppy in the field, and some players to slap the ball to all parts.
EX STUDENTS went to stumps in astrong position.
The Sharks batted first at TerryHunterOval, and declared with 234 on the board after 82 overs against CATS.
Jackson McMahon ledthe way for the home side, falling just short of aton.
Most of thecard helped out with double figure scores, before 200 gamer Andy Matthews used all his experience, coming in at number nine to make an enterprising half-century off just 67 balls. His effort took the contest away from CATS, who may have been thinking of a170-180 chase.
Often in that situation, runs down the order can give one team every ounce of momentum, but CATS to their credit went to stumps none down,
andtickedoff 33 runs in the 11 overs they were tasked with surviving.
Ben Hagley hadearlier taken 3/29 and Harry Cooper 2/58. Tinashe Panyangara bowled a herculean 29 overs, sending down 15 maidens in the process.
WICKETS tumbled at Apex Park.
Sixteen poles fell on Day 1asCentrals and Morwell both found the going tough.
The Tigers decided to bat first upon winning the toss, and were knocked over for 113 inside 45 overs.
Sri Lankan pair Tyron Gamage and Nuwan Pradeep took six wickets between them, while Corey Pollard chipped in with 2/27 with his leaningback mediums.
The leaguegot its firstlook at Pradeep, the former Sri Lankan Test quick, last round. By all reports he bowled international lengths which, while far too good for most local players, didn’t trouble the wickets column.
He took 4/22 last Saturday, with two coming via lbw and bowled, perhaps indicating he has made the necessary adjustment.
TimFordtop-scored with 36, one of only three batsmentoreach double digits.
Centrals batted for virtually just as many overs beforethe close of play, and walked off 28 runs
behind with four wickets still waiting in the shed.
The home side was in all sorts of trouble at 4/13, before Tye Hourigan steadied things.
From acricket sense,the Lions would have been happy Hourigan chose not to nominatefor the AFL draft, and he will look to take Centrals to first innings points next week when he resumes on 35 notout
Given recent history however, the Lions are prone to acollapse, and Morwell will be sure to make them work for every one of these 28 runs, in full knowledge arange of results remain arealistic possibility.
Ford and Brendan Brincat have two wickets each.
PRETTY well poised at Ted Summerton Reserve.
Moe has Raiders 2/36 in pursuit of 165.
The Vale Street wicket went against recent history at the weekend, as the home side stumbled theirway through 68.5 overs.
Ever-astute Raiders captain Liam Maynard decided to bowl first, with the names of key Moe batsmen Benn Zomer and Rob Phoenix not on the team sheet for Day 1surely afactor in his decision.
With those two out, it was left to Andrew Philip and Noah Kane to do most of the scoring.
The former made 76 and the latterbatted with the
middle and lower order to finish unbeaten on 48.
Ben Rivers returned exceptional figures of 5/12, whileTom Robertson gavehis confidence atimely boost, snaring 3/22.
Raiders had 16 overs to face before stumps, and despite losing both openers, will head into Day 2 knowing if they bat for long enough, they will be in with ashow.
TOONGABBIE look like they will be negotiating the margin of defeat.
The Rams need amiracle akin to the wool price skyrocketing overnight, as Glengarry needs just 58 runs to win with eight wickets in hand.
Battingfirstathome, Toongabbie posted adisappointing total of 136.
Amal Athulathmudali was again the shining light, scoring 39 off only 35 rocks, but three other scores aroundthe 20 markstoppedthe Rams getting closer to 200.
Wickets were shared in the Magpies camp, with Max Merton,AlJenkin, Brandon Mayberryand FrankMarks taking two each.
Glengarry had agood 28 overstosettle into their batting, and are 2/78 at stumps.
Nat Freitagalready has 39 to his name, and virtually has ahead startona big knock when Day 2commences.
Saturday, November 16
Premier B(Round 7, two dayer, Day 1): Glengarry 66 (J Brierley 8/27) vs JeeralangBoolarra 5/152 (T Laaks 72, BMcCormack 60, JDuncan 2/11), Ex Students 7/312(AJaensch 119,D Millington 103, DChurchill 47, CSeymour 4/29,SGniel 2/74)vsMorwell,CATS 4dec 205 (S Webley 74*, RHare 57, CBeaver 39, JGiles 2/47) vs TraralgonWest 9/54 (J Motta 5/30,R Hare 4/22) &1/76(SVarcasi 43*), Thorpdale 7dec 260(K O'Connell 135*, ZO'Connell 47, MCooper 2/47, SRyan 2/58, DVeale2/60) vs Toongabbie 1/23, Mirboo North 64 (R Johnson 4/12, SFreeman 3/15) vs Churchill 37 (R Hughes 4/16,GWalker 4/14) &1/29.
BGrade (Round 7): Centrals 8/164 (T Shankland 61, HBerry 37, CHill 2/31, JVarghese 2/32) def Raiders 9/160 (J Berryman-Lambert 59, HSingh Rai 29, DDoble 3/37, Brodie Howlett 2/18, BOuld 2/19), Willow Grove 4/109 (A James 35, KMulley 31, DMcDougall2/9) def Latrobe 108 (D McDougall 30, PGrima 6/6, JCoombs 2/16), Imperials 189 (T Paulet 51, DCampbell 35, JAnderson 34,A Donoghue29, HEdwards 4/5, MWhitney 2/36) def Moe 9/117 (H Edwards 34, JAnderson 2/17, E Jarvis 2/19), Gormandale 6/220 (G Swan 65*, D Norton 57, AVan Zuyden 3/39) def Rovers 5/143 (L Woolan 29*, SBoyes 29, BNikidemski27, C White 2/20, CBull2/25).
Premier C(Round 5): Toongabbie 2/85 (D Andjelkovic42, BWall 26*, CMonds 2/18)def Morwell 78 (C Monds 40, BBriscoe 2/6, PAnton 2/16, JElms2/22), Moe 4/226 (C Veenman 60*, R Semmens45, JKeltie 44, DBiggins 27*, SMurphy
25,S Carney 2/23) def Rovers 110 (B Nicholls 46, R Whitney 3/6, FManduci 2/2, BCake2/23), Centrals 119 (T Poursanidis 60, HMartin5/26, ASmith 2/35) def Imperials 111 (C Meers 26, HPettie 3/16, LZammit 3/44), Glengarry 4/166 (G Vanderzalm 113*,DCochrane2/21) def Mirboo North5/161 (G Mowat 59*, DCochrane 52*, JHutton 3/32), Ex Students def CATS on forfeit.
CGrade (Round 5): Gormandale168 (J Kendall 42, SGamble 42, BPeavey 36, BJarvis 3/52, OBrouwer 2/17, JCargill 2/46) def Rawson 156 (J Wiseman 55, BJarvis25, JTowers 3/13, J Armstrong 2/20, ASmith 2/25), Willow Grove 8/85 (M Failla 27, NJenkins3/11,I Lawrence 3/16) def Imperials 9/79 (L Walsh 3/14, MFailla 3/20), Latrobe 4/138(no further details available) def Jeeralang-Boolarra 3/137 (E Stanton 35, SBlines 32, PGoyne 3/9, ABremner 3/28, RLawsonPepper 2/9), Churchill def Raiders on forfeit, Traralgon West -bye
Thursday, November 14
Women's Championship (Round 5): Ex Students 3/76 (D Godenzi 30) def Willow Grove 6/74(IsabelStewart 26*,RAdams 2/2), Raiders 0/109 (T Hunt 32*, RCarr30*,KWebber 19*) def Rovers 5/72(RPidikiti 2/16), Mirboo North 3/89 (K Collins 24*) def Morwell 3/87 (R Ball 30*, NFreeman 19, CMayberry 18*, KCollins 3/11).
Women's Premier (Round 5): Willow Grove 0/38 (M Donoghue 22*) def Centrals 6/34 (M Donoghue 3/2),Raiders 0/125 (Z Quinsey-Munro 30*, SBlines 26*, GSanders 19*) def Churchill 6/53 (D van Vliet 25, KTurrell 2/4), Imperials 0/87 (K Morley 30*, RReid 30*) def Latrobe 4/86 (S Rockliff 32*, TAnderson 29)
Under 16 (Friday,November 15, Round 6, Day 1): Toongabbie 2/37 (K Pritchett22*)vs Centrals 8/82 (A Fernando 26, JHazelman 3/12, TYoung 2/8), Raiders 2/142 (L Urand51ret, K Caldwell34ret) vs Morwell Latrobe 9/79 (J Howell 21, JDunn 3/9, TWebber 2/1), Willow Grove9/161 (D vn der Stoep 51 ret, OWhite 36, LBastin3/13) vs Ex Students, Gormandale/Rovers vs Moe (scores not available), Glengarry -bye.
Under 14 (Wednesday, November 13, Round 4, Day 2): Ex Students 7/180 (T Churchill 32 ret, JHazelman 21 ret, ECook 2/25) defCentrals
7/116 (J Poursanidis50ret,JHazelman2/20, T Churchill 2/21), Mirboo North 226 (J Calafiore 64, LChila 50 ret, LWalsh 2/20, CO'Brien 2/23) def Moe 8/61 (R Teagle 3/9, LChila 2/4, EConlan 2/10), Jeeralang-Boolarra 161 (O Stanton 34*, C Stanton 30, TBlake 25, SBlines24, APeavey 2/12) def Latrobe 26 (C Stanton 5/3, SBlines4/6), Morwell 8/183 (J Sterrick 43, WFrankland 41, C Gray 27, JCumming 3/16, NSallee 2/6) def Willow Grove 3/79 (N Sallee 27*) and 7/53 (W Frankland 2/7), Gormandale/Rovers -bye
T20s started Tuesday, November 19 -Express is printed Monday nights.
GCL BY LIAM DURKIN
PARENTS of under 13 kids breathed some sigh of reliefafterthe Gippsland Cricket League match for Latrobe Valley was abandonedat the weekend.
The under 13 fixture did not go ahead due to wet weather,meaning aSunday drive to Wy Yung was avoided.
The 13s are scheduled to nextplayonSunday, December 8, with Round 3seeing Latrobe Valley on the road to Sale-Maffra.
The15s will also be in the Sale region that
CENTRALSVMORWELL at Apex Park
MORWELL 1STINNINGS
MCukier lbw TGamage 9
FHomyoon lbwT Gamage 7 KFortuin cT Hourigan bNPradeep 4 BClymo cT Hourigan bNPradeep 3 TFordbC Pollard. 36 BMills cJ Mathews bC Whitehead. 18
BBrincat cT
STUDENTS 1STINNINGS BOWLING
4-1-7-0, AMatthews2-1-11-0, JPryde 3-1-3-0, ABrady 2-0-6-0
1STINNINGS BOWLING
15-7-12-5, HMcColl 14.5-4-46-1, RWebber 7-1-17-0, T
12-5-22-3, GCheshire12-3-26-0, DStares 5-2-15-0, P Gunathilake3-0-17-0
RAIDERS 1STINNINGS
GCheshirecESheekey bC Taylor 17
RWebber cESheekey bKHughes. 8 DStares not out 6
BMacfarlane not out 3
Sundries (0w 0nb 1lb 1b) 2
TOTAL (16 Overs). 2/36 MOE 1STINNINGS BOWLING
KHughes 8-1-18-1, CTaylor 6-2-13-1, NLee 2-1-3-0
day before asomewhatbizarre fixture seesthem required to travel to Wy Yung three days before Christmas for the last game of 2024. The under 18s are in action thisSunday, taking on Leongatha in Wonthaggi.
The seniors have hosting duty, and will welcome Bairnsdale to Ted Summerton Reserve. Latrobe Valley will aim to get its premiership defenceontrack withawin, followingdefeat andanabandonment in the firsttwo rounds.
The senior women’sfixtureisveryskewwhiff, with teams and matches seemingly changing every week.
Officially, Latrobe Valley’s next game is not until January next year.
TOONGABBIEVGLENGARRY Roger ReisOval TOONGABBIE 1STINNINGS TDunn bMMerton. 7 IJayasingherun outCRobson
CLVAGRADE BY BLAKE METCALF-HOLT
THE secondswingoftwo-day cricket opened at the weekend for Round 6ofCricket Latrobe Valley AGrade
Latrobelooks fit to continue their form against Traralgon West out at Jack Canavan after rolling the Eagles for 145.
The Sharksare 2/103 in reply heading into Day 2. Players went by before Traralgon West captain Robert Wilkie entered the fold, trudging through for 26 off 79 balls before being dismissed in the 44th over.
DarcyCooke looked to be on fireand be atrue winner before being caught by Anthony Bloomfield after making 25 off just 17 balls.
Reece Falla was bestonthe dayfor Traralgon West with 31 not out.
Sam Wilson performed excellently, taking 4/31 including four maidens and Salman Rasoolgrabbed 3/20 off 9.2 overs against his old side.
All praise to Wilsonand Bloomfield (sounding likean80s buddycop TV show), who scored39 and 40 respectively before stumps, and will pick up where they left off.
IMPERIALS have alreadybeaten Rovers on first innings
The team from Catterick Crescent are potentially on their way to a5-0 win-loss start to the season after bowling Rovers out for 135 and ending Day 1at6/171.
Simon Duff produced the best forRovers with 50 off 86, but was the second of threesuccessive victims from Imperials bowler Todd Mann at Duncan Cameron.
No other Rover could manager adecent stint other than Lachlan Patterson who scored 31 off 41. Mann took 5/42 including three maidens in 14.5 overs, and Tom Starkey 3/27.
Imperials’ successful first innings began with captain Ryan Morley collecting 27 runs (including five across the boundary) off 32 and Starkey supporting handily with 30 off 42.
James Skingle arrived after both exited the day and made 54 off 57.
Skinglewas dismissed after being caught by Duff before Shane Galea entered, carrying Imperials overtheir target with 39 not out withfour monster sixes in the clutch.
CHURCHILL may be back on the winner’s board in aweek’s time.
After some routine early stints, the Cobras saw aresolute Steve Warr enter the picture, collecting 65 not out off awhopping215 balls at Andrews Park West.
Warr supported John Keighran, who arrived at number sevenand knocked86off 96 which included 11 fours.
Anton Thomas took 3/27 including 11 maidens
CRICKET
By TOM HAYES
MELBOURNERenegades, along with its new signing of local cricket export, Nicole Faltum, are making quitethe impressioninthe latest Women’s Big Bash League season.
After eightgames, the Renegades are second with five wins, coming after aseason which saw them finish dead last with just two wins.
Faltum faced her former side for the second time in afortnightwhen theRenegades and Stars locked horns on the biggest stage of them all, the MCG last Friday (November 15).
After winning the toss,the Renegades battedfirst When Faltum got to the crease, the scenes were dire for the Renegades, who were 5/48 in just the eighth over.
Shegot straighttowork alongside Georgia Wareham, both striking at over 100, up until Wareham’s dismissal nearly 10 overs later,saving the innings by adding 67 runs together.
Wareham made 34 (32), while Faltum remained at the crease, now joined by Georgia Prestwidge, the scoreboard reading 6/115.
Stunningly, the Faltum-Prestwidge duo was also unstoppable, the two added another 55 runs to see out the 20-over allotment, ending on 6/170.
CRICKET
GIPPSLAND PRIDE
GIPPSLAND Pridematches were abandoned last Sunday.
Pride hosted South East Sharks in the under 21s and 18s, yet neither game hardly got astart.
The under 21s bowled just 2.5 overs at Morwell Rec, while the 18s bowled 6.3 before rain arrived across the track at Keegan Street.
Raiders pair Ben Rivers and Darryn Stares represented the under21s, while Rovers’ Navdeep Singh and Trafalgar’s James Pace were apartofthe 18s team.
Faltum rescued the innings with 66 not out from 42 deliveries -her biggest-ever score in the WBBL.
Faltum once again setthe toneinthe Stars’ chase, claiming the first wicket behind the pegs, stumping Yastika Bhatia in the second over.
The Renegades were able to hold off the fast finishing Stars, getting home by nine runs.
THIS win backed up asolid month for the Gades, who defeated the Adelaide Strikers and Stars previously.
The match againstthe Stars (November 9) at Junction Oval saw the Renegades win after posting 6/146.
Faltum made 29 off 23, hitting five fours.
In the chase, Faltum stumped key Stars allrounder Annabel Sutherlandfor 16, stinting their progress at 5/81.
The visitor’s tail didn’t last very long, with three of the last four wickets falling for less than 10 runs to see them finish 9/131.
JUST days later, the Renegades were on the road to face the reigning champion, the Strikers at Adelaide Oval.
There wasn’t awhole lot of actionbehind the stumps for Faltum, as the Strikerspiled on the runs batting first, closing at 8/185.
The was some work for the Renegades to do, but things just went their way,and they ended up
winning in acanter by nine wickets. Faltum was not required with the bat.
AT timeofprint, after playing eight games, the Renegades sit second on the table behind Sydney Thunder, with five wins and three losses and anet run rate of 0.208.
In the upcoming week, the Renegades will face Hobart Hurricanes tomorrow (Thursday, November 21), and the Thunder on Saturday, November 23 –its last game before finals start.
MORWELL export Peter Siddle was again selected for Victoria in the Sheffield Shield when it hosted Western Australia.
Siddle didn’t fare as well as his last performance for the Vics, but regardless, his side sits in apromising position.
WA took to the crease first, lasting just 60 overs before being bowledout for 167. Siddleclaimed the wicket of Ashton Agar to collect figures of 1/29 from 13 overs.
In return, Victoria made 373 from 112 overs. Siddlebatted toward the end of the innings,making eight off 26 deliveries, hitting one boundary. At stumps on Day 3(the time of print), Western Australia are 7/278, currently leading by 72 runs with two days to play.
CRICKET
VETERANS BY GORDON
COWLING
THE match between Gippsland Goannas Over 60s and YarraValleyVeterans did not go ahead at the weekend, as theYarra Valleyclub couldnot bring ateam to Gippsland(again)
The Goannas Over 50s defeated Sunbury after posting 4/207 and rolling their opponents for 171.
The Goannas had one representative at the Over 60 National Championships whichwere held in Brisbane last week.
Rob Taylor was selected in the Division 3team, and made 12 not out in awin during the first game.
Unfortunately he injured his knee and was unable to participate in the other three matches.
Ian Gibson and Ian Southall, in the Vic Blue team in Division 1, and Gordon Cowling, in the Vic Blue Division 2team, have travelled to Dubbo this week to participate in the National Over 70 Championships.
The next game for the Goannas Over 60s team will be this Sunday (November 24) against the South Gippsland Kookaburras at Nambrok Recreation Reserve.
The Over 50s are due to play an away game at East Ringwood on the same day.
The next Over 70s game will be ahome game against Endeavour Hills/BaysideonTuesday, December 3.
NSingh cLRickwood bT Starkey 4 ADodd not out 4 MLeslie
alongside Max Woodall (2/33), while Zach Hollis secured 2/38.
GORMANDALE are playing Willow Grove at Joe Tabuteau Reserve.
Play HQ decided to have ahissy fit before deadline.
LEAGUE officials would have been pleased to see competitive games in CGrade at the weekend.
Margins across three games were: 12 runs, two wickets, and another saw the team battingsecondwin with only threeovers remaining.
Matches at that level can often be heavily one-sided, as the stronger teams usuallyhave ahandful of ex-A Graders well into veteran stage. When judging the competitive balance of a league, it pays to look at how the lower/lowest grades are going.
BACK to the future in some respects, with second grade starting two day games. LastSaturday was the firsttimethe ‘old Central Gippy clubs’ played two dayers in B Grade since season 2001/02.
Cricket Latrobe Valley is trialling two-day games in Premier Bthis season, with asoft rollout of three matches.
Predictably, the first day saw amixed bag, withsome gamesalready into athird innings. No surprises the only team that batted all of Day 1-ExStudents.
JEERALANG-BOOLARRA bowlerJamie
Brierley had aday outlast Saturday. The medium pacer snared 8/27 across21 overs to completely decimate the Glengarry line-up in Premier B. Like he has for well over adecade, he got knicks up top before hitting stumps later in the day. Such areturnwas just rewardfor abowler I’ve alwaysfelt has been hugely underrated.
I’VE lost count.
Steve Spoljaric peeled offanother first grade ton for Bundalaguah at the weekend,making 125 red in atotal of 211 against reigning Sale-Maffra premier Yarram. Not bad in normal circumstances, yet alone for someone who is nearly 50-years-old. It is fruitless getting into adebate about the ‘best ever’, but this guy would have to be in the conversation.
‘Spolly’ has been declared as Bundalaguah’s greatest, which is saying something when the clubwas the home to Australian international Travis Birt.
WhileMikeTyson might have shown stepping into the ring in your 50s isn’t agreat idea, Spolly is proving age is certainly no barrier in cricket.
By BLAKE METCALF-HOLT
TWO years ago,GippslandPower player Ricky Mentha arrived in the Latrobe Valley from Alice Springs. He’s now one of the many 18-year-olds holdingout hope to hearhis name called out on AFL Draft night.
Beginning his time in football locally at Morwell, Mentha has played thelasttwo seasons in the Coates TalentLeague for Gippsland Power attracting serious attention from AFL clubs.
Mentha has already had something of aprofessional football experience, spending time with Melbourne Demons during their 2024 preseason, brushing shoulders with some of thegame’s best, like Max Gawn, Christian Petracca and his personal favourite Kysaiah ‘Kozzie’ Pickett.
The opportunity came about due to his involvement with the Demons’ Next Generation Academy (NGA), which featured Alice Springs in its recruitment zone. Mentha was also apart of the Marsh AFL National Academy.
“I wentdownand trained withthem (Melbourne) through the NGA because (it’s) in Alice Springs,” Mentha told the Express
“It was prettyfun though, Istayeddown with Steven Mayone week and then went back again and stayed with Kozzie for another two weeks, so yeah, it was agood experience.”
Mentha said he and Pickett regularly stay in contact, having forged astrongmateship outside football.
Mentha isn’t some surprisediamond in the rough who has burst onto the draft scene -Melbourne recruiting boss Jason Taylor first laid eyes on him during abarefoot eight-a-side match back in his home state.
He began his juniors playing for the Palmerston Football Club in the Northern Territory Football League.
Mentha played in the Marsh AFL Under 18s Championships for the Allies (a conglomerate statesideofNew South Wales, ACT, Queensland, Tasmania and the NT) this year, and was selected as one of thebest 22 players in his class for the Marsh AFL National Academy.
Mentha played two games for the star-studded Allies, whilewith the NationalAcademyside he played against VFL opponents Coburg and Footscray -more than holding his own.
Moving to Morwell to live with his dad, ironically Mentha started playing basketball for Gippsland United before even touching aSherrin around these parts.
Developing hislove for the sport in the small, remote town camp of Nyewente in the NT, the ‘Truckies’ Basketball Club is where Mentha grew his talents as aplayer.
“I was playing basketball back in Alice (Springs) and Iwas prettygood at it, mum told me to try and move down here for more opportunity,” he said.
FOOTBALL

“Then footy just ended up taking over and I was playing just heaps of footy. Iwas playing (basketball) for like three weeks and then Igot called up for footyand Gippsland Power… then Power kept me playing footy.”
Mentha had previouslyplayedstate-level basketball back home for the NT in multiple years, and didafew tournamentswithUnitedbefore football rose to the forefront.
Not knowing where or if he would play football once he had moved, Mentha was kicking around Morwell Recreation Reserve with his brother, Gaylen,and his dad,Ricky MenthaSr, whereit just so happened that, at the time, Morwell junior and then-futureCollingwood player Tew Jiathwas down the other end of the oval.
“(He) was on the other side just kicking around
as well,and he endedupcoming over to us and having achatand stuff and because my dad goes forHawks as well, he shocked dad because he was CJ’s (Changkuoth) brother,” Mentha said.
“We just became best mates from there and he sort of hit me up with Morwell, texted the under 18s coach and all that… (the club) is good as.”
Needing aplace to attend school while visiting Moe BoxingGym with his dad and hitting the mitts, some kids his age put the idea in his head about going to Lowanna College.
The Newborough-based highschoolhas been something of alocal AFL streamliner over the past decade, with current and former AFL players Sam Flanders, Bailey Humphrey, Jacob Konstanty, Leo Connolly and Sam Skinner all past students.
Funnily enough, head of the Lowanna College Sports Academy, Alan Chandler also had deep involvement with Gippsland Power.
Mentha was joined by fellow Power player and eventual draft prospectAlixzander Tauruat Lowanna this year.
By the time he donned the Power red, blue and white, Mentha instantly showed potential as a livewire forward,althoughinjuries limited his availability in his first year.
This year in his second season, Mentha managed 14 games with averages of 12.3 disposals, two marks,two tacklesand six goals -although still dealing with injury setbacks and taking on higher commitments.
He wasalsotestedbybeing switched into a variety of different positions,finding further impact as ahalf-back defender.
“I had afew games playing forward but the moving down back was areal good thing for me, more possessionsand playingindifferent positions also(which) showed thatI can playwherever,”
Mentha said.
When asked what his preferredplacement on the ground wouldbe, he declared he’s happy to play anywherethe team sees fit.
“Down back at the moment (works well), but sometimes Ireckon forward as well, Idon’t really mind though,” he said.
“Forward meansmoregoals and back there’s more running and touches.”
In one of his best games of the season in an away win againstWestern Jets, Mentha produced 22 disposals including 16 kicks and five inside 50s which truly strengthened his belief.
Mentha must have loved versing the Jets, as he had another standout game against them adding 16 disposals and twogoals along with asignificant performance against Dandenong with 20 touches and three rebound 50s.
“I reckon Ihad agood year,the game against Western Jets really boosted my confidence and the game against Dandenong gave me heaps of confidence heading into the draft,” he said.
In another finalsyear for GippslandPower, they initially win their Wildcard Round against Murray Bushrangers by seven pointsbefore going down to
DandenongStingrays by six points in the quarter final. It’s been awild two-year ride for Mentha with successand hardship,but he creditshis dad for all his support.
“Hehas been my biggest influence, getting me to games and driving me hours away,” he said. “He’s always been there, making sure Itrain and all that, he’s been real big (in getting) me to where Iam.”
Mentha won’t traveltoMarvel Stadium to attend the draft in person, but will patientlyand intently wait to hear his name called from the comfort of his home alongside family andfriends
The AFL National Draft begins its first round proceedings tonight(November 20) at 7pm with the second round taking place the following day. You can tune into the draft day coverage on Foxtel’s channel 504, FOX Footy or livestreamed via Kayo Sports.
Wednesday, November 20 &Thursday, November 21
w Ricky Mentha (Morwell)
w Goanar Ruach(Traralgon)
w Connor Scandrett(Traralgon)
w Josh Twite(Traralgon)
w William Brent (Traralgon)
w Alixzander Tauru(Warragul)
w Xavier Lindsay(Leongatha)
w Asher Eastham (Heyfield)
w Max Stobie (Maffra)
w Jesse Craven (Tooradin-Dalmore)
w Julian Callahan (Leongatha)
w Malual Aleer (Drouin)
w Noah Christy (Maffra)
w Max Donohue (Leongatha)
w Lewis Robbins (Maffra)
w Jenson Garnham (Leongatha)
w Ashton Wright (Maffra)
Expected to go: Mentha, Tauru (top 10 prospect), Xavier Lindsay (1st round prospect).
NB: TyeHourigan (Traralgon) didnot nominate. Understood to have spoken to multiple clubs as amature-age prospect.
AFLWEXPORTS BY TOM
HAYES
THE plotinthe Hawthorn-Port Adelaide rivalry thickened at the weekend,after the underdog visitors upended the Hawks’ season.
Hawthornreturned to IKONPark to host the Power in asemi-final showdown -ado or die clash.
Firmfavourites afterfinishing second on the ladder, the Hawks were hoping to right its wrongs of last week and progress to apreliminary final. Port Adelaide had other ideas, claiming the upset 7.8 (50) to 6.13 (49).
Morwell’s Casey Sherriff had eight disposalsand three tackles in the defeat, including more than 100 metres gained.
Despite winning the McClelland Trophy as thebest performing club across the AFL andAFLW, the Hawkswomen bowed out at the same point of the competition,tothe same club, in similar circumstances to the men. As acollective, Hawthornhas now lost by acombined five points in its last three outings against the Power.
Hawthorn’s AFL side features afew Gippsland products, including Morwell’s Changkuoth Jiath, as well as Warragul’s Jai Serong, and Poowong’s Jai Newcombe.
After winning the McClelland Trophy, players of the men’s andwomen’ssides won adivided share of $500,000 ($250,000 allocated to each team).
NORTH GIPPSLAND BY BLAKE METCALF-HOLT
CHURCHILL has announced its new senior coach for 2025, with Dale Furphy taking the reigns for the Cougars.
Furphy has pastassociation playing for Morwell and Mirboo North and in recent years hasbeen reserves coachand assistant seniorcoach for MDU in the Mid Gippsland Football-Netball League.
Furphy replaces 200-gamer and dual-premiership player Jordan Fenechwho has coached for the last three years.
Furphy already has connectionstothe club,ashis partner, Lynette Patten, plays netball for Churchill.
In an injury-riddled year for the Cougars, they won just six games in 2024 and missed finals for only the second time in 29 years -the first occurence since 2012.
Churchill finally nab someone to lead the senior groupafterbeing one of the few local clubs without aconfirmed senior coach at the helm for 2025.
Yarramwere the last teamtoformally announce its senior coach, unveiling former Toora coach Brett Mitchell as its new leader on Monday.
CHURCHILL Junior Football-Netball Club has also been busy, and held asuccessful market recently, attracting more than 700 people.
Stallholders and food vans gave attendees plenty of choice, in what was agreat drivetohelppromote junior sport in the area.
The club aims to make this ayearly event.
Latrobe Valley Express, Wednesday, 20 November, 2024

By TOM HAYES
MORE than 150 high school students from across the country will meet in Traralgon this weekend for the 2024 Gallipoli Youth Cup.
Taking to the courts of the Traralgon Tennis Association, teams of four to six students are set to compete in singles and doubles.
ATennisAustralia event, the Gallipoli Youth Cup, formerly known as the AustralianSchools Tennis Challenge, has been running since 1996. To become eligible for the tournament, schools must win their state championship to be considered.
Players will begin to arrive this Saturday (November 23), where they will get some practice in before the tournamentbegins the following day.
The Gallipoli YouthCup will conclude on Wednesday, November 27, with finals beginning in the evening the day prior.
Last year the tournament was held in Brisbane, and in 2022 players took to Mornington.
Traralgon Tennis Association are accustomed to hostinglarge numbers, with the AGL Loy Yang Traralgon Junior International held every January.
Compared to the junior internationaltournament, the Gallipoli Youth Cup is aclose second for biggest junior tennis tournament held in the region.
Traralgon Tennis Association Manager,Susie Grumley said the association was looking forward to welcoming players, coaches and staff.
“It’s great for the club, it’s great for the community… it brings in 250, 300 peopleinto our town who need accommodation and need to eat every
night and will be withinthe community for nearly aweek,” she said “It’s wonderfulfor the club to hold these events and it’s good for our junior players to come and watch. These players will be very good, some might even be in the ITF qualifiers.”
The arrival of the Gallipoli Youth Cup does however mean that the resurfacingofcourts at the Traralgon TennisAssociation will be put on hold momentarily.
The club decided to resurface 18 of the 26 tennis courts after Latrobe CityCouncil allocated money in the budget.
“At the moment we have five courts being done. We’re very blessed at the moment with good weather, lots of sunshine, which is what we need,” Grumleysaid.
“We are very appreciative to Latrobe City for enabling us to be able to do that and helping us get the project off the ground.”
Prior to the incoming tournament, five courts will have been completely resurfaced, two of those beingthe show courts
Resurfacing works will pause during the tournament, then the remaining 13 courts will be completed.
After resurfacing is complete, Grumley mentioned that eight of the back courts will have pickleball lines permanently added.
Pickleball at Traralgon Tennis Association will be finished soonfor the year, with the grand finals to be held this month, before more come and try sessions aheadofthe 2025 competition, beginning in February.
By LIAM DURKIN
MORWELL has flown the international bocceflag, and perhaps also inadvertently salvaged some lost Australian pride on the sporting globe.
Italian Australian Club, Morwell players Diane Penney, Tina D’Urbano and Franco Fava made up the entire Australianteam, jetting off to Turkey for the International Kemer Open and World Bocce Rafa* Championships.
Little old Morwell/Australia certainly more than held their own, beating France, Poland, Hungary and Morocco.
Victory over France was incredibly noteworthy, given the French are often rated among the best players in the world.
“It was atough competition… Italy, France, top Rafa players, but Australia, we did well and the girlsplayedvery well,” Fava said.
“We performed avery good standard, everybody was happy, even the Australian (Bocce) Federation congratulated us.”
Penney added to hergrowingcollection of medals, claiming silver for precision throw at the international open.
Penney herself can now be counted in the top players in Australasia, leaving Turkey as theAsia Oceania champion. D’Urbano wascompeting at her first internationalevent, and said it was an incredible honour to wear the green and gold.
“I was very nervous going over. My main aim was to be competitiveand veryproud as ateam that we were,” she said.
“It wasa great experience, justtosee the best players in the world playing and what we were up against, (I) learnt so much.”
Bocce’s bid for inclusion at the last Olympicswas beatenbybreakdancing, but giventhe performance of the Morwell trio and the subsequent breakdancing performance of one individual, Olympicofficials might be regretting their decision.
Australia might not havebeen taken allthat seriously in Paris,but Penney said they absolutely were in Turkey.
“I think we gained alot of respect fromother countries,” Penney told the Express
“Theysteponthe court now and show us the respect we deserve because we’ve earnt it.
“Thesetwo guys (Fava andD’Urbano) beat France, they weren’t happy about it (the French), made people sit up and take alittle bit of notice that now we can’t be underestimated.
“That’s probably the biggest thing that happened.
Once it was ‘oh we are playing Australia, this is a win’ -well not anymore.”
Morwell players will hope to again be well represented at the next global bocce event in Malaysia next month.
The Olympic dream could yet stillbealive for bocce, especially now that breakdancing has been given the boot.
While Raygun retired this month, bocce players are still going, some well into their 70s.
*Rafa is anewer form of bocce, breaking from the traditional format.
TRARALGON developer JJC Design hasbeen appointed to lead design works for the Gippsland Regional Indoor Sports Stadium.
Works will also commence at the Latrobe City Sports and Entertainment Stadium, Morwell (Falcons Park), Ted Summerton Reserve, Moe and Morwell Gun Club.
The works are part of the state government's legacy projects as atrade-off from the cancelled 2026 Commonwealth Games.
Ministerfor Community Sport Ros Spence announced that plans for the Gippsland Regional Indoor Sports Stadium will include anew change room for officials, roof works and lighting design.
Key milestones have also been reached at Falcons Park and Morwell Gun Club, with the appointment of Brand Architects as the principal design consultant for both projects.
Falcons Park will get anew pavilion with change rooms, upgraded pitches with better lighting, new player facilities and abiggercar park -which will increase capacity and allow biggercompetitions and tournaments.

Meanwhile, Morwell Gun Club is getting abrand new shooting range and security fencing, creating amuch bigger space for the sport.
Expressions of Interest are now open for aHead Contractor to deliver the Gippsland Sports and Entertainment Park and Morwell Gun Club.
Architecture Matters has been appointed as leaddesign consultant for the Ted Summerton Reserve upgrade,which will include anew pavilion

withchange rooms, upgradedaccessible change facilities, new lighting, scoreboardand sightscreen. The upgrades will be agame changer for everyone who uses the venue, includinglocal footballers, netballers and cricketers.
These new and upgraded facilities are funded through the state government’s Regional Sports Infrastructure Program, which is part of a$45 billion investment since 2014 in projects.

Doing us proud: ItalianAustralian Club bocce players Diane Penney,Franco Fava and Tina D’Urbano representedAustralia at twointernational events lastmonth

conspire, cope,copier, crisp, crop,epic,inspire, open, opine, peon, peri, person, peso,pier, pincer,pine,pion, poise,pone, pore, pose,poser,PRECISION, price,prince,prion, prise,prison, prone,prose, ripe,ripen, rope,scope,scrip, snip,snipe,sniper,spec, spice, spier,spin, spine,spire,spore












































